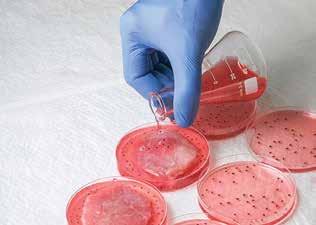

Doamne, ce păcate grele mai avem Și ce straturi de noroi ne spurcă Dacă pîn-la ceruri umbra urcă Și încearcă dreapta Tatălui Suprem?

Cît de jos au coborît oamenii, azi, Adînciți în ură și genune, Parcă fug de sfinți și rugăciune, În pustiuri reci, pierduți printre nomazi!
Fiul Tău ce-a pătimit pe-al urii val În urgia lumii necreștine, S-a jertfit ca noi să fim cu Tine, Să trăim candoarea visului astral!
Dar de-atuncea legile s-au prăfuit, Oamenii – orbiți de avuție, Doamne, astăzi, ce-ți mai cerem Ție, Cînd Pămîntul însuși e de noi uimit?
Cînd războaiele ne seceră cu moarte, Rupînd firul vieții dintr-odată, Deschizînd urgiei iar o poartă Către timpuri de-ntuneric, blestemate!
Cum să te privim ca pe-o icoană Doamne, cînd am renunțat la gîndul sfînt, Cînd gonirăm îngerii de pe pămînt, Rămînînd în suflet cu adîncă rană?
Doar să te rugăm acum, de Sărbători, Cînd natura veselă renaște, Fă o faptă bună-n zi de Paște Pentru-acești nestatornici muritori!
Dă-le, Doamne, un semn de bunătate Și spulberă-le visul lor păgîn, Fă-i ca să decline: „Ești iar stăpîn, Și, azi, sătul de-atîta libertate,
Cad în genunchi, într-o pioasă rugă, Și-mi cer iertare pentru c-am greșit. Păgîn am fost, dar, iată, am ispășit Pedeapsa de-a fi iadului o slugă!”


Și iartă-i, Doamne, ca și altă dată, Pe-acești atei care se-ntrec în rău, Căci, cruzi cum sînt, astăzi, pe Fiul Tău, De-i lași, îl vor mai răstigni o dată!
GEO CIOLCANÎn ziua Învierii lumina e de Sus, Din candele celeste picură untdelemn Pe frunțile creștine ce-așteaptă pe Isus Cu suflete unite în chip solemn...
„Christos a Înviat!“ Răsună-n cer și pe pămînt Și universu-ntreg respiră a mîntuire, Iar harul peste har se-mbracă în nou veșmînt, Căci viața este acum fărʼ de-asfințire!
Lumină din lumină e ziua cea mai sfîntă! Citește bucuria pe chipul tuturor, Transfigurată-n cuget, natura preacuvîntă: Christos a înviat, în ziua cea mai sfîntă!
Părinte EMIL NEDELEA CăRăMIzARU
Ah, Isuse plin de sînge
Pe Calvarul fariseu
Crucea asta ce Te frînge
Lasă-mă s-o port şi eu.
Precum Simon din Cirene
Vreau şi eu să Te ajut, Să-Ţi şterg lacrima din gene
Pe obraz să Te sărut.
Isus Christos nu duce
Pe umeri doar o cruce –El poartă, generos, Pămîntul păcătos.
Cîntaţi neîncetat: Christos a Înviat!
Şi în zori, cînd mă trezesc Îţi cad, Doamne, la picioare, Şi mă rog, şi mă smeresc. Eu Te văd cu ochii minţii Pe Golgota urci tăcut Şi-atunci se topesc arginţii Iudei care Te-a vîndut.
Isus Christos nu duce
Pe umeri doar o cruce –El poartă, generos, Pămîntul păcătos.
Cîntaţi neîncetat: Christos a Înviat!
Ai răbdat fără prihană N-au crezut că eşti Christos Şi, deşi eşti tot o rană, Doamne, cît eşti de frumos!
Ce-ar fi lumea fără Tine, Fără chipul Tău divin?
Pune-Ţi crucea şi pe mine Să Te odihneşti puţin… CornELIU
VADIm TUDor
F Idila dintre Ţap şi Leu F Sorin Moisescu se leagă la cap fără să-l doară
F Şobolanul Verde F Presa americană îl demască pe Alfred Moses F În anul 2020 vor exista 5 giganţi ai economiei mondiale F Limuzinele lui Halaicu
PArTEA A IV-A
F Într-un interviu acordat ziarului P.D.-F.S.N. „Azi“, Adrian Severin îi atacă (fără să-i numească) pe şeful lui, Petre Roman, dar şi pe Emil Constantinescu, Ion Diaconescu, Laszlo Tokeş, Marko Bela, Ticu Dumitrescu, Nicolae Ionescu-Galbeni şi alţi lideri ai actualei Puteri. „Faptul că sînt acum la Putere mi-a oferit accesul (?!) la o serie de date şi documente secrete (?!) şi, după ce am văzut cu ochii mei probe indiscutabile atestînd că vreo doi-trei directori ai unor cotidiene de mare tiraj sînt agenţi ai unor servicii străine, că vreo doi şefi de partid celebri, și chiar prețuiți, SÎNT Şl El AGENŢI STRăINI (ca şi el, adică – nota red. R.M.) bine finanţaţi din afară, că vreo cîţiva «mari luptători pentru drepturile omului» sînt foşti informatori ai Securităţii, că vreo cîţiva «mari combatanţi anticorupţie» au făcut mari matrapazlîcuri şi acum sînt şantajaţi de unii şi de alţii, executînd ordinele şantajiştilor fără crîcnîre, m-am simţit – paradoxal – mai liniştit“. Ia te uită cu ce se ocupă ministrul de Externe! Dar cine i-a dat lui voie să cotrobăie prin Arhivele Securităţii? De ce a încălcat Legea privind accesul la aceste documente? „Faptul că e la Putere“? Tăietorul de panglici a vorbit de multe ori în plus, dar de data asta s-a scăpat într-o chestiune foarte gravă, care zdruncină serios scaunele lui Costin Georgescu şi Cătălin Harnagea. Chiar dacă el se simte „mai liniştit“, în sensul că nu numai el a fost turnător, nu numai el fură, nu numai el e agent străin, uite că mai sînt şi alţii. Crede acest Severin că potlogăriile altora îl vor scăpa pe el de judecata populară, care se apropie cu paşi repezi? Ce va bolborosi el, cu ochii scoşi, în fața mulţimii înfuriate,
care îl va asedia în birou? Va flutura documentele pe care le-a şterpelit de la Serviciile Secrete şi le-a xeroxat, în ideea că îi va şantaja şi el pe alţii? Îl ţin brăcinarele pe acest burtos (la el s-a realizat unirea dintre buci – burtă – guşă) să ducă o asemenea luptă periculoasă? F În categoria infractorilor, îl trece Adrian Severin, cumva, şi pe colegul său de partid Radu Berceanu? Fiindcă un articol publicat în „Naţionalul“ de luni e mai mult decît acuzator: „Deşi era anchetat de Poliţie – Paul Ţîrdea, cînd a fugit din Ţară, a fost condus la Aeroport de Radu Berceanu“. A pus Bursucul Veninos lăbuța, cumva, şi pe documentele din care reiese că şeful lui suprem, Petre Roman, nu numai că a lucrat pentru 3 Servicii Secrete (Securitate, KGB, Biroul 2 francez) dar a încasat şi sume colosale de la diferite structuri ale mafiei internaţionale, cum ar fi comisionul de 1,3 milioane de dolari (bani gheață) „palmaţi“ de la agentul străin Vasile Damian (noul corespondent al TVr în Franţa!) pentru Afacerea Airbus? F Într-o declaraţie acordată presei din Mehedinţi, Vasile Văcaru afirma că Teodor Meleșcanu a fost făcut ministru de Externe ca o... răsplată adusă F.D.S.N.-ului, în campania electorală, de nevasta lui, realizatoarea de Televiziune Felicia Meleșcanu. Păi abia acum ne spui, Văcare? După ce v-a spart partidul, firește, tot ca o „răsplată“ pentru că l-ați pus în jilțul lui Nicolae Titulescu? F O nouă expresie a comportamentului dezaxat al Măscăriciului Național Prezentînd un reportaj consacrat „zilelor George Călinescu“, desfăşurate la Oneşti, ziarul „Cotidianul“ scrie: „Mircea Dinescu – care nu ştia prea bine de ce se află acolo – a contrariat sala arhiplină a Casei de Cultură nelăsînd pe nimeni să vorbească,
Stimați compatrioți, a sosit și Paștele Anului 2000. E ultimul Paște al secolului și al mileniului. Acum, în aceste zile și nopți de aprilie, se plămădesc copiii care se vor naște în Mileniul III. Avem, cu toții, o senzație ca de început de lume. Iată că viața merge înainte, biruitoare! Personal, eu nu pot sămi explic cum trăiesc miliarde de locuitori ai Planetei, de alte religii, fără efigia sfîntă a lui Isus. Dacă Isus n-ar fi Înviat, pentru noi nimic n-ar fi avut sens și totul n-ar fi fost decît o legendă frumoasă, cu final trist. Dar Mîntuitorul a Înviat și prin acest miracol ne-a făcut să înțelegem că nu-i totul pierdut, că viața are un rost, că moartea nu reprezintă sfîrșitul, iar speranța oamenilor e mai puternică decît Legea Gravitației. Ce-ar fi, oare, viața noastră fără marile sărbători creștine ale Crăciunului și Paștelui? N-ar avea nici o noimă, nici un fior, nici o înălțime morală. Cear fi, oare, existența noastră fără aura de raze a lui Isus Christos, fără exemplul jertfei Sale sublime? El n-a făcut rău la nimeni, ci numai bine. El e mielul sfînt sacrificat pe butucul Planetei. O dată, doar o dată a pus mîna pe bici și i-a alungat din Templu pe farisei, pe zarafi și pe închinătorii la idoli. A nu se uita această scenă, de către acei semeni ai noștri care exploatează prea mult spiritul blînd și tolerant al Creștinismului. Uneori, împotriva tîlharilor care ne otrăvesc fîntînile sufletului, e bine și e îndreptățit să punem mîna pe bici.
Ce fel de om era Isus? Era înalt, cam de 1,87 m., era neasemuit de frumos, era îmbrăcat în veșmintele albe ale adevărului și, mai presus de toate, era neprihănit ca porumbeii cerului. El este prototipul omului ca om, dar mai este, totodată, și Fiul lui Dumnezeu. Unii savanți români au avansat ipoteza că figura Lui apare pe Columna lui Traian, ridicată în Forul de la Roma în anul 113. Tot ce e posibil. Noi, românii, sîntem singurul Popor din lume care s-a născut creștin, și asta din cel puțin două motive: la scurtă vreme după răstignirea Mîntuitorului, prigonit de răzbunarea iudeilor, Apostolul Andrei a propovăduit
Evanghelia pe meleagurile Dobrogei, unde și astăzi o peșteră și un izvor poartă numele lui, iar legiunile romane care ne-au colonizat, pînă dincolo de anul 273, al retragerii aureliene, deveniseră, în mare parte, creștine; totodată, sîntem singura țară din lume care are, în numele ei, numele Maicii Rome. Iar limba română e singura limbă latină care păstrează, pentru lăcașul de cult, cuvîntul „biserică”, de la termenul roman „basilica”. Așa că noi am fost împărtășiți cu pîine și cu vin chiar de atunci, din vremea apostolilor și a întîilor creștini. Era vremea miracolelor. Era vremea cînd Dumnezeu umbla pe jos, printre oameni. Dar oamenii nu L-au cunoscut, și L-au hulit, și au croit strîmb societatea –iar acel păcat originar se simte și acum.
Astăzi, noi, patrioții români, trăim aidoma primilor creștini. Aparent, totul e împotriva noastră. Așa după cum Tertulian spunea că în Antichitate orice era pus pe seama creștinilor, de la revărsarea Tibrului pînă la cutremure, tot astfel patrioții români sînt făcuți răspunzători de toate nenorocirile care au lovit iubita noastră țară. A ajuns să fie o primejdie reală a recunoaște că îți iubești țara și că lupți ca ea să nu mai fie jefuită, batjocorită, ruinată. Aidoma lui Isus Christos, Poporul Român e umilit cu o cunună de spini, este scuipat, pălmuit, pus pe cruce și bătut în cuie. Aidoma lui Isus Christos, Poporul Român trăiește patimile răstignirii și strigă spre slăvile întunecate ale văzduhului: „Dumnezeul Meu, Dumnezeul Meu, pentru ce M-ai părăsit?”. Dar, tot la fel ca Mîntuitorul, Poporul Român va renaște la viață. Așa cum s-a întîmplat de fiecare dată în zbuciumata noastră Istorie. Neîndoielnic, Dumnezeu ne încearcă periodic tăria credinței, cu foamete, cu molime, cu inundații și cu alte nenorociri, pînă la izbăvirea cea mare. Eu cred cu tărie că Poporul Român este ales de Dumnezeu, iar Noul Ierusalim va prinde contur aici, pe vatra Carpaților și a Dunării. Unii susțin că așa a murmurat Papa Ioan Paul al II-lea într-o slujbă de acum cîteva săptămîni și l-ar fi auzit cei mai intimi supuși: „Speranța va veni de la București!” – ar fi șoptit Suveranul Pontif.
tăbărînd în special (chiar și fizic!) pe Dan Cristea, directorul Editurii „Cartea Românească“. Aşa vă trebuie, dacă vă puneţi mintea cu nebunul şatrei! F Dacă n-ați ştiut că bisericile au... alei (?!) – aflaţi din ziarul „Adevărul“. Cel puţin aşa reiese din reportajul publicat luni: „Sătenii l-au aşteptat de dimineaţa pe Emil Constantinescu (...) în stradă sau pe aleile bisericii“. F La orizont, se profilează un scandal grozav, provocat de mAFIA din învăţămîntul particular. E vorba de presiunile care se fac, împotriva LEGII, pentru acreditarea facultăților private, de medicină, şi pentru susținerea licenţei de Stat. Dacă pînă acum am manifestat deplină înţelegere faţă de tinerii de la facultăţile particulare, ajutîndu-i prin toate mijloacele – în ceea ce priveşte medicina, lucrurile se complică foarte mult. De ce? Fiindcă e vorba de sănătatea oamenilor, de viața şi de moartea.lor. Nu ne putem permite să lansăm în societate nişte „medici“ care nu se ştie cum s-au pregătit şi pe ce aparatură au studiat. Astăzi, „profesorii“ care i-au amăgit pe aceşti copii şi au încasat sute de miliarde de lei, în 5 ani de zile, fac presiuni infernale asupra Parlamentului, pentru a-l pune în faţa faptului împlinit şi a smulge o hotărîre privind intrarea în legalitate a unor facultăţi care, de la bun început, au fost ilegale. Cine credeţi că trage sforile? Ion Diaconescu, pentru că nevastăsa şi-a lucrat proteza la „facultatea“ de stomatologie a Universităţii Particulare Titu Maiorescu. Şi mai insistă, suspect de mult, Miron Mitrea, care o bagă la înaintare pe d-na deputat Andronescu, tot de la P.D.S.R., membră a Comisiei de învăţămînt a Camerei Deputaţilor. Stimaţi parlamentari, o să vă punem o întrebare: voi v-aţi lăsa operaţi pe creier de un „chirurg“ ieşit de pe banda rulantă a facultăţilor particulare?! Aveţi încredere? LA ÎNCHIDEREA EDIŢIEI. Generalul Pavel Abraham va trece în rezervă şi va intra în politică. Ştim şi la ce partid, dar nu spunem...
Sfîrșit
ALCIBIADE
(Text reprodus din revista „România Mare“, nr. din 26 septembrie 1997)
Iubiții mei frați și dragele mele surori din toate teritoriile locuite de români, astăzi nu vom face politică. E prea înaltă și prea curată Săptămîna Mare pentru a o întina cu politică. Toate drapelele lumii, la un loc, nu fac cît un ou de Paște. Toate siglele și stemele partidelor lumii nu prețuiesc cît o cruciuliță la pieptul unui înger de copil. Apar astăzi în fața voastră cu palmele goale, așa cum m-am născut și așa cum mă voi duce, într-o bună zi, lîngă iubiții mei părinți, fără nici un fel de avere. Sînt fericit că m-am născut creștin, român și european. Acestea sînt trei comori îngemănate și inepuizabile, ca trei izvoare nesecate, de apă vie. (...) Frați români, aveți înțelepciunea și discernămîntul de a vedea care e piatră prețioasă și care e sticlă ieftină, care e monedă de argint și care e para de tinichea. Nu vă speriați de hăituirea și prigonirea noastră. Așa e predestinat să se întîmple, iar în Istorie, noi, românii, am fost mari tocmai prin suferința noastră. Aprindeți cu evlavie o lumînare și puneți la icoane și calendare un crîmpei de mătase Tricoloră! Haideți să ne smerim frunțile și să ne rugăm pentru fericirea, propășirea și libertatea Patriei noastre. „Pînă nu vine iarna, primăvară nu se face” – spunea Tudor Vladimirescu. „Sîntem mulți, cît cucuruzul brazilor” – zicea Avram Iancu. „Sîntem români și punctum!” – glăsuia, în fine, un alt martir român, Mihai Eminescu.
Vino, Doamne Isuse, și alungă cu biciul Tău de fulgere toți nemernicii, toți hoții, toți traficanții de copii și femei, toți pedofilii, toți trădătorii de Biserică și de Neam, toți posedații de diavol! Te iubesc, Popor Român! Nu-ți pierde speranța și nu te teme. A pătimit Mesia și pentru tine și a luat păcatele tale asupra Lui. Auzim în aceste clipe cea mai divină muzică din Istorie: viscolirea clopotelor de bronz. Vedem cea mai tulburătoare priveliște: rîuri-rîuri de credincioși cu lumînările aprinse în mîini, tot venind de două milenii și mergînd, glorioși, ca niște copii ai Domnului, spre viitorime. Veniți de luați lumină! La Mulți Ani! Christos a-nviat!
CORNELIU VADIM TUDOR (28 aprilie 2000)
Felix Lope de Vega y Carpio (1562-1635), creatorul teatrului spaniol, acest „monstru al naturii“ – cum l-a numit Cervantes, datorită enormului număr al creaţiilor sale –, a fost atît de faimos în epocă încît... a intrat într-o parodie a Crezului: „Cred în Lope de Vega, creator atotputernic, poet al cerului şi al pămîntului“. Văduv după prima sa căsătorie cu Isabel de Urbina, Lope s-a însurat a doua oară, de data aceasta cu Juana de Guardo. Marea lui iubire a fost, însă, actriţa Micaela de Luján, eroina acestei poveşti de dragoste, pe care o prezentăm în adaptare după revista Historia y vida.
Căsătorie fără dragoste, dragoste fără căsătorie
Madrid, 1597. La 6 noiembrie acel an, regele Filip al II-lea suspendă reprezentaţiile dramatice în teatrele din Madrid. Cauza este moartea doňei Catalina, ducesă de Savoya, fiica suveranului. Foarte curînd, teologi şi moralişti îi cer lui Filip al II-lea ca interdicţia să fie definitivă, deoarece spectacolele comice nu pot fi tolerate din punct de vedere religios. În plus, în antracte, răsunau dansuri şi cîntece, ceea ce, după părerea multora, constituia un atac direct la bunele obiceiuri ale societăţii.
Arhiepiscopul de Granada, don Pedro de Castro, formulează o cerere în acest sens, adresată lui Filip al IIlea, care o supune Consiliului. Trei călugări şi mai mulți teologi au un cuvînt greu de spus: Garcia de Loaisa, fray Diego Lopez şi fray Gaspar de Cordova. Majestatea Sa trebuie să interzică aceste reprezentaţii în toate regatele Spaniei, spre folosul şi binele supuşilor şi al apărării credinţei catolice. Aşa „decretează“ cei trei. Urmează o dispoziţie regală a Consiliului, datată Madrid, 2 mai 1598. Interdicţia durează însă foarte puţin, căci patru luni mai tîrziu, regele moare.
Suspendarea reprezentaţiilor teatrale în Madrid umple însă paharul răbdării lui Lope de Vega, care se stabileşte la Toledo. A cunoscut acolo o actriţă, o femeie superbă, cu care va trăi una dintre cele mai depline şi profunde iubiri. Dar Lope se căsătorise de curînd cu o tînără din Madrid, Juana de Guardo, celebrînd cununia la 25 aprilie 1598, în biserica Santa Cruz. Doňa Juana era fiica lui Antonio de Guardo, bogat furnizor de carne şi peşte din Capitală, şi a Mariei de Collantes. Nu pare să se fi remarcat prin frumuseţe, după cum recunoaşte chiar scriitorul, şi avea o sănătate şubredă.
Ce să-l fi determinat atunci pe Lope să prefere căsătoria cu doňa Juana? Numai interesele materiale? N-o cunoscuse încă pe frumoasa actriţă, dar nici mult timp nu mai era pînă atunci. Probabil că s-au întîlnit în 1595. Micaela de Luján, căci acesta era numele iubitei, a eclipsat-o complet pe soţia sa legitimă, Juana de Guardo. Biograful scriitorului, Joaquin de Entrambasaguas, remarca sec: „o căsătorie fără dragoste şi o dragoste fără căsătorie“. Se poate o definiţie mai potrivită?
de locuitori, un secol mai tîrziu, prin 1646, nu depăşea 25.000 de locuitori, în anii în care Lope alege acest oraş, pare că ceva renaşte acolo. Societatea este tolerantă, inimoasă, cam mercantilă, dar cultă. Oraşul continuă să fie sediul primat al Spaniei, printr-un privilegiu acordat de Honorius III, în îndepărtatul Secol XIII.
Lope trăieşte trei momente excepţionale din viață, trei sublime iubiri, în jurul cărora creează trei nuclee din producţia sa literară: Elena Osorio (Filis), Micaela de Luján (Camila Lucinda) şi Marta de Nevares (Amarilis), iubirea lui de la bătrîneţe. Poate că dragostea pentru Micaela de Luján, care durează un deceniu, este şi cea mai pasională.

Dar cine era Micaela? Ce farmec poseda ea pentru a-l înnebuni pe Lope? Avea o frumuseţe excepţională: blondă, cu ochi albaştri, foarte diferită de alte femei pe care Lope le cunoscuse. Ca actriţă, jucase cîteva roluri în piese de teatru reprezentate la Curte, deşi era aproape analfabetă. Se spune că nu ştia nici măcar să se semneze. Aparţinea companiei lui Baltasar de Pinedo. Era căsătorită cu un obscur actor, numit Diego Diaz de Castro, care a murit în Peru, în 1603, lăsînd-o pe Micaela moştenitoare a 800 de ducaţi.
În comediile sale din această perioadă, iniţiala numelui Micaelei (M), semn al legăturii sale amoroase cu actriţa, este antepusă numelui său propriu. O întîlneşte la „Hanul cu fructe“ din Toledo. O priveşte îndelung, inima începe să-i bată cu putere, iar mintea sa făureşte imediat versuri înflăcărate. Începînd din acel moment, Lope nu mai poate trăi liniştit. Obsesia lui de a o cuceri devine bolnăvicioasă. Va încerca de mai multe ori, cu arma sa cea mai puternică: poezia. Cu ea – fără nici o îndoială –Lope este irezistibil.

Lope are 36 de ani. A trăit intens. Simte chiar o oarecare oboseală, din cauza acestei hoinăreli nebuneşti. În urmă a rămas insolita sa experienţă în cadrul Invincibilei Armade, în nefastul an 1588, de care se pare că vrea să se depărteze în vîrful picioarelor. Ce s-a ales din fericirea lui conjugală alături de prima soţie, Isabel de Urbina? Ea şi cei doi fii au murit. Despre Alba de Tormes, unde a trăit cu ea, despre curtea lui don Antonio Alvarez de Toledo Beaumont, al cincilea duce de Alba, protectorul său, i-au rămas doar amintiri.
Din 1561 (cînd Madridul devine definitiv capitala regatului, printr-o hotărîre a lui Filip al II-lea), oraşul suferise o lentă decădere, ce pare a se fi oprit. Este adevărat că Toledo capătă, ocazional, un anumit avînt în timpul celor cîţiva ani în care Curtea se instalează la Valladolid, dar imediat începe să lîncezească, de data aceasta definitiv. Dacă prin 1550 avea 60.000
Tot în această perioadă scriitorul îşi cunoaşte viitorul protector, don Pedro Fernandez Ruiz de Castro, marchiz și viitor conte de Lemos şi mecena al lui Cervantes. În 1599, Lope asistă, alături de marchiz, la petrecerile de la Valencia, cu ocazia a două nunţi: Filip al III-lea se căsătoreşte cu Margarita de Austria şi infanta Isabel Clara Eugenia cu arhiducele Alberto. Lope are sarcina să scrie cronica acestor evenimente. I-o cere tînărul marchiz, noul său protector, pentru că mama acestuia, viceregina Neapolelui, doňa Catalina de Zuniga, care n-a putut să asiste, vrea măcar o descriere a faptelor. Lope l-a cunoscut pe arhiducele Alberto la Lisabona, pe cînd acela era cardinal, prinţ al Bisericii catolice. Acum, arhiducele se căsătoreşte cu dispensă dublă, acordată de Clemente VIII; era cardinal şi rudă apropiată cu infanta. Lope observă toate acestea cu o fină ironie. Iar în săptămînile petrecute la Valencia, la serbările ocazionate de cele două căsătorii, duce o viaţă veselă, chiar libertină, cu multe aventuri amoroase. În sonetele sale, Lope îi mărturiseşte dragostea Camilei Lucinda şi uneori se plînge că ea nu-i împărtăşeşte încă sentimentele. Micaela îi rezistă, pentru moment, nu-i acceptă iubirea. Ea îi foloseşte însă scriitorului ca sursă de inspiraţie. Camila Lucinda sună bine pentru rime.

Copii, mulţi copii...
În iulie 1604 Lope închiriază o casă la Toledo, în parohia San Lorenzo, pentru Micaela şi fiii ei. În aceeaşi lună mai închiriază una, în apropiere, unde o instalează pe soţia sa legitimă, Juana de Guardo. Aşadar, la Toledo, Lope întreţine două familii. Rămîne în oraş cîţiva ani, unde trăieşte şi iubeşte. În acelaşi an, Lope şi Micaela călătoresc mult la Sevilla, unde Micaela joacă, iar el scrie comedii. La începutul anului 1605, Micaela de Luján îi naşte o fetiţă, Marcela, care este botezată ca avînd „părinţi necunoscuţi“, în ziua de 8 mai, în biserica Magdalena. Marcela va fi consolarea lui la bătrîneţe. În adolescenţă, fetiţa intră în mînăstirea Ordinului Trinităţii, cu numele de sora Marcela de San Felix, şi ajunge de mai multe ori stareţă a comunităţii. Iubeşte –ca şi tatăl ei – lumea literară. Lasă mai multe piese de teatru de inspiraţie morală, încă inedite. La sfîrşitul lunii mai 1605, Lope organizează şi conduce în Toledo o competiţie poetică, marcînd naşterea lui don Felipe (viitorul Filip al IV-lea), eveniment consumat în Valladolid, cu un an în urmă. Şi tot în Toledo asistă cu regularitate la seratele literare ale lui don Francisco de Rojas y Guzman. Într-o călătorie făcută la Madrid, îl cunoaşte pe don Luis Fernandez de Cordova y Aragon, duce de Sessa şi de Baena, apoi amiral al Neapolelui, de care îl va lega din primul moment o mare prietenie, ducele devenindu-i acel mecena pe care Lope l-a căutat întotdeauna. Anul următor, 1606, soţia sa legitimă îi dăruieşte un fiu, Carlos Felix, botezat la 28 martie acelaşi an, în biserica San Justo. Sînt anii cei mai febrili din viaţa lui Lope: în creaţie literară şi în plan sentimental. Iubirea Micaelei pare a-l fi inspirat.
Amarilis – soţia prezbiterului
Se pare că în 1607 Micaela se mută o vreme la Madrid, împreună cu fiii săi. În februarie acelaşi an, Lope asistă în Capitală la botezul unui nou fiu dăruit de Micaela de Luján, în biserica San Sebastian. Copilul primeşte acelaşi nume ca al poetului, care îl recunoaşte fără rezerve, ca fiind propriul său fiu şi al Micaelei. Naşi sînt un cunoscut scriitor, prietenul său Antonio Hurtado de Mendoza, şi actriţa Jeronima de Burgos, prietenă a Micaelei, cu care Lope va avea, nu peste mult timp, cîteva divagaţii amoroase..
Lope are cinci copii cu Micaela de Luján: trei fete şi doi băieţi. Ultimul, cel care îi poartă numele, este condamnat de destin. În plină tinereţe, se îmbarcă pentru America, cu iluzia bogăţiei – ca atîţia alţi tineri de vîrsta lui din epocă – şi, în faţa coastelor Venezuelei, vasul naufragiază. Lope va cunoaşte tristul sfîrşit al fiului său doar cu cîteva luni înainte de a muri.
Nu se ştie exact cît a durat legătura amoroasă dintre Lope şi Micaela de Luján. S-au cunoscut probabil în 1595 şi s-au iubit pînă în 1610, cînd Lope s-a instalat definitiv în Capitală şi la Curte. Acolo a cumpărat, pentru nouă mii de reali, o casă pe strada Francos, astăzi Cervantes, unde s-a stabilit cu soţia sa legitimă, doňa Juana, şi cei doi copii: Juana şi Carlos Felix. Pe Carlos Felix, care pe atunci avea cinci ani, îl menţionează frecvent şi cu multă duioşie în scrisorile pe care le adresează ducelui de Sessa, noul său protector de la Curte. Juana de Guardo a murit la 13 august 1613. Puţin mai tîrziu, Lope i-a adus la el acasă pe Marcela şi Lopillo, singurii copii care locuiau cu Micaela în acel moment. Despre ceilalţi nu se ştie nimic. Muriseră?
Odată cu revenirea definitivă la Madrid, cînd se presupune că Lope rupsese legăturile amoroase cu Micaela de Luján, scriitorul suferă acute crize religioase. El intră atunci în Ordinul Trinităţii Sfîntului Francisc. Este atît de sincer în misticismul său, încît cere hirotonisirea sacerdotală. Îi va fi servit oare aceasta pentru a-şi pune ordine în viaţă, pentru a calma o agitaţie atît de generalizată a spiritului său?
În mai 1614, la cîteva luni după moartea soţiei, va fi hirotonisit prezbiter. Şi totuşi, în viaţa sa intră o nouă femeie. Marta de Nevares, cea numită Amarilis în versurile sale de dragoste, iubirea de la bătrîneţe. Lope caută, cu o stăruinţă neobosită şi nemăsurată, cu instinct primar şi pasiune bolnăvicioasă, dragostea femeii. Nimic nu poate să-l îndepărteze, prea mult timp, de îmbrăţişarea ei. A iubi şi a se plictisi par să fie maximele sale definitorii. Oricum, Micaela de Luján a lăsat urmele cele mai adînci în sufletul scriitorului. „M AGA z IN ISTORIC”
Din cîte știm, sărbătorile creștine au un rol deosebit în viața omului, de a se odihni și a se bucura de timpul lui liber, pe care să și-l petreacă alături de familie, să ia masa împreună cu cei dragi, să iasă la plimbare sau să meargă la rude și prieteni, nu înainte de a trece și pe la biserică, să aprindă o lumînare în amintirea celor plecați la Ceruri. Așa trebuie să se întîmple, sau cel puțin așa credem noi că e normal, așa am văzut în casă la părinții și sătenii noștri... În vremurile de-acum nimic nu mai este la fel cu ceea ce am arătat noi aici... Respectul față de familie, comunitate și biserică a dispărut... Să le luăm pe rînd... După cîte vedem, violența domestică în familie a atins cote alarmante, scandalurile între soți pornind de la gelozie și alcool, de la sărăcie și alte lucruri greu de îndurat într-un cuplu... Pe de altă parte, comunitatea a devenit tot mai egoistă, contribuind chiar la crearea haosului dintre oameni, prin fățărnicie, slugărnicie, minciună, fiecare fiind pregătit parcă, prin viclenie, să-l tragă pe sfoară pe cel de lîngă el... De aici indiferența față de rugăciune și credință în Dumnezeu și Biserică. Aceasta e realitatea pe care o vedem cu ochii noștri la tot pasul, pentru că mulți dintre noi, într-un fel sau altul, prin faptele noastre contribuim la ură și dezbinare, chiar dacă zicem că sîntem creștini și dăm o lingură de colivă vreunui cerșetor din fața bisericii, în amintirea unui apropiat plecat la Ceruri... Din păcate, cohortele de cerșetori s-au înmulțit din

cauza toleranței noastre, în condițiile în care unii dintre ei sînt buni de muncă, dar preferă să trăiască în felul acesta și, pentru o pomană, se îmbrîncesc și se înjură ca la ușa cortului, fără să mai țină cont de locul în care se află... Pe noi ne îngrijorează acest fenomen și nu vom fi de acord cu încurajarea lui... Toate acestea se petrec sub ochii slujitorilor Domnului, ai jandarmilor și chiar ai polițiștilor în civil... Nu știm în ce măsură aceștia din urmă își fac treaba, întrucît, cu toate că sînt răspîndiți prin mulțime, sînt frecvente cazurile în care hoții de buzunare fură telefoane mobile, portofele, genți, chiar cînd enoriașii se roagă în fața icoanelor. Și nimeni nu face nimic, nu se intervine pentru îndepărtarea acestor cerșetori din incinta bisericii sau din jurul ei.
Apropo, cu ceva vreme în urmă, am asistat la o scenă revoltătoare, care mi-a lăsat un gust amar... În curtea unei biserici din cartierul în care locuiesc, doi băiețandri de vreo 12 ani, probabil de la blocurile învecinate, se
Evoluţia teatrelor particulare (2)
Cronicarul teatral A. Munte notează:
● ,,Să începem cu Teatrul Regina Maria, al cărui prestigiu în mișcarea noastră teatrală e definitiv consolidat. Stagiunea 1935, firește, a fost influențată de prezența tinerei asociate a Companiei, d-ra Leny Caler, care aduce ansamblului completarea cu un talent excelent pentru comedia lirică. Compania Bulandra ne-a înfățișat cu succes: Școala Contribuabililor de L. Verneuil și G. Beer; Rișca de L. Verneuil; Nădejde de H. Bernstein, cu d-ra Romanne, în reprezentație; O aventură în Zeppelin de John Alexander. O remarcabilă realizare de artă a fost Simunul de H. Lenormand, în montarea pitorească și sugestivă a d-lui Victor Ion Popa
Soții Bulandra, d-nii Maximilian și G. Storin, d-ra Leny Caler și d-nii Jules Cazaban, Finți, Ronea, M. Enescu, d-rele Beaty Fredanov, Marietta Deculescu, Maria Sandu, Elvira Petreanu ș.a. alcătuiesc un ansamblu de ample posibilități ale unor variate realizări artistice. Revenirea d-lui I. Talianu, de pe tărîmurile revistei la compania unde s-a releva, e un eveniment pe care-l subliniem cu simpatie.
Stagiunea din toamna 1935, Compania Bulandra și-a deschis-o cu Tessa, o admirabilă piesă de Jean



Giraudoux, după romanul d-nei Margaret Kennedy. A fost un mare succes de stimă și de public.

● Teatrul Comedia, care fusese lăcașul ansamblului diriguit de d-ra Maria Ventura, a adăpostit cîteva spectacole cu concursul unor talentați actori. Ion Iancovescu, Timică, V. Lăzărescu, d-ra Elvira Godeanu și d-na Sylvia Fulda au interpretat excelent piesa Tovarăși de Jacques Devat, înregistrînd un remarcabil succes. Apoi, strania poveste de dragoste din Miss Ba de R. Besier s-a realizat pe talentul copios al d-rei Aura Buzescu și pe acela al d-lui G. Vraca
Din toamna 1935, sala Comedia a fost închiriată de d. C. Tănase, care a montat cu fast și strălucire artistică opereta melodioasă Rose-Marie
● Spectacolele revuistice ale d-lui C. Tănase, scrise și puse în scenă de talentatul umorist N. Kirițescu, prin amploarea și vivacitatea lor artistică, au delecat pe bucureșteni, atît vara în grădina «Cărăbuș», cît și iarna în Sala «Eforiei». Montarea de anul trecut a operetei La Calul Bălan, cu muzica de Ralph Benatzky, luase proporții vaste și uluitoare.
În anul 1935, dl. Constantin Tănase a împlinit 30 de ani de activitate teatrală. Evenimentul a fost sărbătorit
jucau cu mingea, dîndu-și pase unul altuia, dar avînd grijă să nu lovească zidul bisericii. La un moment dat, au apărut doi jandarmi și, în frunte cu preotul, i-au luat la goană pe bieții copii care, speriați, alergau de le sfîrîiau călcîiele... Și erau fugăriți pe motiv că se aflau pe proprietatea bisericii și nu pe un teren de fotbal. Dar, ne întrebăm noi, dacă era proprietatea lăcașului de cult, cum de nu sînt văzute acolo, zilnic, grupurile formate din cerșetori, unii dintre ei destul de agresivi cu cei care nu le dau bani sau, alții, obișnuind să doarmă chiar pe lîngă zidurile grandioase ale bisericii? Nu vrem să ni se răspundă, ca să nu ne întristăm tocmai în preajma Paștelui, sărbătoare pe care o respectăm așa cum am văzut în casa părinților și a sătenilor noștri, oameni buni ca un cozonac proaspăt scos din cuptor, din vremea copilăriei noastre... Știm că ni se va reproșa că sîntem anacronici. Mai bine așa, anacronici, decît să luăm în răspăr spiritul acestor frumoase sărbători pascale, așa cum o fac, de pildă, cei care le întinează cu volumul boxelor dat la maxim, inundînd aerul cu manele și alte muzici ținînd de petreceri deocheate, în nici un caz de celebrarea Sfintelor Paști. Dar, în acord cu vremurile actuale, fiecare are dreptul să facă tot ce-i trece prin cap, nu contează că strică liniștea altora sau sfidează bunul-simț și normele de conviețuire din comunitate.
A venit Paștele! Să mulțumim Mîntuitorului, prin rugăciune și smerenie, pentru jertfa Sa unică, suprema dovadă a iubirii divine pentru noi, oamenii!
ION MACHIDON, directorul Revistei ,,Amurg sentimental”
pe scenă de reprezentanții intelectualității teatrului și publicului românesc. A fost un omagiu colectiv, binemeritat, pentru talentul de prodigios comic al acestui artist popular și unanim îndrăgit.
● Teatrul Vesel de sub direcția d-lui Sică Alexandrescu s-a consacrat genului buf. Farsele cu rachete ilare au fost cultivate pe scena teatrului Intim de la etajul «Eforiei» și pe aceea din grădina «Marconi». Au ținut îndelung afișul: Birlic, Microbii Bucureștilor și Figura de la Dorohoi
În toamna 1935, talentele d-lor G. Timică și Ionel Țăranu, și acele ale d-nelor Sylvia Fulda, Sylvia Dumitrescu și Cella Marion au venit să se adauge vechiului ansamblu în frunte cu Vasiliu-Breloc, Nora Placentini și Maria Wauvrina
● Teatrul de revistă Alhambra. Talentații revuiști N. Constantinescu și N. Vlădoianu, cu colaborarea compozitorului I. Vasilescu, ne-au oferit seri de fast și melodie, unanim apreciate. Stroie și Vasilache, simpaticii comici, au organizat spectacole de vervă, haz și muzică în genul Cabaratelui Comicilor din Viena, în sala «Majestic»”.
Desfiinţarea temporară a unor teatre
În 1935, autoritățile au luat această măsură, vizînd teatrele naționale de la Chișinău, Cernăuți și Craiova, ,,din motive de economie bugetară”, urmînd ca echipe ale teatrelor naționale din București și Iași să ofere săptămînal spectacole în cele trei orașe. ,,Populația din aceste centre are astfel prilejul să urmărească reprezentații bine puse la punct și susținute de interpreții care au creat rolurile pe scenele respective”, preciza presa vremii.
Concluzii optimiste
Autorul cronicii despre teatrul românesc în anul 1935 își încheie prezentarea într-o notă plină de încredere: ,,Se vorbește mereu de «Criza teatrului». Activitatea intensă și diversă a teatrului românesc e cea mai potrivită replică dată pesimismului celor ce vorbesc de criză. Publicul românesc e doritor de teatru și teatrul bun găsește ecou în sufletul lui”.
Sfîrșit
(Art. semnat de A. Munte, în ,,Almanahul ziarelor Adevărul și Dimineața”, 1936)
Vorbirea articulată și rîsul sînt trăsături definitorii care-l deosebesc pe om de celelalte viețuitoare ale pămîntului (Voltaire: L’homme est le seul animal qui pleure et qui rie). Totodată, vorbirea (limba vorbită și scrisă) e distinctivă pentru un popor sau altul. Limba română are o familie de cuvinte bogată, bazată pe vorbă, precum și un număr impresionant de expresii care sugerează, de fapt, comunicarea: vorbă lungă, vorbă goală, din două vorbe, din vorbă-n vorbă, vorba dulce etc. Limba pe care o vorbește, vorbirea este instrumentul de bază prin care oamenii comunică, dar acesta poate fi completat de modalități demne de luat în seamă: gestul, expresia feței, tăcerea și, mai ales, rîsul – manifestarea prin care omul se exprimă, uneori, fără voia lui. E drept, stăm sub puterea cuvintelor – cum spunea olimpian Ungherea (1937-2012) - ,,cuvinte de toate soiurile”, dar și a faptelor, și ne manifestăm diferit unul de altul, chiar și zîmbetul și rîsul au semnificații infinite. Dar există atîta sinceritate într-un simplu rîs. E rîsul neprefăcut care definește, de fapt, ființa umană (din paginile romanului Agent secret, Ed. Junimea, Iași, 1985).
Aria de referință a rîsului este vastă, ideile curg unele din altele pentru că rîsul, specific omului, îl depășește, uneori, chiar pe om. Vom așterne și noi pe hîrtie (că sînt ,,expirată”, n-am calculator) aspectele/ ideile care ne curg prin minte – acumulate și din documentare – idei, ,,vorbire” în scris care ne apropie oarecum de Cel care ne-a născut după asemănarea Lui. La acestea adaug un aspect definitoriu: m-am născut în acest neam avînd rădăcini ancestrale pe aceste meleaguri, limba română a crescut în ființa mea odată cu mine. Și acumulările continue, de o viață (lungă!), în sfera umanisticii, lucrările scrise, creația literară, studierea în adîncime și în extindere a epigramei și a aforismului mi-au demonstrat că în nici o limbă și la nici un alt popor nu există expresia rîsu’-plînsu’ care exprimă unitatea indestructibilă a acestor două manifestări în structura, în trăirea, în exteriorizarea omului. Și, să nu uităm: rîsul intens e amestecat cu lacrimi. Plînsul dureros te adîncește și mai tare în plîns, iar rîsul disperat te adîncește în rîsul cu lacrimi. Așa-s românii, la necaz sau la extaz, Ori plîng amar, cu bucurie, Ori rîd cu lacrimi pe obraz.
Ion M. Ruse
Marele epigramist N. Ghițescu (1919-2002) aduce multă lumină aceleiași idei:
Cînd necazuri vin grămadă Biet românul face haz Și-și ascunde sub broboadă Lacrima de pe obraz
Marii pictori susțin că mișcările și cutele feței care exprimă plînsul sînt aceleași cu cele care exprimă rîsul.
În mulțumirea către Dumnezeu intră, nu de puține ori, rîsul, care se înrudește cu lumina, cea care se opune întunericului. Dan Lupescu sugerează acest proces specific neamului nostru: ,,Trimis al Domnului pe pămînt, țăranul român – Fiu al Luminii – a avut resursele lăuntrice, echilibrul și scăpărarea minții, înțelepciunea senină și rafinamentul armonic de a hălădui – niciodată încrîncenat, ci cu smerenie melodică, pe Via Dolorosa/ Golgota de la cuvîntul/ Logos la filozofie, de la credință și iubire, spirit și spiritualitate pînă la arta de a-I mulțumi statornic lui Dumnezeu...” (Vol. Timpul sacru din icoane, Ed. Alma, Craiova, 2013, p.8). În majoritatea cazurilor, rîsul exprimă veselia, bucuria, și atunci...

florile cerului se scutură
În inimile noastre păcătoase /.../ Învierea a busuioc miroase, De păcate, de patimi ne spală (p. 38).
Rîsul se înrudește cu cîntecul privighetorii și al ciocîrliei, cîntecul care învinge toamna și aduce primăvara. El exprimă, deopotrivă, sufletul și gîndul. Rîsul, surîsul, zîmbetul nasc umorul, ironia, chiar sarcasmul, atît de specifice spiritualității românești. Nici Dumnezeu nu e străin de aceste manifestări. În Ziarul LUMINA (11 mai 2021, p. 11), Părintele Adrian Agachi aduce argumente surprinzătoare care susțin că și ,,Cel ce locuiește în Ceruri va rîde de dînșii [de păcătoși] și Domnul îi va batjocori pe ei (Psalmi 2,4). Dumnezeu poartă adesea pecetea unei seriozități marcante sau chiar a unei tendințe de înfricoșare. Rîsul lui Dumnezeu este un element care nu ne trece deloc prin minte atunci cînd ne gîndim la El. Și totuși, chiar dacă nu putem cuprinde cu mintea un rîs sau o ironie din partea lui Dumnezeu, Scriptura le mărturisește franc și ne îndeamnă să trecem dincolo de o gîndire îngustă cu privire la manifestările Lui”.
Îndrăznesc să afirm că reprezentanți de seamă ai umorului românesc – mă refer, în primul rînd, la epigramiști – au intuit această sacră legătură a rîsului cu Dumnezeu și cu cele sfinte. Vom aduce, în cuprinsul acestui studiu, suficient de multe dovezi; pentru moment, vom face cunoscut următorul catren, nu lipsit de nota de bășcălie specifică românului: Dumnezeu ce mai clocește?
Printr-o simplă bagatelă, Moșul rîde și-i stropește
Pe acei ce n-au umbrelă!
C-tin Cristian
Un lucru important este să ne păstrăm zîmbetul pe buze, chiar și atunci cînd trecem prin greutăți, altfel vom ucide copilul din noi, scrie Părintele Adrian Agachi. De fapt, dacă stăm să ne gîndim, după țipătul pruncului intrat în viață, ca un țipăt al victoriei, rîsul este cel care premerge vorbirea: el rîde și în somn, cînd stă de vorbă cu îngerii, și cînd gîngurește, numai după aceea pronunță primul cuvînt – de obicei cuvîntul mamă, emis prin împreunarea buzelor. Și Părintele Adrian se întreabă: ,,Cum ne mai putem numi copiii lui Dumnezeu dacă am uitat să rîdem?”. În fața necazurilor să ne oferim un moment de umor. ,,Să ne amintim de exemplul Sfîntului Antonie cel mare, care glumea din cînd în cînd cu frații de mănăstire pentru a-i face să înțeleagă că, e drept, seriozitatea e bună pentru suflet, dar rîsul curat este un veritabil medicament dacă este luat cu măsură”. Să nu ne surprindă faptul că și epigramiștii îi atenționează pe cei care rîd fără măsură.
I-e dat să rîdă omului
Cum frunza-i dată pomului
Că rîsu-n viață-și are rostul, Dar nu și-atunci cînd rîzi ca prostul!
Elis R.
,,Reacția la mînie prin tăcere sau printr-o glumă dezarmează pe cel pornit pe harță. Rîsul, zice Sfîntul Grigore Teologul, este cea mai puternică armă în
lupta cu mînia /.../ Chiar și un ascet foarte serios și respectabil ca Sfîntul Ioan Scărarul a îndrăznit să scrie următoarele cuvinte, care ar trebui învățate pe de rost de toți cei care osîndesc orice formă de veselie: Nu are, o, prieteni, Dumnezeu nevoie și nici nu voiește ca omul să plîngă din durerea inimii, ci, mai degrabă să se veselească din iubire față de El, întru rîsul sufletului”.
Rîsul se opune batjocurii - ,,termen aspru, direct, care lovește ca un glonț în inima noastră”. Dumnezeu nu ne va batjocori așa cum o fac oamenii, dar ne va trata cu o fină ironie cînd trăim în mîndrie – subliniază Părintele Adrian –, combate, deci, trufia care presupune aroganță și dispreț, și ne va face să ne vedem lungul nasului și să gustăm un strop din paharul umilinței. Înțelegem că rîsul produce și răni, mai dureroase decît cele cu sînge curgînd. Astfel, epigramistul Paul Curiman se adresează denigratorilor:
De vrei pe loc să-i beștelești
Cînd inima în tine plînge, Tu poți cu rîsul să-i rănești Și n-o să curgă pic de sînge
Dar rîsul se produce nu numai la oamenii cumsecade, există și rîsul prefăcut, cu hohote batjocoritoare, pentru umilirea cuiva.
Totuși, între rîs și bucurie există o strînsă legătură, dar (există totdeauna un dar, cum spun francezii) nu orice bucurie te face să rîzi: marile satisfacții sînt serioase și nu orice rîs exprimă bucuria. De fapt, rîsul ca manifestare și trăire are o arie mai largă decît bucuria.
Voltaire scria: Bucuria e efemeră și rîsul înșelător. Da, înșelător, pentru că și rîsul te poate face de rîs: Faci o glumă nefirească, Apoi încă două glume, Una însă e prostească Și-ai ajuns de rîs în lume
Ionel Jecu
În plus, dacă întreci măsura și rîzi întruna, ajungi să fii tratat la spital.
Rîsul pricinuiește o observație ingenioasă: cum azi, românii sînt copleșiți de taxe și impozite, epigrama se întreabă:
Bugetul țării e util, Dar fiscul prea de gît ne-a strîns!
Pe cînd și dări pe rîs și plîns Sau chiar pe zîmbet de copil?
Elis R.
Să ne-ncredem, oare, în considerația optimistă a epigramistei Elena Leach? Pe rîs impozit nu se poate pune! Dar pe plîns? – ne întrebăm noi.
Rîsul, chiar mai potolit, e produs și de ironie, iar autoironia este, cu adevărat, binefăcătoare, momentul potrivit – ne lămurește Părintele Adrian Agachi – în care Dumnezeu ne descoperă adevărul despre noi înșine. ,,De fiecare dată cînd te autoironizezi, mai urci o treaptă către vindecarea ta sufletească, dar cînd ironizezi pe altul, mai ales cînd ai aceleași păcate, comiți o mare greșeală”. Înțelegem că, indirect, e subliniată importanța rîsului, chiar dacă poate fi numit autorîs. Deci, rîsul (cu măsură!) e benefic. Regretatul scriitor Romulus Vulpescu spunea că numai constipații n-au umor și nu rîd, iar Alexandru Paleologu e și mai dur: ,,Există de cînd lumea o categorie de oropsitori ai vieții, fanatici care interzic fericirea, osîndesc plăcerea, detestă rîsul și persecută, astfel, inteligența. Ei obțin totdeauna stima imbecililor și izbutesc recurent să instaureze o formă sau alta de teroare” (citat preluat din același număr al Ziarului LUMINA).
(va urma) Dr. ELIS RÂPEANU
EL ne-a dat LUMINA, dar noi nu o vedem, de întuneric ne împiedicăm. Aprindem Ruguri cu aură de durere, iar flacăra lor în noi răspîndește cărări în vid, pe care e atît de greu să simți dacă L-ai trădat sau nu pe Dumnezeu. Mereu declarăm război Luminii din noi, în amintirea unui timp uitat, cînd o flacără fără contur ne-a trădat.
O, Doamne Sfinte, transformă Lumina în cuvinte, și cînd rostim un cuvînt, Lumina să strălucească pe Pămînt. Inima și conștiința noastră – frînturi de soare – să fie pentru Lumină ALTARE, în infinitul tablou ,,pictat” de CREATOR. Aceasta e Poarta ce deschide întregul Univers, în care Planeta Albastră, cu OM și POM roditor, frumuseți fără cuvinte, făurite în taine sfinte, sînt imagini imposibil de redat, pentru că totul a fost creat de Marele Împărat. Arta Sa este iubirea pe care o are pentru fiecare, iar în destin stă scris tot Cerul promis prin CRUCEA RĂSTIGNIRII, miracol al nemuririi. Celebrii Van Gogh, Rembrand, Gaugain, Leonardo Da Vinci, Rafael L-au imitat pe EL. Ei însă n-au creat, ci doar au copiat din Natură frumusețea pură.

Viața noastră e ca un copac. Din rădăcini cresc tulpini ce se ramifică, alcătuind coroana frunzelor ce cad Toamna. Adevărul și Viața sînt Cerul deschis de Copacul despuiat ce și-a jertfit rînd pe rînd frunzele în vînt, în calea spre Adevăr întrupată în El, Cel fără de vină, ca noi să devenim Lumină.
De la naștere pînă la moarte, Ispita-i tot timpul aproape. Fiind risipită în natură, ispita adună iubire și ură. Multiplii ei ochi de magnet te atrag discret și, parcă hipnotizat, îi faci mereu pe plac. Ispita a-nceput prin mărul din care a mușcat prima femeie și primul bărbat, din primul veac. Apoi, în cîntec de privighetori, Fluturii, atrași de miraculosul polen, zburînd din floare în floare, le-au transformat în grădini roditoare. Frumusețea din
Pregãtiri pascale în Bucurestii anilor ’30 ,
În București, Paștele era, ca și acum, zumzet, agitație, nervi, goană nebună, aproape inexplicabilă. Fiecare pleca de acasă cu treburi, tarabele precupeților dădeau pe răscoale, se descărcau miei nenumărați din camionete, ceapa verde se întîlnea cu pătrunjelul, ridichiile cu mărarul, salata cu orișicine. Halele, ansamblu de trei construcții, cea mai mare dintre ele inspirată de halele pariziene, deveneau centrul pulsatil al urbei, care dădea viață tuturor străzilor pe care lumea curgea ca prin artere. Soții încercau timid să se împotrivească nebuniei, dar cu slabe șanse de izbîndă. Treziți cu noaptea în cap, erau nevoiți să urmeze pasul hotărît și gata de luptă al soției. Pentru că, înainte de Paști, cumpărăturile deveneau o luptă pe care doar strategii desăvîrșiți o puteau cîștiga: „Nevasta m-a sculat cu noaptea-n cap. Mă avertizase, de-altfel, că mergem la piaţă, ca să ne îngrijim cu «diverse», în vederea sărbătorilor. Toate protestele mele au fost inutile.
– Ce să caut eu în piaţă, la zarzavagii şi la măcelari, la băcani şi la celelalte specimene comerciale? Vrei să mă rîdă mahalaua şi cunoscuţii?
– Nu mă interesează! Tu eşti bărbat, ştii să te tocmeşti mai bine şi pe urmă, singură nu mă duc nici în ruptul capului. Dacă vrei bine; dacă nu, facem Paştele la restaurant!
Cîţi din dvs., burghezi liniştiţi, cu ocupaţii stabile şi cu certificate de căsătorie legitimă dela oficiul stării civile, puşi în situaţia mea, aţi fi preferat ultima alternativă? Şi tot cum aţi fi făcut şi dvs., am pornit-o, la orele şapte şi jumătate, spre Halele Centrale”.
În mod obișnuit, aprovizionarea caselor burgheze era făcută de servitoare. Numai că stăpîna avea rareori încredere în ele la asemenea ocazii speciale. „Dacă se întoarce cu carne tare?”, „Dacă ia ouă clocite?”, dacă, dacă, dacă. Așa că stăpîna casei îl trăgea după ea pe stăpîn în această operațiune dificilă. Miza era enormă: masa trebuia să fie perfectă, iar musafirii încîntați.
Cum descindeai în Piața de legume și fructe BibescuVodă, aflată lîngă hale, vînzătorii săreau cu gura pe tine. Asaltul începea, așadar, chiar de la baza cetății halelor: „Imediat ce-am trecut pe sub portalul dela intrare, am fost întîmpinaţi de negustori, cu cele mai variate exclamaţii şi cu cele mai îmbietoare invitaţii: – Sparanghel proaspăt! Chiar acum mi l-a adus dela grădină!

– Ceva salate, cuconiţă, de cînd sînteţi n-aţi mîncat aşa ceva!
– La mine nu există nici din alea de var şi nici clocitură! – ne spune un negustor, pe a cărui firmă scrie: «Aci se vinde ouă proaspete!»”.
În 1933, cînd își scrie articolul autorul „Realității ilustrate”, tumultul pieței era văduvit de criza economică. Lume mai puțină, prețuri mai mari. Chiar și produsele autohtone deveniseră exotice: „Nu ştiu cum m-au scuturat de cîteva sute de lei, pentru te miri ce: salate, fructe, zarzavaturi, ouă. Ceapa verde costă o avere. Sparanghelul e inaccesibil pentru o pungă mai modestă. Portocalele parcă se scumpesc din oră-n oră, iar kilogramul de mere naţionale, autohtone, costă mai mult decît două kilograme de carne de vacă, la un loc. Şi te întrebi, mirat, dacă nu sînt aduse cumva din Haiti sau din Sumatra. Dar negustorul te scoate din încurcătură: – Mere creţeşti, boerule, mere de Nehoiaşi. N-au pereche!
Dai şi iei. Cînd nevasta vrea mere creţeşti, s-a terminat. Încearcă să-i obiectezi că-ţi face cu banii aceştia o tortă”.
Înainte de marea criză, împrejurimile se molipseau și ele de agitația halelor și tot centrul vechi era o sărbătoare. Strada Bazaca, de pildă, astăzi dispărută, era plină de comercianți și de cumpărători. Acolo se vindeau mai ales pînzeturi, cu sutele, atîrnînd în fața prăvăliilor și fluturînd în bătaia vîntului de primăvară: „Bazaca e aproape pustie. Acolo unde altădată, în ajunul Paştilor, se făcea un dever extraordinar, basmalele şi diferitele
natură este ispită pură, ea pare o floare cu parfum și culoare. Dar polenul căzut ca un jar în potire toate florile îl îndură, în dulci suferințe peste măsură. Gîndurile – tulpini de lumină – răsar în cuvînt de împăcare în credința străbună pentru o lume mai bună. Cînd cugetul tău stă față-n față cu Dumnezeu, la spovadă, eliberat de păcat, îl simți cum zboară ascuns într-un cuvînt: LUMINA din Duhul Sfînt (versuri inspirate din Sfînta Liturghie).
,,Vă cheamă Domnul slavei la Lumină, Vă cheamă mucenicii-n veșnicii, Fortificați biserica creștină
Cu pietre vii zidite-n temelii.
Să crească-n inimile voastre
Un om născut din nou armonios, Pe sufletele voastre să se-mplînte
Pecetea Domnului Isus Christos
Un clopot tainic miezul nopții bate
Și Isus coboară pe pămînt, Din piepturile noastre-nsîngerate Răsună Imnul Învierii sfînt.
Veniți creștini, luați lumină
Cu sufletul smerit, purificat, Veniți flămînzi, gustați din cină, E nunta Fiului de Împărat”. (Valeriu Gafencu)
LILIAnA TETELEAconfecţiuni din stambă, atîrnă în bătaia vîntului, ca prapurile de moarte”. Deși cumpărătorii erau mai rari, prețurile mai mari, iar buzunarele mai ușoare, autorul articolului din 1933 presimțea că farmaciile aveau săși facă din nou stocuri imense de medicamente… Căci pofta de mîncare a românului era la fel de proverbială ca în vremurile noastre, cînd mulți compatrioți ajung la urgențe din pricina exceselor: „Şi totuşi, parcămi spune ceva că şi după sărbătorile Paştilor din anul acesta, farmaciile vor desface din nou, stocuri imense de purgative…”. Nu doar farmaciile se umpleau de purgative, ci și paginile revistelor, unde erau promovate agresiv în zeci de reclame.
Dincolo de modernitatea din centru, Bucureștii păstrau încă un suflet rural în mahalalele și comunele din apropiere. De asemenea, oameni din toate regiunile veneau să-și încerce norocul în capitală și aduceau cu ei obiceiuri care mai de care mai neobișnuite. Astfel, lumea satului izbucnea deseori imediat după blocurile Art Deco de 10 sau 12 etaje. Publicațiile vremii consemnau aceste datini, simțind parcă cum vremea lor se apropia de sfîrșit. Așa aflăm că-n Joia mare fetele torceau cînepă prin curți, de teama Joimăriței, o femeie monstruoasă, lungă ca o prăjină, care umbla cu părul despletit și cu un snop de cînepă în cap. Simțea de departe caierele netoarse și fetele nu aveau scăpare. În timpuri mai vechi, oamenii se închideau în case și ungeau cadrul ușii cu usturoi, dar Joimărița tot venea la fereastră. Tot joia, de data aceasta la biserică, la denie, femeile înnodau de douăsprezece ori un „căpețel” de sfoară, la cele douăsprezece îngenuncheri în fața fiecărei evanghelii. Sfoara cu noduri era prinsă apoi la brîul copiilor bolnavi de friguri sau al femeilor care nășteau greu, într-un amestec de religie și superstiție. Vinerea, numită și vinerea seacă, nu se punea nici o sămînță în pămînt, fiind ziua în care a fost răstignit Isus. Copiii porneau în stoluri peste cîmpii, ca să adune flori din care făceau buchete pe care le duceau la biserică.
Prins, în zbaterile sale, între modernitate și tradiție, Bucureștiul era așadar deopotrivă derutant și cuceritor prin contrastele sale șocante. Pornind de la comunele din jur, trecînd prin mahalale și ajungînd la block-hausuri, Paștele era un amalgam de superstiții, obiceiuri religioase, ouă încondeiate și iepurași, împrumutați pe filieră americană. Acest fapt e vizibil și în presa vremii, unde paginile despre practicile religioase, tradiții strămoșești și vedete de Hollywood fotografiate seducător alături de iepuri albi se juxtapun fără să se anuleze.
Dezbaterile din cadrul comitetelor şi comisiilor, al audienţelor şi întrevederilor reprezentau numai un aspect, cel oficial, al congresului. Un al doilea aspect, neoficial, dar nu mai puţin important, este cel intrat în istorie ornat de epitetul „dansant“. Ambele faţete îmbinau diplomaţia de cabinet cu diplomaţia galantă. Chestiuni care nu se rezolvau în şedinţele de lucru căpătau soluţii în culise, după cum probleme considerate definitivate în congresul oficial erau date peste cap de congresul dansant. Metternich nu era mai puţin ocupat în calitatea sa de maestru de ceremonii al împăratului Austriei decît în cea de preşedinte al congresului. Pe culoare se şuşotea chiar că ministrul de externe austriac îşi dedica trei sferturi din zi transformării unui congres european într-un fel de bîlci monden. Capetele încoronate, cei 216 şefi de delegaţii şi 500 de diplomaţi străini, dar mai ales numeroasele doamne venite din toate colţurile Europei nu puteau fi lăsate pradă plictiselii. De aceea, se organiza zilnic o vînătoare, un carusel, un spectacol de gală, un bal, o recepţie etc. Au rămas vestite balurile date de Franz I şi Alexandru I sau reuniunile din fiecare luni de la doamna Metternich. Diverse saloane grupau pe amicii uneia sau alteia dintre ţările participante la congres. La contesa Edmond de Perigord se întîlneau amicii Franţei. La Lady Emily Castlereagh erau susţinute interesele Angliei. La prinţesa von Thurn und Taxis se acţiona în favoarea Prusiei. O serie de babe (contesele de Schoenburg, Hoyos, Cobenzl ş.a.) seară de seară ţeseau intrigi pe seama tuturor la văduva contelui Pergen-Grosschlagg. La o recepţie la Hofburg, la un bal la Augarten, la un dineu la Belvedere, toţi cei cărora, la congresul oficial, le erau trîntite uşile în nas, foloseau prilejul pentru a se văita, a solicita o concesie, a se face cel puţin remarcaţi. În astfel de ocazii erau abordaţi cu sfială suveranii, şefii delegaţiilor şi consilierii marilor puteri, erau asaltate cu tot felul de intervenţii cele „două sibile“ – ducesa de Sagan (focoasa amică a lui Metternich) şi cneaghina Caterina Bagrction (îmbufnata protejată a ţarului), lulia Zichy (slăbiciunea posacului rege al Prusiei, pe seama căruia circula butada: „După Saxonia, cel mai mult o iubeşte pe Iulia“), prinţesa Esterhazy (în saloanele căreia domneau graţia şi urbanitatea) sau chiar o contesă Wierford (care n-a strălucit prin altceva decît prin cîştigarea unui concurs de rapiditate în schimbarea toaletei – un minut şi douăzeci şi cinci de secunde, faţă de un suveran care n-a reuşit operaţia decît într-un minut şi cincizeci de secunde!). Memorialistica epocii şi istoriografia mai nouă arată că bîrfeala nu interesa mai puţin ca problemele serioase. Cu cine a dansat sau la cine s-a uitat ţarul? Cine era femeia travestită cu care a conversat atît de mult regele Wurtembergului? O scrisoare de atunci creionează astfel cea de a doua faţă a congresului: „Împăraţii dansează, Metternich dansează, Castlereagh dansează, toată lumea dansează. Numai prinţul Talleyrand nu dansează, dar joacă whist“. Şirul interminabil de serbări galante în cinstea „scumpilor oaspeţi“ costa zilnic 220.000 de florini. La Viena se şi vorbea că „împăratul Rusiei iubeşte, regele Danemarcei chefuieşte, regele Wurtembergului se hrăneşte, regele Prusiei se gîndeşte, în vreme ce împăratul Austriei plăteşte“.

congresului: funeraliile unui feldmareşal. Cred ca va fi foarte impunător“.
Lovitura de trăsnet
Dar, deşi mai mult dansa decît înainta, în februarie 1815 congresul se apropia de sfîrşit. Se aştepta convocarea tuturor plenipotenţiarilor pentru ceremonia finală, cînd, la un bal dintre cele mai selecte, o veste cu adevărat senzaţională a produs efectul unei bombe: Napoleon părăsise insula Elba şi debarcase în Franţa. „Părea că miile de lumînări s-au stins toate deodată“, relata un martor ocular. „Vestea s-a propagat cu iuţeala unei scîntei electrice. Valsul s-a întrerupt, orchestra continua să cînte în zadar melodia începută... Regele Prusiei a făcut un semn ducelui de Wellington şi amîndoi au părăsit salonul. Alexandru I şi Franz I i-au urmat imediat... Cea mai mare parte a invitaţilor s-a făcut nevăzută“.
Decizia lui Napoleon de a părăsi insula Elba nu fusese un act spontan. O gîndise multă vreme, începînd din decembrie 1814. Pe la 19 februarie i se destăinuise generalului Drouot: „Drouot, sînt regretat şi chemat de întreaga Franţă. Peste puţin timp, voi părăsi insula spre a mă supune voinţei naţiunii“. La 1 martie, însoţit doar de 1.200 de oameni, debarca în golful Juan. La 7 martie, la Grenoble, un grup de locuitori prezentau resturile porţii Bonne: „Pentru că n-am avut cheia oraşului, v-am adus poarta cu totul“. Napoleon, la Sf. Elena, va spune: „Pînă la Grenoble, eram un aventurier; la Grenoble, eram prinţ“. Peste şase zile, la Lyon, acţiona ca împărat. Aici a emis cele 11 decrete din 13 martie, prin care detrona pe Bourboni, înlocuia drapelul şi cocarda albă prin steagul tricolor şi cocarda naţională, declara dizolvate Camera Pairilor şi Camera Deputaţilor, care funcţionau pe baza Constituţiei date de regele Ludovic, abolea titlurile nobiliare feudale, revoca numirile făcute în timpul lipsei sale din Franţa şi convoca la Paris, de urgenţă, colegiile electorale ale imperiului. La 19 martie, Ludovic al XVIII-lea fugea din Paris. A doua zi, la ora nouă seara, Napoleon îşi făcea reintrarea în Tuileries.
astă noapte Parisul; nu se cunoaşte încă în ce direcţie s-a îndreptat. Capitala respiră astăzi o atmosferă de linişte şi bucurie. Bulevardele sînt pline de o mare mulţime, nerăbdătoare să vadă sosirea armatei şi a eroului care i-a fost redat“. Acest de-al doilea citat reflecta realitatea. Peste tot împăratului i se făcuse o primire dintre cele mai călduroase. Relatînd intrarea în Lyon, FI. de Chaboulon scria: „Toate podurile, cheiurile şi străzile erau tixite de lume: bărbaţi, bătrîni, femei, copii... Lumea se strecura pînă sub caii suitei ca să-l vadă, să-l audă, să-l privească mai deaproape, să se atingă de hainele lui. Era o nebunie“. La plecarea din oraş, mulţimea I-a condus pînă departe, dincolo de bariere. La Villefranche, orăşel ce număra atunci doar 4.000 de locuitori, veniseră în ziua trecerii lui Napoleon vreo 60.000 de ţărani. Scriitorul regalist Fabry povesteşte că doi dintre aceşti ţărani au cumpărat de la hangiu oasele rămase de la puiul pe care-l mîncase împăratul, pentru a le păstra. Comentînd primirea ce i s-a făcut lui Napoleon la Paris, E. Tarle spune: „Nici după victoriile sale cele mai măreţe, după campaniile cele maî strălucite, după cuceririle cele mai mari şi mai bogate, Napoleon nu fusese primit în Paris ca în seara de 20 martie 1815“.
Punînd din nou piciorul pe pămîntul Franţei şi referindu-se la Viena, Napoleon a declarat: „Congresul s-a dizolvat!“. Dar nu era aşa. Puterile europene erau hotârîte să nu-i dea nici un fel de răgaz pentru a-şi mobiliza şi reorganiza forţele. La 13 martie, în timp ce prin decretele de la Lyon se restabilea oficial imperiul francez, comitetul celor opt de la Viena lansa declaraţia care îl punea pe Napoleon „în afara relaţiilor civile şi sociale“ şi, considerîndu-l inamic şi turburător al liniştii în lume, îl supunea vindictei publice. Lucrurilor nu li s-a putut imprima alt curs nici cînd împăratul francez i-a expediat ţarului un exemplar al tratatului încheiat la 3 ianuarie între Austria, Franţa şi Anglia, exemplar pe care-l găsise în biroul regelui fugar. Văzînd documentul, ţarul l-a chemat pe Metternich şi i l-a pus în faţă. Baronul prusac Stein, martor al scenei, arată că ministrul austriac a studiat atent fiecare filă, fără ca măcar să i se clintească un muşchi al feţei. În clipa în care se pregătea să vorbească, Alexandru l-a oprit: „Metternich, atîta timp cît vom mai trăi, să nu facem niciodată caz de această afacere. Avem în faţă o altă problemă. Napoleon s-a reîntors şi alianţa noastră este de acum înainte mai fermă ca niciodată“. Şi încheindu-şi fraza a aruncat tratatul în flăcările căminului. Marile puteri hotărîseră irevocabil reluarea operaţiilor militare împotriva Franţei; în situaţia creată, mijloacele de care dispunea Napoleon nu erau pe măsura pericolului. „Ar fi trebuit – constată el mai tîrziu – să iau de la capăt revoluţia pentru a folosi toate posibilităţile pe care ea le creează... Fără aceasta nu mai puteam salva Franţa“. Dar ca exponent al poziţiei marii burghezii, el nu a făcut şi nici nu putea face un asemenea pas.
Prelungirea peste orice măsură a congresului secătuia nu numai bugetul curţii habsburgice, ci epuiza şi inventivitatea în materie de distracţii. Cu sarcasmu-i cunoscut, octogenarul prinţ de Ligne – singurul general de rangul sau, după propriile-i cuvinte, care nu fusese bătut niciodată de Napoleon (comandase pentru ultima oară în 1789, la asediul Belgradului) – murmura față de cei care-i vegheau ultimele pîlpîiri ale vieţii: „Am pus la cale un nou amuzament pentru membrii
Reîntoarcerea lui Napoleon în Franţa a produs o puternică derută şi turbare în tabăra regalistă. La 13 martie, curtea Bourbonilor îl declara trădător şi rebel, punînd pe capul lui o răsplată de 100.000 de ludovici de aur. Însăşi ştirea debarcării, primită la 5 martie, a fost ţinută secretă, încît presa n-a putut relata evenimentul decît la 7 martie. Atitudinea presei este oglindită şi de titlurile folosite: „Monstrul corsican a debarcat în golful Juan“; „Căpcăunul înaintează spre Grasse“; „Uzurpatorul a intrat în Grenoble“; „Bonaparte a ocupat Lyonul“; „Napoleon se apropie de Fontainebleau“; „Majestatea sa Imperială este aşteptată astăzi în Parisul său credincios“. lată ce scria, la 20 martie, „Journal des Debats“: „Care va fi rezultatul acţiunii oarbe a lui Bonaparte dacă Franţa se va lăsa invadată, cucerită şi aruncată din nou sub jug de un aventurier din Corsica, însoţit de o mînă de briganzi străini şi de cîteva bande de dezertori?“. La 21 martie, în acelaşi ziar se putea citi: „Familia Bourbonilor a părăsit
În timp ce preparativele pentru noul război erau în toi, lucrările congresului se precipitau. La 8 iunie, în cadrul unei pompoase solemnităţi care reunea, în sfîrşit, pe toţi plenipotenţiarii prezenţi, Actul final al Congresului de la Viena era semnat. Se trasa o nouă hartă a Europei, dar nu se dădea rezolvarea principalelor ei probleme. Cu toate că marile puteri au continuat să fie măcinate de contradicţii, Congresul de la Viena şi crearea Sfintei Alianţe au asigurat, pentru deceniile imediat următoare, o relativă stabilitate a sistemului metternichian, constituind o „cartă“ a apărării rînduielilor reacţionare, feudalo-absolutiste, un instrument pentru înăbuşirea mişcării revoluţionare, o piedică în calea luptei popoarelor pentru libertate şi unitate naţională. După zece zile de la încheierea Congresului de la Viena avea să se consume bătălia de la Waterloo, care punea faţă în faţă pe cei trei mai buni generali ai timpului, dintre care unul, cel care purtase sabia de la Austerlitz, va comanda pentru ultima dată.
În 1889, a fost tipărit la Bucureşti cel de al doilea volum al „Tratatului de igienă publică şi poliţie sanitară”, volum redactat de doctorul Iacob Felix, la vremea aceea profesor la Facultatea de Medicină din Bucureşti şi şeful Serviciului sanitar al Capitalei. Apariţia acestei cărţi de aproape 600 de pagini a constituit un eveniment memorabil, nu numai pentru ştiinţa românească, ci şi pentru medicina universală, deoarece era vorba despre cel dintîi manual de epidemiologie în care problemele teoretice şi practice ale prevenirii şi combaterii bolilor transmisibile erau prezentate în lumina concepţiilor medico-biologice revoluţionare ale lui Pasteur. Felix publicase în 1869 primul volum al tratatului, în care definise igiena ca ştiinţă experimental-teoretică şi ca tehnică aplicativă, analizase modul în care sănătatea individului şi a colectivităţii este condiţionată de mediul ambient şi precizase sfera de activitate a unora din principalele ramuri ale igienei. Următorul tom al tratatului, subintitulat „Boalele şi bolnavii”, avea să fie consacrat combaterii epidemiilor şi mai ales mijloacelor de preîntîmpinare a bolilor contagioase. „Cartea de faţă – spunea medicul – este unul din cele dintîi tratate de igienă care se conformă cu noua stare de lucruri, cea dintîi care acordă părţii epidemiologice locul, însemnătatea şi dezvoltarea ce i se cuvin…”.

Unite, secondîndu-l pe doctorul Davila în misiunea de organizare a administraţiei medicale. În această perioadă, printre studiile pe care le-a publicat s-a remarcat cel despre „Apele de băut ale Bucureştilor” (1864), bazat pe analize chimice şi pe investigaţii microscopice, în care demonstra că apa consumată de bucureşteni, provenită din rîul Dîmboviţa, nu corespunde cerinţelor elementare de igienă. În 1865, a fost numit medic-şef al Capitalei, post pe care l-a deţinut, cu unele intermitenţe, pînă în 1892, luptînd pentru a asigura salubritatea oraşului și a ameliora condiţiile igienico-sanitare din şcoli şi atelierele meşteşugăreşti. În timpul Războiului de Independenţă a fost comandant al spitalelor militare de la Turnu-Măgurele, unde erau evacuaţi pentru îngrijire răniţii de pe cîmpurile de luptă de dincolo de Dunăre.
Primul Congres al medicilor, veterinarilor şi farmaciştilor din România, care a avut loc la Bucureşti în 1884, a fost prezidat de Iacob Felix. Eminentul medic igienist şi-a încheiat activitatea din domeniul sănătăţii publice ca director general al Serviciului sanitar al României, post pe care l-a ocupat între 1892 şi 1899.
După cît spune toată lumea, doctorul Felix a fost, pretutindeni şi totdeauna, omul datoriei sale. Aceasta e încă destul de rar la noi. Dar nu numai pentru atîta se cuvine a i se pomeni cu respect numele şi a se păstra o duioasă amintire despre bătrînul care ne-a lăsat. În viaţa şi în scrisul său ştiinţific el a dat dovadă de sentimente înalte şi curate, pe care le-a exprimat, cu toata sfiala ce era în fundul naturii sale, deschis, pe faţă. În cugetarea sa a fost pătrundere şi în cuvintele sale, care mărturiseau necurmat, la orice prilej, unul din cele mai mari rele de care suferă societatea românească, stătea un grăunte de eroism.
Doctorul Felix era un străin. Fusese adus cu contract din Boemia, unde se născuse. Aceasta era prin anii 1860: e timp de atunci! Tînărul doctor, învăţat, muncitor, cinstit şi amabil, avea frumoase perspective de viitor. Ele s-au şi îndeplinit: Felix a fost medic al Capitalei, profesor la Universitate, director al Serviciului Sanitar şi membru al Academiei Române. Străinii știinţifici cari vin la noi sînt, pînă în ziua de astăzi, oameni ambiţioşi, lacomi şi totuşi pururea nemulţumiţi.
Iacob Felix s-a născut pe 18 ianuarie 1832 în localitatea Horschitz din Boemia. Studiile liceale le-a încheiat la Praga, iar diploma de doctor în medicină a obţinut-o în 1857 la Viena. La scurt timp după aceea a venit în Ţara Românească, fiind numit medic al staţiei de carantină şi al oraşului Olteniţa, iar între 1859 şi 1861 a funcţionat ca medic al districtului Muscel şi al spitalului din Cîmpulung. Activitatea sa a fost remarcată de Carol Davila, şeful administraţiei sanitare a ţării, care i-a obţinut, în 1861, numirea în postul de medic al culorii de Galben din Capitală și în acelaşi an i-a încredinţat misiunea susţinerii unui curs de igienă la Şcoala naţională de medicină. Titularul noului curs nu a fost inițial retribuit, dar includerea în programă a unei asemenea materii inovatoare de studiu a fost deosebit de importantă.
Între 1862 şi 1865, Iacob Felix a fost numit viceinspector general al Serviciului sanitar al Principatelor

Doctorul a încetat din viaţă la Bucureşti, în ziua pe 19 ianuarie 1905. La moartea lui, Nicolae Iorga scria în „Sămănătorul”: „Sub raportul frecventării şedinţelor, membrii Academiei Române se pot împărţi în patru categorii: cei care, nefiind în Bucureşti, nu vin decît întîmplător sau la sesiunea generală din martie; cei care, fiind totuşi în Bucureşti, s-au deprins a nu veni niciodată; cei care vin regulat, încasează diurna şi, după ce au stat o clipită, merg acasă sau pe la afaceri şi, în sfîrşit, acei care îşi fac datoria pînă la sfîrşitul şedinţelor.
Unul dintre aceştia nu se va mai vedea la şedinţele de vineri. Puţinii ascultători din tribune nu vor mai recunoaște pe bătrînul foarte alb, curat şi îngrijit, cu favoritele blajine şi strălucitorii ochi buni care venea sprinten, strîns în redingota lui neagră, zguduia puternic, din toată inima, mîna acelora dintre colegii care-i plăceau şi se aşeza la un colţ deoparte, citind iute, nervos, în vreo carte nouă ale cărei foi le tăia cu vitejie. Căci, de multă vreme, bătrînul academician conştiincios nu auzea decît cu ochii, pe care-i îndrepta mulţumiţi, bucuroşi, îndemnători, către acel vorbitor despre care ştia că spune lucruri folositoare, cu scopuri cinstite. O alegere în secția ştiinţifică va da răposatului doctor Felix un succesor mai rău sau poate şi mai bun, dar pentru cîţi l-au cunoscut pe dînsul şi l-au iubit pentru însuşirile lui alese, ascunse totuşi cu atîta discreţie, el nu va fi înlocuit niciodată. Ei vor căuta şi de acum înainte senina frunte lucie aplecată cu o sîrguinţă tînără asupra cărţii noi.
Şi, iarăşi, sub raportul frecventării bibliotecii, sînt mai multe categorii de membrii ai Academiei Române. Unii află prin raportul anual al d-lui Bianu că această bibliotecă tot mai există, ba chiar se îmbogăţeşte din an în an. Alţii împrumută din dînsa multe cărţi, care le folosesc sau ba. Mai rareori se vede însă cîte unul în sala cea mare, lucrînd de-a valma cu oaspeţii străini, cu studentele şi studenţii preocupaţi de lucrările seminariilor şi de examene, sub ochii funcţionarului de serviciu. Măcar vinerea, după şedinţă, erai sigur să vezi printre aceşti lucrători obişnuiţi, fără titluri şi situaţii, pe dr. Felix. De departe i se auzea glasul cînd cerea, în odaia catalogului, cărţile de care avea nevoie. Şi odată ce le ţinea în mînă, venea cu dînsele în mijlocul celor mulţi şi tineri din Universitatea unde fusese profesor pînă deunăzi, şi, la cealaltă masă, începea iarăşi răsfoirea energică, şi fruntea plină de atenţie se pleca asupra rîndurilor.
Ca şi Davila, doctorul Felix nu a fost printre aceşti conquistadores asupra «barbarilor». El nu a înţeles să vie în ţara noastră pentru scopurile lui, ci să primească în sine, pentru scopurile ei, această ţară, cu limba ei, cu aspiraţiile ei, cu dureroasele şi straşnicele ei nevoi. Ca puţini dintre doctorii timpurilor noastre, el nu făcuse în inima sa o zărăfie, ci un altar pentru buna zeiţă Caritas. Pentru dînsul fapta şi scrisul porneau deopotrivă de la acea milă de oameni care e Musa inspiratoare a artei sale.
Cînd vîrsta şi infirmităţile sale l-au scos din slujba statului şi a şcolii, el nu şi-a dat dreptul de a muri în trîndăvie. O nouă activitate ştiinţifică, cea mai bună poate, începe pentru dînsul atunci. Fusese profesor de higienă, venise ca igienist la direcţia Serviciului Sanitar, şi el se gîndi astfel să cerceteze acum în toată istoria noastră igiena publică, dezvoltarea îngrijirii ce s-a dat pe vremuri sănătăţii tuturora. Astfel apărură în «Analele Academiei Române» un şir de studii care formează la un loc o mare carte bogată şi aproape definitivă, care îşi îndreptăţeşte titlul: «Istoria igienei în România».
Acest medic bătrîn, fără atingeri cu erudiţia istorică, s-a priceput, totuşi, cu vechea şi buna sa metodă germană, să găsească prin cărţile noastre pe care a ajuns astfel să le cunoască şi să le preţuiască, mai tot ce-i era de nevoie. Cartea e bine informată şi scrisă curgător. Între lucrările de «istorie ştiinţifică» e, desigur, cea mai bună. Dar şi din alt punct de vedere ea se impune, nu numai luării aminte a învăţatului, ci şi a oricărui om de bine. Căci şi în această lucrare, ca şi în toate celelalte ale lui, el mai are un scop, pe lîngă cel ştiinţific. Înţelegînd şi iubind în acelaşi timp ţara noastră şi neamul ei, el vedea bine că nimic trainic nu se poate răzima decît pe sănătatea, bogăţia şi bucuria de viaţă şi de lucru a țăranului.
Şi în mijlocul atîtor prefaceri, îndreptăţite şi neîndreptăţite, a atîtor creaţiuni în parte fără viitor, a atîtor jertfe pentru lucruri necugetate sau netrebnice, uneori în mijlocul acestei revoluţii culturale, zgomotoase, risipitoare şi încrezute, el vedea că faptul care s-a uitat mai mult e prezenţa în România a peste patru milioane de ţărani foarte săraci, foarte întunecaţi la minte şi ameninţaţi de toate bolile trupului şi ale sufletului. Și pe rînd atîţia români neaoşi cîntau biruinţă din trîmbiţele uşurătăţii sau prefăcătoriei, pe acest om din Horschitz îl durea inima într-adevăr de durerea neştiută a acelor patru sute de mii de nenorociţi.
În doctorul Felix, țăranul român pierde unul din puținii săi prieteni adevărați, și lacrimă pe care, în neștiința lui de oameni și lucruri, nu poate să o verse țăranul însuși, o plîngem aici, noi, cărturarii tineri, care gîndim și gem pentru dînsul și în numele lui”.
DOSARESECRETE RO
Dansul (2)
În continuare, deschidem un mic „intermezzo“, prezentînd foarte pe scurt personajul Mulan, despre care am amintit anterior. Hua Mulan este o figură legendară a Chinei vechi, care a trăit în Perioada „Dinastiilor de Nord și de Sud“. Povestea ei a fost descrisă inițial întrun cîntec popular datînd de pe vremea acestor dinastii. Istoricii nu o consemnează în istoria oficială a Chinei. Conform baladei populare, bătrînul tată al lui Mulan a fost chemat să lupte pe front împotriva barbarilor care invadaseră China. Mulan s-a deghizat în bărbat și a plecat la război în locul tatălui ei. Și-a dovedit vitejia în luptă, ajungînd general. Împăratul, fără a-i cunoaște adevărata identitate, a chemat-o la Curte pentru a-i conferi o înaltă demnitate. Ea l-a refuzat pe împărat și s-a întors în locurile natale, acasă la tatăl ei. De-abia după ce s-a întors acasă, eroina Hua Mulan a părăsit deghizarea sa și toată lumea a aflat că este fată. În unele variante ale legendei, sfîrșitul este trist: cînd ajunge acasă, Mulan află că tatăl ei a murit. Trăsăturile de caracter ale lui Mulan sînt bunătatea pură, pietatea filială, curajul, puterea de a îndura încercări și dezinteresul față de faimă și avere. Aceste calități alese au transformat-o într-o memorabilă figură feminină în cultura tradițională chineză, iar legenda ei s-a transmis mai departe de-a lungul generațiilor pînă în prezent.
Unele dintre cele mai cunoscute și unanim apreciate dansuri tradiționale chineze sînt Dansul Dragonului și Dansul Leului, care au adoptat mai multe forme de-a lungul timpului. O formă de Dans al Leului, similară cu cea de astăzi, este descrisă încă din Dinastia Tang. Dansatorii erau costumați în animale mitice – Dragonul – și fiare – Leul. În timpul dinastiei Han sînt menționate cîteva costume de Dragon, dar specialiștii apreciază că forma Dansului Dragonului din epoca Han este diferită de cea din Dinastia Tang și, prin urmare este diferită și de forma modernă. La început, acest Dans al Dragonului era un ritual care cerea ploaia în perioadele de secetă, căci Dragonul de Est era asociat cu ploaia. Se desfășurau spectacole în care dansatorii erau costumați ca un Dragon Verde, cîntînd la flaut și altele în care
Isterie colectivă și sugestie în massă (9)
Naziştii au încercat prin urmare să-şi păstreze „rasa“ pură, necontaminată, temîndu-se şi urînd orice ar fi putut constitui o ameninţare la adresa propriei lor existenţe. Astfel, instinctele primitive, sălbatice, de frică, ură şi supravieţuire, au străpuns pielea civilizaţiei, dînd întregului trup o înfăţişare hîdă, înspăimîntătoare. Germanii deznădăjduiţi din anii ’20-’30 au destrămat vălul subţire de umanitate, dincolo de care exista Omul Primitiv. Ei au găsit satisfacţii imediate şi răspunsuri îndoielilor ce-i frămîntau în violenţă şi în raportarea la „politica găştilor“. Regimul diabolic al lui Hitler, cu mitingurile isterice de la Nürnberg, cu îndoctrinarea tineretului, cu vînătoarea de evrei şi teorii rasiale aberante, a fost favorizat, în parte, de anxietăţile anilor interbelici şi a generat, la rîndul său, o reîntoarcere la spaimele şi concepţiile epocii primitive. Ce s-a întîmplat atunci în Germania poate constitui cel mai elocvent exemplu asupra pericolelor şi iluziilor pe care isteria colectivă şi sugestia în masă le pot declanşa.
Probleme actuale de spraviețuire (1)
Primele capitole ale lucrării de faţă v-au făcut deja cunoştinţă cu multe dintre remarcabilele cuceriri realizate de medicina alopată în Occident, în mod special în ultimele decenii. Acest tip „ştiinţific“ de medicină rămîne cel mai practicat căci, în ciuda faptului că practicile tradiţionale mai sînt întîlnite în numeroase regiuni ale lumii, nu există deocamdată o alternativă viabilă la tratamentele alopate şi nici un alt sistem
un pește era transformat în Dragon. Dansul Dragonului implică participarea a zece oameni, ce formează o structură în formă de Dragon. Pentru a-i manipula pe cei din urmă, dansatorii folosesc bețe distribuite la intervale regulate. Dragonul poate fi foarte lung și poate implica 100 de dansatori. În China există 700 de tipuri de Dans al Dragonului.
Dansul Leului. Specialiștii în dans consideră că Dansul Leului a fost introdus din exterior și nu provine din tradiția chineză, deorece în China nu trăiesc lei. Dansul Leului ar proveni din India sau din Persia. Cuvîntul leu în chineză este shi – citit șî – și ar proveni din persanul ser. O descriere detaliată a Dansului Leului datează din Dinastia Tang, menționîndu-se că este de origine străină. Cu toate acestea, Dansul Leului apare în China Secolului al III-lea. În Perioada „Dinastiilor de Nord și de Sud“, acest dans a fost asociat cu Budismul. O versiune asemănătoare versiunii moderne a Dansului Leului este descrisă într-o poezie a renumitului poet Bai Juyi din Dinastia Tang. Dansatorii poartă un costum de leu, format dintr-un cap de lemn, o coadă de mătase și un corp de blană, cu ochii acoperiți cu aur și dinții placați cu argint și cu urechi detașabile. Există două variante ale Dansului Leului: varianta nordică și cea sudică. În Tibet există un dans al Leului de zăpadă
Literatura (1)
Literatura chineză se extinde în timp la mii de ani în trecut, de la cele mai timpurii înregistrări din arhivele instanțelor judiciare ale dinastiilor timpurii pînă la apariția romanelor de ficțiune care au fost scrise în timpul dinastiei Ming pentru a distra păturile sociale culte din China veche. Introducerea imprimării cu ajutorul tablelor de lemn, răspîndită în timpul Dinastiei Tang, precum și inventarea tiparului cu caractere mobile de către Bi Sheng în timpul dinastiei Song, au răspîndit cunoștințele și literatura în întreaga Chină, ca niciodată înainte. În epoca contemporană, autorul Lu Xun este considerat fondatorul literaturii moderne „baihua“ în China. Literatura chineză a fost adesea un fenomen nu numai cultural, ci și politic și economic. Pe lîngă o excelență a lecturii și a competențelor de scriere și vorbire, profesiunea de literat permitea deseori funcționarilor să ocupe posturi mai înalte datorită elocvenței, care a contribuit la dezvoltarea filosofiei chineze. De asemenea, unii împărați au evoluat cu succes ca poeți și scriitori.
medical nu se poate compara cu cel deja existent. Privind lucrurile din acest unghi, este de înţeles importanţa pe care istoricii medicinei occidentale moderne o acordă termenului „progres“, făcînd deseori trimitere la el. Dar după cum v-aţi putut da seama, citind despre procesele complexe ce au stat la baza înfrîngerii unor maladii odinioară letale, în prea puţine cazuri se poate vorbi despre o eradicare totală a acestor maladii. Cu alte cuvinte, chiar şi medicina modernă încă se confruntă cu o serie de probleme care ne împiedică să o considerăm drept cronica unor progrese continue.
Trebuie să reţinem, de pildă, că dezvoltarea medicinei ştiinţifice a atras după sine o formidabilă avalanşă de dileme de ordin social, economic şi etic. Descoperirile şi realizările unor figuri marcante, precum Chadwick sau Simon, în promovarea noţiunii de asistenţă sanitară, ca responsabilitate de prim rang ce revine unei societăţi moderne, a reprezentat temelia dezvoltării ştiinţelor medicale în Secolul XX, pe baza unei relaţii mai strînse între autoritatea crescîndă a doctorilor şi puterea statală, indiferent că a fost vorba de ţări guvernate de regimuri liberale sau de state conduse în mod autocratic. Indiferent de ideologia urmată, guvernele şi-au asumat rolul de a supraveghea, dirija şi înfăptui acţiunile de prevenire şi de tratare a epidemiilor şi maladiilor, în general. Procesul a fost sprijinit şi de tendinţa doctorilor (care erau tot mai frecvent asimilaţi unor funcţionari publici, în slujba sănătăţii cetăţenilor) de a urgenta implementarea celor mai moderne practici medicale şi a pleda, pe lîngă guvern, pentru practicarea unei politici juste în sfera sănătăţii, prin asigurarea de condiţii de trai mai favorabile, a unei alimentaţii mai sănătoase, a unor locuinţe mai confortabile, sau a altor atribute ale unei societăţi prospere.
Primele documente scrise în limba chineză, care pot fi considerate literatură, datează din dinastia Zhou. Și mai vechi sînt inscripțiile oraculare pe oase datînd din perioada dinastiei Shang/Yin. La sfîrșitul acestor epoci exista un mare număr de lucrări, ca tratate filosofice, istorice și culegeri de poezii. Unele dintre aceste texte sînt din perioada anterioară și ne oferă o incursiune în acele timpuri străvechi. Printre filosofii ale căror lucrări au și valoare literară sînt Confucius, Zhuang Zi, Lao Zi, Meng Zi, Mo Zi etc. Chiar și lucrarea „Arta Războiului“ de Sun Zi este nu numai un manual pentru militari, dar are și o mare valoare literară.
Literatura chineză are un loc special în istoria omenirii, deoarece în China cultul dedicat cuvîntului scris și unicitatea ideogramelor chinezești își au originea în riturile de divinație. Prin urmare, putem lua în considerare apariția literaturii chineze în momentul în care ideogramele chineze și-au părăsit vocația originară de a construi caractere, silabe care pot fi folosite independent, probabil în anul 2000 î.Chr. Aceste scrieri timpurii păstrează o rigiditate canonică sau vocația filosofică, care, uneori intră în contradicție cu noțiunea occidentală de literatură. Literatura chineză, alături de cea ebraică și indiană este una dintre cele mai vechi tradiții literare, care a rămas neîntreruptă de la apariția sa pînă în prezent. Nu poate fi altfel dacă considerăm că statul chinez este unul dintre locurile în care oamenii au dezvoltat primele elemente ale civilizației. Scrierea a apărut în China în urmă cu 5000 de ani, iar în lungul său proces istoric a inventat cerneala, hîrtia și mai tîrziu tiparul, acesta din urmă cu aproape cinci secole mai devreme decît Occidentul. Literatura chineză are o istorie aproape la fel de lungă ca și aceea a țării în care a luat naștere, datînd din cca. 2.200 î.Chr. în dinastia semilegendară Xia. Cu toate acestea, mulți autori datează începuturile literaturii chineze propriu-zise în jurul Secolului al VI-lea î.Chr., cînd au fost scrise „Cele Cinci Canoane“. Istoria Chinei este cea a unei serii de regate și imperii care s-au succedat pînă la ascensiunea Republicii în 1911. Deși a trăit unele perioade de izolare, civilizația, cultura și literatura chineze au influențat țările vecine, cum ar fi Coreea și Japonia, iar unele opere clasice precum „Dao De Jing“ de Lao Zi sau „Arta Războiului“ de Sun Zi fac parte din moștenirea culturală a umanității. (va urma)
CHRISTINA MEIŢă-TANG
Toate aceste lucruri înseamnă că, la sfîrşitul Secolului XX, medicina din ţările cu economie dezvoltată a devenit, la rîndul său, o afacere profitabilă. Aici, oricare ar fi raportul dintre serviciile publice şi cele private de sănătate, cheltuielile pentru asistenţă medicală au crescut considerabil, atingînd astăzi un nivel de circa 10% din produsul intern brut (PIB), ba chiar în unele cazuri, cum ar fi de pildă cel al Statelor Unite, ele au atins 15% din PIB, adică aproape dublu decît era alocat la începutul anilor ’70. Asemenea statistici demonstrează că procesele prin care aceste societăţi se străduiesc să combată maladiile şi să ofere o speranţă de viaţă mai ridicată au transformat medicina într-o componentă majoră a economiei, necesitînd însă şi investiţii pe măsură, sub forma educaţiei profesionale, a construirii infrastructurii spitaliceşti sau a cheltuielilor pentru cercetare şi inovaţii „high-tech“. Desigur că investiţiile pe tărîm sanitar pot aduce profituri considerabile, fie companiilor de asigurări medicale, fie concernelor farmaceutice. Pacienţii ajung astfel să devină simpli contribuabili, atît din perspectiva investitorilor în domeniul medico-farmaceutic, cît și a celor care caută să limiteze cheltuielile făcute de stat pentru sănătate.
În acest context, nu există nimic mai frapant în privinţa ponticilor sanitare, la începutul Secolului XXI, decît tendinţa societăţilor occidentale de a genera condiţii tot mai bune de asistenţă medicală. De pildă, în domeniul chirurgiei cardiovasculare sau al transplanturilor, progresele ştiinţifice şi tehnologice făcute în ultimele trei decenii au depăşit cu mult nu doar aşteptările cele mai optimiste, dar din păcate şi condiţiile pecuniare existente. (va urma)
F REDERICK C ART w RIGHT, M ICHAEL B IDDISS
Scriitoarea Olga Tokarczuk (n. 1962), laureată a Premiului Nobel pentru Literatură (2018), este una dintre cele mai iubite prozatoare poloneze contemporane. Sau cum se specifică pe ultima copertă a cărții sale, ,,Povestiri bizare”, apărută la ,,Polirom” în 2020, ,,Este probabil unul dintre cei mai mari scriitori în viață de care ați auzit” (,,The Bookseller”). Iar romanul ,,Poartă-ți plugul peste oasele morților” a devenit film.
Olga Tokarczuk a mai publicat și alte romane: ,,Casă de zi, casă de noapte”, ,,Călătoria oamenilor Cărții”, ,,Străveacul și alte vremi”, „Cărțile lui Iacov“ și alte volume de amintiri, traduse în mai multe limbi străine. Cartea de față conține 10 povestiri ,,bizare, insolite, stranii, neobișnuite și totuși clasice. De fapt, ele nu sînt decît un șir de plăsmuiri despre zbaterile omului săși caute locul pe pămînt, neputința descifrării felului cum se reflectă magia în cotidian și, la final, veșnicia sufletului”, după cum apreciază criticul Magdalena Brodacka.
Cele 10 povestiri vorbesc despre destinul unor personaje dezorientate și lipsite de strălucire, de fapt niște mediocrități chinuite de singurătate, angoasate, alienate și înspăimîntate de apocalipsa bătrînetii și a morții.
mereu... La început, aveam coșmaruri cu ăla de la ușă și mă trezeam scăldat în sudori. Dar acum m-am obișnuit. Omul ăla îmi apare în vis nu pentru că îi deschid ușa, ci pentru că se uită el la mine. Ca și moartea, visul nu-i decît o chestiune de ordin personal, o afacere în doi.

În capul listei cu cele 10 povestiri, traduse din Poloneză de Cristina Godun, stă schița ,,Pasagerul”. Real sau imaginar, nu contează, Olga Tokarczuk călătorește cu avionul tot spre vest, probabil spre America. Lîngă ea, chiar la geam, s-a nimerit un pasager cam la 60 de ani, care, ce să facă pînă în America? Relatează un coșmar din copilărie. Avea cîțiva anișori cînd părinții îi cereau să doarmă singur, căci așa recomandau și medicii pentru sănătatea copilului. Și mai în fiecare noapte îi venea visul acela, care îl făcea să sară din somn în țipete și să strige după părinți. Băiețelul care era atunci avea impresia că în camera lui, între fereastră și dulap, se găsea silueta unui bărbat care stătea nemișcat și fuma. El se speria și își alarma părinții. ,,Vezi, nu-i nimic aici”, spunea tata. Mama îl lua în brațe și îl mîngîia: ,,Sînt cu tine, dragul meu. N-o să pățești nimic rău... “. Doar sora mai mare, în răutatea ei, îl speria mereu.
Copilul s-a maturizat și a uitat de omul acela din vis.
…,,Dar, zilele trecute, și-a încheiat bartrînul confesiunea, arătarea s-a ivit iarăși între geam și dulapul copilăriei. De data aceasta, nu m-am mai speriat de el… Pentru că omul pe care îl vezi în vis există nu ca să te uiți tu la el, ci ca să se uite el la tine... Lumea exterioară nu este primejdioasă. Primejdioase sînt uneori visele noastre devenite coșmaruri...”.
Periodic, și eu sînt bîntuit de un vis tîmpit. Se face că un tip îmi bate la ușă. Vezi că mai ai de dat un examen. Ce examen? Ai rămas dator cu examenul la Latină, din anul I. Păi, l-am dat. Păi, ce, ăla a fost examen? Să se conjuge la toate modurile și timpurile verbele sum esse fui și habeo, habere? Fiindcă prodecanul făcuse presiuni asupra unei asistente, să vă dea ceva ușor, ca să treceți anul toți restanțierii. Și, în plus, acuma ați venit, cînd am ieșit la pensie și pot spune că mi se rupe de voi? Ți se rupe? Pai, bă, zice ăla precum contabilul primăriei cînd Moromete se duce la el, să-l păsuiască cu plata foncierei, măcar pînă la primăvară, că acum n-are bani, păi, bă, nu-mi plătești mie, îi plătești statului, și statul nu te iartă, că, anul ăsta, finanțele e mai ale dracului ca oricînd... Păi, bă, fară examenul ăla, înseamnă că ai practicat ilegal meseria de profesor și, pe lîngă pușcărie, te punem să plătești, din urmă, diferența de salariu, timp de 40 de ani, căci ai fost, de fapt, muncitor necalificat, plus dobînda aferentă, de ai să te usuci plătind, și tu, și urmașii tăi... Așa visez
,,Copiii verzi sau istoria straniilor întîmplări petrecute în Volînia, relatate de William Davisson, medicul Majestății Sale Ivan Cazimir” este cea mai lungă narațiune cu care Olga Tokarczuk își justifică Nobelul pentru Literatură.
Pentru cei care nu cunosc istorie, Jan Kazimierz (1609-1672) a fost rege al Poloniei, mare Duce de Lituania (1648-1668) și rege al Suediei (1648-1660).
Apelînd la exprimarea la persoana I, specifică vorbirii directe, și, ca urmare, implicîndu-se nemijlocit în curgerea narațiunii, ca actant și narator deopotrivă, Olga Tokarczuk își imaginează că ar fi huzurit cîțiva ani în Polonia. De data aceasta, era scoțianul William Davisson, medic personal al regelui în cauză, posesorul atîtor titluri nobiliare, ordine și medalii. Și căutînd o comparație mai de Doamne-ajută, își aduce aminte de prietenul său, gînditorul iluminist René Descartes (1596-1650), și el invitat în Suedia, o țară și mai nordică, unde a și murit de frig în floarea vîrstei și în deplinătatea facultăților mintale.
Dar serviciul în slujba regelui Poloniei s-a nimerit a fi în perioada celor mai nefericite evenimente politice și militare. Cică, pe vremea aceea, țara o ducea foarte greu: regele era mai tot timpul bolnav, suedezii și rușii tot năvăleau să pustiască țara, iar țăranii nemulțumiți se tot răsculau. Și tocmai în aceste momente, regele s-a gîndit să se ducă la Liov, să se războiască cu suedezii. Drum foarte greu, cu ploi nesfîrșite, frig și noroaie, precum și un peisaj deprimant, cu păduri de spînzurători și biserici mistuite de foc. Deodată, regele face un atac de gută și coloana regală hotărăște un popas pe moșia domnului Hajdamowicz, șambelanul din Luck. A doua zi, cîțiva ofițeri pleacă la o partidă de vînătoare. Dar, în loc de fazani și căprioare pentru Majestatea Sa, aduc doi copii, un băiețel și o fetiță, cu pielea și părul verzi, ca niște vegetale. Fetița îl scapă pe rege de durerile de gută doar atingîndu-i piciorul cu degetul și părul ei verde. Concomitent, și doctorul Davisson alunecă și își rupe piciorul. Fetița îl tămăduiește și pe el cu lațele-i verzi. Dar, pe neașteptate, băiețelul verde moare. Rămasă singură, fetița, care părea mută, începe să vorbească. Și astfel relatează că, în adîncul pădurii, există niște oameni mai speciali: trăiesc în copaci, mănîncă fructe de pădure, ciuperci și alune și au parte de o lună care luminează ca soarele. Fac copii ca și noi, dar îi cresc împreună. De acolo, din vîrful pădurii, văd cum trăiesc oamenii adevărați, și nu le place ce facem. Ne consideră ireali, ca niște coșmaruri. Nu au auzit de Dumnezeu. Iarna, se ascund în scorburi și dorm vîrîți unii-ntr-alții, ca niște șoareci. Trupul le este acoperit cu un strat gros de mușchi vegetali, care îi apară de frig. Multe alte aspecte caracterizează viața acestor semeni ai noștri, o replică la ce ar dori unii savanți să se întîmple cu societatea omenească în viitor, pentru că e clar: drumul pe care au apucat-o oamenii de cîteva milenii duce într-o fundătură. De aceea ne mai oprim la un aspect: nemîncînd carne, nu vînează și, prin urmare, sînt prieteni cu animalele. Ce e moartea la omuleții verzi? Oamenii verzi se consideră fructe și de aceea, cînd moare vreunul, îl agață în copaci, ca să-l mănînce animalele. Imagine idilică a tărîmului Arcadiei, cea cunoscută în parte și dorită de mulți dintre noi. Dar, fiindcă, pentru păcatele sale, omul a fost izgonit din Paradis, ca să supraviețuiască pe pămînt a recurs la trei mijloace: vînătoarea, pescuitul și culegerea de fructe, semințe și rădăcini. Abia descoperirea agriculturii
a însemnat primul pas al stricării echilibrului naturii și începutul sfîrșitului speciei umane, după cum se vede și cu ochiul liber.
Călătorului nu i-a venit a crede ce a văzut la periferia lumii, acolo unde l-au purtat pașii. În nădejdea că va reveni vreodată pe acele locuri, el emite chiar și o teorie. Cică lumea este formată din cercuri concentrice, care înconjoară un spațiu central, numit Centrul lumii. Dar acest centru se schimbă mereu, de fapt, civilizația este aceea care ne îndepărtează de centru și ne grăbește sfîrșitul făcîndu-ne să-l regretăm: Et in Arcadia ego! La început, centrul a fost Grecia, apoi Roma, Ierusalimul, Constantinopolul. În Secolul al XVIII-lea era Parisul. Acum cine este? Normal ar fi, ne lămurește Olga Tokarczuk, să ne întoarcem iarăși spre Centrul primordial, unde totul capătă sens și ne aranjează într-un tot logic.
Povestirea ,,Conserve pentru iarnă” începe cît se poate de obișnuit. Cîteva babe urîte și cu niște băști caraghioase pe cap asistă la înmormîntarea unei prietene. Întors acasă, proaspătul orfan începe să scotocească prin dulapuri, fără să știe ce caută, bani, acțiuni? Privirea i se oprește pe niște desene de-ale lui de cînd era la grădiniță, plus un caiet al mamei, plin de rețete de murături. Dezamăgit, coboară în pivniță, unde îl impresionează ordinea și curățenia. Dar omul era un trîntor pe spinarea mamei, care îl tot bătea la cap să se angajeze undeva și să se însoare, căci ajunsese la 50 de ani, ce mai aștepta? Casa lor era plină de conserve și murături, printre care unele sortimente chiar batjocoritoare pentru dînsul: ,,Burete de bucătărie în sos de roșii, 2001”. Sau: ,,Șireturi în oțet, 2004”. Sau ,,Genunchi de porc”. Cum spuneam, toată casa era un depozit de borcane. De murit, a murit dintr-un borcan de ,,Ciupercuțe marinate, 2009”. Dar n-a venit nici o rudă să-i ridice cadavrul de la morgă și să-l îngroape. La insistențele Poliției, au venit totuși babele acelea caraghioase, fostele prietene ale mamei. De la un cap la altul, avem de-a face cu o poveste bizară despre singurătatea omului în fața bătrîneții și a morții. Diferă doar modalitatea cum scriitoarea a pus-o în pagină. De fapt, niște plăsmuiri stranii despre locul nostru pe pămînt, veșnicia sufletului și alte chestiuni de ontologie și gnosologie, domeniile predilecte ale filozofilor care, în ciuda străduințelor milenare, n-au reușit să ne dea o explicație rezonabilă despre cine sîntem noi, de unde venim și unde ne ducem.
,,O istorie adevărată” este un text cu multe elemente à la Kafka. Apărînd chiar la începutul povestirii, o femeie cade pe o pardoseală de gresie și își sparge capul. Mai departe, hop și un domn, cu intenția să-i dea o mînă de ajutor, dar care, pînă la urmă, dă de dracul. Domnul este un profesor universitar venit în orașul acela să susțină o conferință despre interconexiunile dintre științele exacte. Nici că se putea găsi ceva mai plictisitor! Dar, plimbîndu-se prin oraș, s-a întîmplat accidentul cu femeia aceea. Omul strigă după ajutor, însă degeaba. Și în țara aceea se practică obiceiul de a nu-ți păsa de necazul altuia. Omul a strigat după un polițist. Au apărut doi, care au și pus laba pe el, crezîndu-l asasinul femeii care sîngera. Au mai venit și doi paramedici care au pus-o pe o targă și au dus-o la spital. Cu mare greutate, profesorul a scăpat din ghearele trecătorilor și a luat-o la fugă spre hotelul unde urma să-și țină conferința. Era plin de sînge pe cămașă și, dacă ar fi intrat așa în hotel, l-ar fi arestat gaborii. Și nici acte nu avea asupra lui. Cum hainele de pe el erau pline de sînge, s-a dezbrăcat la pielea goală și a început să se spele în arteziana din fața hotelului. Ud și gol, nu putea să intre în hotel. Pe terasă, colegi de-ai lui, la fel de celebri, fumau, asteptîndu-l să-și susțină intervenția. El era acolo, ascuns după niște tufișuri, dar nu îndrăznea să iasă la lumină gol-goluț. În cele din urmă, doi polițiști l-au încătușat și, învelindu-i părțile rușinoase cu o haină, l-au aruncat într-o dubă. În această povestire avem de-a face cu o lume plină de îndoieli, în care straniul și imprevizibilul ne domină existența, așa cum două mîini dibace frămîntă aluatul unei prăjituri viitoare.
PAUL SUDITUCînd Isus este numit Mielul lui Dumnezeu în Ioan 1:29 şi Ioan 1:36, se referă la faptul că El este sacrificiul, perfect şi suprem, pentru păcat. Pentru a înțelege cine a fost Isus Christos şi ce a făcut El, trebuie să începem cu Vechiul Testament, care conține profeții privind venirea lui Christos ca „jertfă pentru păcat” (Isaia 53:10). De fapt, întregul sistem al sacrificării stabilit de către Dumnezeu în Vechiul Testament a pregătit terenul pentru venirea lui Isus Christos, sacrificiul perfect pe care Dumnezeu L-a oferit ca răscumpărare pentru păcatele poporului Său (Romani 8:3; Evrei:10). Sacrificarea mieilor a jucat un rol foarte important în viața religioasă a evreilor. Cînd Ioan Botezătorul s-a referit la Isus ca fiind „Mielul lui Dumnezeu, care ridică păcatul lumii” (Ioan 1:29), este posibil ca evreii care l-au auzit să se fi gîndit imediat la unul dintre cele mai importante sacrificii. Cum perioada Paştelui se apropie, primul gînd care poate apărea este sacrificarea unui miel. Sărbătoarea Paştelui era una dintre principalele sărbători la evrei în amintirea eliberării evreilor de către Dumnezeu din robia la care erau supuşi în Egipt. De fapt, sacrificarea unui miel de Paşte şi stropirea tocurilor de la uşi cu sînge (Exod 12:11-13) este o imagine frumoasă a lucrării ispăşitoare pe care Christos a făcut-o pe cruce. Cei pentru care El a murit sînt acoperiți de sîngele Său, protejîndu-ne de îngerul (spiritual) al morții.

Un alt sacrificiu important care implica mieii era sacrificiul zilnic de la templul din Ierusalim. În fiecare dimineață şi seară, un miel era sacrificat în templu pentru păcatele poporului (Exod 29:38-42). Aceste sacrificii zilnice, ca toate celelalte, se făceau cu scopul de a arăta oamenilor jertfa perfectă a lui Christos pe cruce. De fapt, timpul la care Isus a murit pe cruce corespunde timpului la care se făcea sacrificiul de seară la templu. Evreii de la acea vreme ar fi trebuit să fie familiarizați cu profeții Vechiului Testament Ieremia şi Isaia, care le-au spus mai dinainte de venirea Celui ce va fi adus „ca un miel dus la tăiere” (Ieremia 11:19; Isaia 53:7) şi ale cărui suferințe şi sacrificiu vor furniza răscumpărarea poporului Israel. Bineînțeles, acea Persoană nu era alta decît Isus Christos, „Mielul lui Dumnezeu”.
Deşi idea unui sistem al sacrificării poate părea ciudată pentru noi astăzi, conceptul plății sau răscumpărării este
Cella Delavrancea – un secol de viaţă trăită alături de figuri marcante ale culturii româneşti (VI)
Amintiri cu oameni dragi (4) ,,Trei prieteni: Caragiale, Vlahuță, Delavrancea” (2)
„Cînd se auzea «a venit domnul Grigorescu», pianul amuțea brusc. Grigorescu cerceta dintr-o privire încotro e prietenul lui, Barbu. Se luau de braț și veneau spre noi. Mînca, ciugulind ca o pasăre. Asculta și cu ochii. Nervii lui de singuratic se zgîrceau în societatea oamenilor. Numai cu tatăl meu, și mai tîrziu cu poetul Vlahuță, era destins și uneori – foarte rar – vesel.
Alexandru Vlahuță, prietenul cel mai vechi – cel de toată viața – al tatălui meu, era și frate de cruce cu el, de pe timpul cînd locuiau împreună, tineri studenți, la Hotel Metropol. Nu semănau unul cu altul deloc – dar se împlineau. Măestrașul – cum îi spuneam noi – Lupu, cum îl porecliseră doctorii Jubi și Raoul Dona, semăna cu un vers de hai-ku. O liniște stranie de filosof chinez îl făcea impunător. Ciuful părului era negru ca păcura. Modela ideea cu prudență și autoritate în același timp. Se ferea de vulgaritate și nu tolera exuberanța decît în inteligență. Politețea lui excesivă era și scutul care-l apăra de familiaritățile indiscreților. Ochii lui ardeau ca jarul, un far negru în care te pierdeai ca în beznă. Își adora cele două fetițe, cu care eram prietene nedespărțite. Citea din Eminescu cu un glas de clopot și o știință incomparabilă în cadențare. Era și cel mai bun interpret al nuvelelor lui Caragiale, avînd darul schimonosirii cu gesturi comice. Își aduna degetele cînd spunea «Vrea Bubico un zăhărel?» și apărea ca prin minune mamițica bietului cățeluș. Inteligența lui era gravă, în slujba sufletului, fără slăbiciuni. Cumpărase multe tablouri de la Grigorescu și, în casa lui, împodobită cu covoare, privea pînzele minunate, așezat la faimoasa masă de brad, pe care fiecare scriitor lăsase cîteva rînduri. Primea bucuros și încuraja pe cei vrednici. Povestea cu debit lent, extrem de plastic, și avea un dar de observație, adevărate sondaje psihologice. Nu se supăra niciodată aparent.
Pe cît era tatăl meu de nervos și uituc la pică, pe atît era Vlahuță de calm și sigur în luare aminte. Le înscria pe toate, undeva, în cartea sufletului și doza temperatura încrederii după adunarea pe care și-o făcea singur. Mîndria lui era modestă și nu s-au bucurat destul de mulți oameni de capacitățile inteligenței și culturii lui. Nimeni n-a încarnat prietenia mai adînc ca el. În sentimentele lui regăseai nuanțele unei civilizații în care se adeverea o cultură sufletească, rar întîlnită la noi. Pe aceste culmi morale erau alături, tatăl meu și el, într-adevăr frați de cruce, unul calm, celălalt liric, precum găsești pe o medalie un profil clasic pe o parte și pajura cu aripi întinse pe reversul ei. În devotamentul ce-l purta lui Delavrancea și lui Caragiale parcă ar fi citit o justificare a existenței lui. Dacă-i zicea tatăl meu «ascultă frate Alecule, doresc...», Vlahuță răspundea «da» înainte de a afla despre ce este vorba. Pentru Caragiale avea o grijă de părinte. Caragiale, în acest triptic al prieteniei, era cel mai răsfățat și cel mai nepăsător. Spiritul lui era uluitor. Juca teatru pentru alții și pentru el. Te lua în vîrtejul sofismelor, te subjuga cu farmecul lui de grec subtil, iar dacă-l plictiseai te părăsea, ștergîndu-ți pe veci amintirea. Respecta inteligența și și-o dăruia pe a lui cînd se afla întrun cerc demn de el. Copiii lui erau deștepți și foarte citiți, cu toate că nu urmau nici o școală, tatăl lor avînd fobia microbilor și o frică puerilă de boală. Caragiale nu trăia în București. Căpătase o moștenire și se instalase la Berlin. Apărea din cînd în cînd în București. Acum eram măricele. Ne mutasem în Strada Primăverii – actuală Bălcescu –și studiam pianul într-un salon mare care dădea în hol. Dintr-o dată apărea Caragiale în ușă. Ținea în mîna stîngă un portțigaret de chihlimbar galben, pălăria era dată puțin pe ceafă, surîdea hazliu. Tata se grăbea spre el. Îl oprea cu un gest rapid. Apoi... continua să vorbească cu un personaj imaginar și se dezvolta sub ochii noștri o comedie în care Caragiale juca toate rolurile, cu o vervă irezistibilă. Cînd se potolea fantezia, ne da bună ziua și se informa afectuos de sănătatea fiecăruia. Alteori, cînd sosea, îi săream înainte. «De ce te-ai înroșit, taică?», glumea tata.
încă unul pe care îl putem înțelege cu uşurință. Ştim că plata păcatului este moartea (Romani 6:23) şi că păcatul nostru ne desparte de Dumnezeu. De asemenea, ştim că Biblia ne învață că toți sîntem păcătoşi şi nici unul dintre noi nu este neprihănit înaintea lui Dumnezeu (Romani 3:23). Din cauza păcatului nostru, sîntem separați de Dumnezeu şi ne facem vinovați înaintea Lui. De aceea, singura speranță pe care o putem avea este în cazul în care El asigură o cale prin care noi să fim împăcați cu El, şi tocmai acest lucru a făcut El cînd L-a trimis pe Fiul Său, Isus Christos, să moară pe cruce. Christos a murit pentru a face ispăşirea pentru păcat şi pentru a plăti amenda pentru păcatele tuturor celor ce cred în El.
Prin moartea Sa pe cruce, ca sacrificiu perfect al lui Dumnezeu pentru păcat şi prin Învierea Sa trei zile mai tîrziu putem avea acum viața veşnică, în cazul în care credem în El. O parte din glorioasa Veste Bună a Evangheliei este faptul că Dumnezeu Însuşi a furnizat jertfa care ispăşeşte păcatele noastre, fapt ce este declarat atît de clar în 1 Petru 1:18-21: „Căci ştiți că nu cu lucruri pieritoare, cu argint sau cu aur, ați fost răscumpărați din felul deşert de viețuire, pe care-l moşteniserăți de la părinții voştri, ci cu sîngele scump al lui Christos, Mielul fără cusur şi fără prihană. El a fost cunoscut mai înainte de întemeierea lumii, şi a fost arătat la sfîrşitul vremurilor pentru voi, care, prin El, sînteți credincioşi în Dumnezeu, care L-a înviat din morți, şi I-a dat slavă pentru ca nădejdea și credința voastră să fie în Dumnezeu”.
Prof. ALINA TăLPEANUCaragiale ridica degetele subțiri: «Aghiuță, mai întîi să-mi cînți din bunicu-tău, Scărlătescu». Avea un glas ros de tutun și de o ironie diabolică. Îi plăcea Scarlatti și spunea că-l cînt atît de bine încît, desigur, compozitorul italian mi-a fost străbunic. M-așezam la pian. Cîntam o bucată. Caragiale asculta, în picioare, cu o expresie îmblînzită. «Încă o dată... încă o dată». Mă punea să-i repet același lucru de cîte 5 ori în șir. (...) Adora muzica și o cunoștea bine. Nimeni nu mi-a vorbit despre Beethoven ca el. Pentru Chopin n-avea simpatie. Rîdea disprețuitor, trăgînd apăsat din țigară. «Au găsit-o pe George Sand, Musset și Chopin, să le stea cu lămîia la gură cînd le-o veni greață». César Franck îl agasa și îi persifla melancolia. «Parcă-i un cerșetor la colț de stradă, cu terța lui minoră întinsă ca să ne fie milă de el». Mă ruga să-i cînd din Bach, Beethoven, Schumann și Scarlatti. De acum, Caragiale se instala la taifas, cînd la noi, cînd la Vlahuță. Porneau pe calea strălucitoare a imaginației. Glumeau, discutau, disertau”.
,,Mi-aduc aminte de o discuție în contradictoriu, care a ținut vreo 7 ceasuri. La aceste agape intelectuale erau admiși cîțiva. Li se dădea de veste. Vlahuță locuia în Palatul Funcționarilor din Piața Victoriei. La el trăgea Caragiale. Aroma ceaiului bun și zăngănitul linguriței în pahar îmi evocă imediat aceste adunări, unde se cheltuia atîta spirit, atîta înțelepciune, numai de dragul speculațiunilor abstracte. Veneau, grăbiți și bucuroși, tînărul profesor Ionel Ștefănescu, ginerele lui Vlahuță, Cioflec, frații Dona, inginerul Eugen Ștefănescu, nepotul mult iubit al tatălui meu, Cerna, poetul senzitiv, care rămînea cu mîna la obraz în semn de uimire, și alții. Asistam la acest «tournoi» intelectual pînă la o anumită oră. Dumnealor, cavalerii, erau neobosiți. Tatăl meu, liric și inspirat. Caragiale cu o imaginație de vrăjitor. Vlahuță, cugetător și dirijînd discuția spre stilul ei cel mai înalt. Cînd vorbea Caragiale despre Beethoven uimea pe toată lumea. Cînd desfășura Delavrancea marile virtuți ale neamului românesc și descria România de mai tîrziu – rotundă ca o bombă și aurită din belșug, lăcrămau toți. Cînd Vlahuță, moralist, enunța, cu glasul lui de bas, cîte o gîndire, tăceau ceilalți, și tata răspundea «Așa e, Alecule»“. (va urma) r.m.
Miracolul fiecărei primăveri
În fiecare, an odată cu revărsarea luminii din ce în ce mai clară peste natura renăscută la viață, cînd pămîntul ne vestește germinarea mirabilei semințe, în fiecare anotimp de curățire și primenire a naturii înconjurătoare, omul trece și printr-o curățire sufletească, printr-o primenire a vieții sale interioare – schimbări profunde, prilejuite de cel mai mare eveniment din perimetrul credinței creștine – Moartea și Învierea Lui Isus. Împletit cu Primăvara pămînteană, într-o simbioză născătoare de datini și energii transcedentale – Paștele rămîne Sărbătoarea celui mai adînc sentiment uman, născut din credința în Dumnezeu, anume că, atîta timp cît în calendarul creștin Sărbătoarea Pascală marchează miracolul Învierii Domnului Isus Christos, care s-a jertfit pentru spălarea păcatelor omului și a Înviat a treia zi după Scripturi, noi sîntem salvați, indiferent de ce agresiuni umane și religioase se abat peste omenire.
Într-un asemenea moment de euforie și de alchimie sufletească, în care aripa zborului spre infinitul credinței se înalță liber, nu trebuie să uităm de campania care se desfășoară împotriva Creștinismului și a Ortodoxiei –acțiune generată de politica globalistă, cu iz antichrist, care încearcă, ba direct, ba pe căi oculte, să distrugă credința strămoșească, să ne depărteze de Religia Bibliei, inducînd în mentalul credincioșilor ideea că fac acest lucru numai și numai în marea lor grijă de a ușura viața omului pe pămînt!
Propaganda acestor debusolați ai sorții care, de fapt, se constituie într-o crasă blasfemie la adresa Bibliei, dar și într-un atac furibund la adresa Constituției și a normelor instituite într-un Stat de Drept – ce promovează, cu ce idei și cu ce trăiri vin să înlocuiască preceptele religioase și civice ale unei societăți de la începutul mileniului III? Dacă, acum, amintesc doar cîteva, cred că sînt destul de semnificative pentru a demonstra „binele” pe care ni-l vor acești propovăduitori ai unei lumi frivole și degradante, o lume a tavernelor de la hotarul dintre australophitecus și homo habilis, în urmă cu 2 - 3 milioane de ani:
1. Renunțarea la denumirea părinților, cu numele de tată și mamă, și înlocuirea acestora cu numele de identificare – părinte 1 și părinte 2;
2. Acceptarea oficializării căsătoriilor dintre persoane de același gen;
3. Acceptarea înfierii copiilor de către aceste cupluri;
4. Acceptarea acestor cupluri (feminine) de a da naștere unor copii prin metoda inseminării artificiale sau a celei in vitro;
5. Reglementarea, oficială, a funcționării deviației unor persoane de la normalitatea sexuală, așa numita LGBT;
6. Introducerea în școala românească, încă din clasele primare, a disciplinei „Educație sexuală”.
Aceste proiecte și aberații interumane, pentru legiferarea cărora se fac presiuni de la Uniunea Europeană (se știe că, în cadrul acesteia, în multe țări s-a dat dezlegare la această politică de modificare a caracterului natural al omului), sînt considerate tabu, și, dacă ai curajul să le ataci sau să aperi integritatea morală a omului, ești tratat cu dispreț, ca un ins înapoiat și potrivnic „modernizării” societății. Despre rezultatele finale ale acestei așa-zise modernizări, cît și

despre împotrivirea unor ONG-uri (și chiar a unor părinți) de a se preda Religia în Școala Românească, cu participare voluntară, las cititorii să discearnă... După această acoladă jurnalistică, datorată contextului în care sărbătorim Sfintele Paște (realitate pe care nu avem voie să o negăm, dacă vrem să fim onești cu noi înșine și cu cititorii), să schimbăm registrul informației și să încercăm să recreăm atmosfera de acum 1990 de ani, care a marcat intrarea lui Isus în Ierusalim, în ziua de noul Nisan (Floriile noastre, de azi), judecarea Lui de către Pilat din Pont (procurorul roman al Iudeii) și condamnarea la moarte, moartea pe cruce, depunerea în mormînt și învierea „a treia zi după Scripturi”, miracolul ceresc definitoriu pentru Creștinism, în aceste prime două milenii scurse de la acest eveniment - miracol.
Isus din Nazaret
Dacă deschidem Biblia, mai precis Noul Testament, și începem a citi din „Sfînta Evanghelie după Matei”, vom desluși izvorul darnic al Creștinătății, din care, de 2.000 de ani, bem apa tămăduitoare a Religiei. Pentru ceea ce ne interesează astăzi – chipul Mîntuitorului Isus Christos, în ipoteza ultimei săptămîni de viețuire pe pămînt, printre oameni, cu finalul apoteotic despre care am pomenit în rîndurile de mai sus – citim din înțelepciunea Bibliei și încercăm să facem loc meditației. „Iar cînd s-a făcut seară, a șezut la masă cu cei doisprezece ucenici. Și cînd mîncau, Isus a zis: Adevărat grăiesc vouă, că unul dintre voi Mă va vinde” (Matei 26: 20,21). „Iar pe cînd mîncau ei, Isus, luînd pîine și binecuvîntînd, a frînt și, dînd ucenicilor, a zis: Luați, mîncați, acesta este trupul Meu”. Și luînd paharul și mulțumind, le-a dat, zicînd: „Beți dintru acesta toți. Că acesta este sîngele Meu, al Legii celei noi, care pentru mulți se varsă spre iertarea păcatelor. Și vă spun vouă că nu voi mai bea de acum din acest rod al viței pînă în ziua aceea cînd îl voi bea cu voi, nou, în Împărăția Tatălui Meu” (Matei: 26-29). Ne închipuim mirarea ce se putea citi în acel moment unic pe chipul celor 12 ucenici, martorii uneia dintre pildele


Mîntuitorului, pe care – din colo de pecetea su bliminală cu care priviseră – căutau miezul problemei, puși, într-un fel, în gardă, cu privire la viitoarele acțiuni ale Lui Isus. De aici încolo lucrurile se precipită, și învățăturile Mîntuitorului se succed într-un ritm alert, în raport cu condensarea puținelor zile pe care le mai avea de trăit pe acest pămînt, printre muritori. Din desfășurarea Cinei celei de Taină și binecuvîntarea pîinii și a vinului, noi am rămas cu instituirea de către Christos a tainei euharistiei, ca mijloc binecuvîntat și haric a unirii credincioșilor cu Christos. Din acel moment împărtășirea cu preacuratul trup și cu preacinstitul sînge le-a rămas ucenicilor ca poruncă de săvîrșire a acestei taine în popor, ca amintire a Mîntuitorului, act creștinesc, astfel cum îl cunoaștem noi ca Sfînta Împărtășanie.
După Cina cea de Taină, Christos ieși din oraș împreună cu ucenicii Săi și, coborînd pe valea rîului Cedron, intră în grădina Ghetsimani, unde, retrăgîndu-se într-un anume loc, s-a rugat Tatălui Ceresc, pregătit pentru încercarea ce urma – martiriul în fața oamenilor, tocmai pentru a lua, cum era voia Domnului, păcatele omenirii pe umerii săi, îngreunat de gîndurile ce-l năpădeau: „Întristat este sufletul meu pînă la moarte!” (Matei 26:38). Nu mult după aceea, din desișul arborilor de măslin, înarmați cu săbii și pari, s-au arătat soldații și slujitori ai templului și ai casei arhierești, pregătiți să vadă semnalul trădării lui Iuda – sărutul de 30 de arginți. Cu mîinile legate precum un tîlhar de drumul mare, Isus se adresă acestei gloate de slujitori ai Imperiului, cu următoarele cuvinte, pline de tîlc și înțelepciune, dar și încărcate de demnitate: „Ați ieșit ca la un tîlhar cu săbii și pari, ca să mă prindeți. În toate zilele am fost cu voi în templu, și nu M-ați luat. Dar împlinească-se Scriptura!” (Matei 26:55).
În acea noapte, din grădina Ghetsimani începea Golgota, ultimul drum pe pămînt al lui Isus Christos, drum la capătul căruia avea să se împlinească porunca Dumnezeiască a supliciului, a morții pămîntene și a Învierii Fiului din Cer. Pînă atunci însă, drumul a trecut pe la arhireul Hanan, apoi pe la arhireul Caiafa, pe la Irod cel Mare, ajungînd, în final, pe mîna procurorului roman al Iudeii, Pilat din Pont, în fața căruia a fost judecat și dat spre răstignire muțimii înfierbîntate, deși acesta era convins că Isus era nevinovat. În acest moment greu pentru Isus ies, din nou, la iveală înțelepciunea și gîndirea sa pragmatică – două calități care i-au derutat pe anchetatorii săi, unii (Pilat) încercînd mai multe variante pentru a-L salva de la pedeapsa cu moartea. Iată o mostră de atitudine fără echivoc, și un răspuns care a avut darul să-i cutremure pe cei care, deși puțini, intuiau veridicitatea spuselor arestatului. Întrebare: „Te jur pe Dumnezeul cel viu, spune nouă: Tu oare ești Christos, Fiul lui Dumnezeu?”. Răspuns: „Dacă vă voi spune Eu, voi nu veți crede, și dacă Eu v-aș pune întrebările, oare ar servi ca dovadă a drepturilor Mele supreme, voi n-ați răspunde la ele. Tu ai spus adevărul: Eu sînt Malha-
„Cina cea de taină“, pictură de Leonardo da VinciMeșiha-Regele Mesia, Fiul lui Dumnezeu, și după aceea voi Mă vedeți deja șezînd acolo și venind pe norii Cerului” (Matei 26:63, 64).
Apropierea Paștelui schimba viața în Ierusalim. În ziua care se numea „pregătirea pentru Paști”, care era Vinerea Mare, forfota se simțea de cu zori, oamenii încercînd să-și rezolve problemele în partea răcoroasă a zilei, evitînd arșița prînzului. Ierusalimul vechi, cu străzile sale înguste și cu mulțimea de bazare înghesuite, cunoștea o oarecare animație în fiecare zi, dar acum, în preajma Sărbătorilor Pascale, orașul sfînt devenea neîncăpător. Conform mărturiilor contemporanilor, la prăzmuirea Paștilor, locuitorii și vizitatorii ajungeau la cota de aproape 3.000.000 de oameni. În acest cadru, de zile premergătoare Paștelui, suprapunîndu-se cu procesiunile specifice acestei sărbători, au avut loc procesul, moartea și Învierea lui Isus – triada care a dărîmat o lume, punînd bazele unei lumi a evlaviei și credinței Creștine întru Cel de la care se numără anii Erei noastre – Mîntuitorul Isus Christos.
Astfel cum citim în Istoria Iudeii, între anii 26-36, procurator era Ponțiu Pilat, un fel de guvernator peste Iudeea și Samaria, care alcătuiau un ținut, ca parte a marii provincii Siria. După literatura vremii, Pilat conducea precaut, evitînd degenerarea situațiilor conflictuale cu masele de iudei, procedînd cu înțelepciune pentru a nu fi nevoie să apeleze la folosirea forței armate. Acest caracter l-a demonstrat și în cazul judecării Lui Isus, cînd a încercat, de mai multe ori, să orienteze lucrurile spre o achitare a celui judecat. În afară de înțelepciunea sa, Pilat se sprijinea pe cunoașterea realității, întrucît, de-a lungul anilor în care el era procurator al Palestinei, ordonase agenților urmărirea Lui Isus pentru a-i cunoaște activitatea din teritoriu. Curînd și-a dat seama că acest galilean, în cuvîntările Sale nu ridica probleme politice, doar conduita morală și demascarea rabinilor iudei, a cărturarilor și a fariseilor nesimțiți și fățarnici era în epicentrul acțiunilor Lui Isus cu poporul.
În contextul analizei de mai sus, ceea ce s-a întîmplat a fost ca un ecou la atitudinea lui Pilat. Cînd, de pe scaunul său judecătoresc, acesta îl zări pe arestat în mijlocul gloatei dezlănțuite, întrebă: „Cu ce învinuiți voi pe Omul acesta?”. Deodată în mulțime se ivi un freamăt și un talaz de glasuri răcneau disperate, formulînd un alt răspuns pe care Pilat nu-l aștepta: „Dacă Acesta n-ar fi fost vinovat, nu ți l-am fi dat ție”. Nemulțumit de turnura pe care alunecase procesul, încă de la început, Pilat încearcă o stratagemă naivă: „Luați-L voi și-L judecați după legea voastră”. Răspunsul gloatei îi tăie gîndul care-i punea în creier următoarea mutare: „Nouă nu ne e îngăduit să dăm la moarte pe nimeni”. Intervenția lui Caiafa îngreună și mai mult situația procuratorului Pilat: „El a răzvrătit poporul și oprește a plăti dare Cezarului, numindu-se pe Sine Regele Christos”.
Jocul de-a șoarecele și pisica începuse deja. Prins între mulțime, martori și acest om blînd, care suferea într-o demnitate neverosimilă, Pilat continua dialogul, sperînd la ivirea unei scîntei de sublim din răvășitoarea masă de „apucați” din fața lui. „Tu ești regele Iudeei? Adevărat, oare, Tu în adevăr declari această periculoasă pretenție?”. Cînd formulase această întrebare, Pilat se gîndise că un răspuns negativ din partea lui Isus l-ar putea ajuta în eliberarea acestuia. Surprinzător, Christos veni cu un răspuns sub formă de întrebare: „De la tine zici tu asta,

sau alții ți-au vorbit de Mine?”, continuînd într-o cheie care-l dezlega de toate acuzațiile: „Dacă împărăția Mea ar fi în lumea asta, atunci slujitorii Mei s-ar fi luptat pentru Mine, ca Eu să nu fiu dat iudeilor. Dar acum împărăția Mea nu-i de aici”. Pilat nu mai înțelese nimic. Pentru a accelera o rezolvare, reveni cu întrebarea-cheie, al cărei răspuns putea fi fatal pentru arestat. Replica lui Isus a fost și mai devastatoare, prin repetiție: „Tu zici că Eu sînt împărat”. La auzul acestor cuvinte înșelătoare, Pilat se cutremură de teamă. Isus se expusese singur pericolului de a fi acuzat de jignire a majestății. Coroborat cu legile romane care puneau recunoașterea drept condamnare, răspunsul însemna condamnarea la moarte a arestatului.
Surpriză, însă. Omul din fața judecătorului i-a transformat iar credința, aducîndu-i o adiere de ușurare sufletească în momentul următor, cînd glasul împricinatului a detunat falsa anatemă lipită de numele Mîntuitorului: „Eu pentru aceea M-am născut, și pentru aceea am venit pe lume, ca să mărturisesc adevărul: tot ceea ce-i din adevăr, ascultă glasul Meu. Iată în care înțeles sînt Eu împărat și iată care sînt următorii mei”. În acel moment Pilat a înțeles definitiv că Cel din fața lui nu este nicidecum un răzvrătit ca cei mulți din piață, ci este un visător cu totul nepericulos, un filozof care caută răspuns la întrebările despre adevăr și alte asemenea lucruri nepericuloase, care nu aduc atingere autorității romane.
Degeaba, însă. Vulgul înfuriat se agita, valuri, valuri, derutîndu-l pe Pilat. Cînd și încercarea cu răufăcătorul Baraba, propus în locul lui Isus, la condamnare, a eșuat, Pilat a clacat: „În acest caz, luați-l voi și-L răstigniți, căci eu nu aflu la El vină”. Cronicarii acestui eveniment epocal, vizavi de neputința lui Pilat de a se opune pînă la capăt condamnării la moarte a lui Isus, îl acuză de lipsa de bărbăție morală și cetățenească. Dincolo de aceste acuzații obiective, avem replica interioară a lui Pilat, consemnată tot în acest context destul de emoțional și de interpretativ. Iat-o: „Și el fu cuprins de frică, deoarece însuși acești născocitori de rele,

fiind cei mai mari dușmani ai stăpînirii romane, în cazul dat au putut apărea în calitate de partizani ai coroanei romane și să-l denunțe pe Pilat la Roma, ca trădător, care a susținut public pe oarecare uzurpator ca rege al Iudeei”. Îndurerat, dar înfrînt, Pilat face un gest rămas în legendă ca o atitudine de a da vina pe altul: porunci să i se aducă vasul cu apă, apoi, el „și-a spălat mîinile înaintea poporului și a zis: Nevinovat sînt eu de sîngele Dreptului acestuia. Vedeți voi...” Conform proverbului „Dumnezeu nu doarme”, toți cei care au fost implicați în cazuistica dramei Mîntuitorului și-au primit pedeapsa divină. Răvășit de păcatul pe care-l săvîrșise, Iuda, după ce aruncă punga cu prețul trădării, se spînzură în primul copac care-i iese în cale, dar nici arborele nu voi să-i susțină trupul lui de criminal: creaga se rupse și el „se probuși, din cădere pîntecele lui se desfăcu și se risipiră toate măruntaiele lui”; Caiafa a pierdut funcția în anul următor; Irod a murit în rușine, exilat; Pilat, decăzut din drepturi, după aceeași învinuire, pentru care a vrut să evite cedarea criminală, prigonit de societate, s-a sinucis în exil; unii din cei părtași și martori la această crimă, și mii de copii ai lor au fost trecuți de Împăratul Cezar prin foc și sabie (atunci cînd s-au răsculat), fiind răstigniți cu miile, de către romani, în afara zidurilor cetății, nemaiajungînd lemnul pentru crucile pe care atîrnau trupurile iudeilor însîngerate... așa cum ei, în anul 33, L-au răstignit pe Fiul lui Dumnezeu...
Tot vorbind despre răstignire, în cazul de față a lui Isus Christos, ne-am întrebat de unde vine această practică barbară, pe care, în realitate, nu știu cîți dintre noi, acum, ar putea-o privi? Iată un răspuns succint la respectiva întrebare, desprins din stufosul material studiat în vederea scrierii acestui articol. În epoca veche, răstignirea era socotită ca rușinoasă și înjositoare, ca însăși amintirea numelui ei, precum zicea marele om politic, orator, filozof și scriitor roman, Cicero: „Niciodată n-ar trebui apropiată de cugetarea, de ochii sau de urechile cetățeanului roman, și cu atît mai puțin de persoana lui”. De origine orientală, cu mult înainte de pătunderea în Europa, se practica la perși, fenicieni și cartaginezi.
În Palestina a fost folosită pentru prima oară de Alexandru cel Mare (356-323 î.d.Chr.) ca pedeapsă capitală pentru apărătorii orașului fenician Tyr, cînd au fost răstigniți 2.000 de locuitori. Dacă vorbim de Roma, cruda pedeapsă cu moartea prin răstignire a fost introdusă de Marcus Licinius Crassus (115-53 î.d.Chr.), pedepsind, astfel, răsculații conduși de gladiatorul Spartacus, în cea mai mare răscoală a sclavilor din antichitate. Apoi a fost implementată, ca să spunem așa, în sistemul de pedepse pentru anumiți răzvrătiți și criminali, nesupuși ai legilor statale. La iudei, tocmai în perimetrul geografic la care ne raportăm în acest material, acest mod de pedeapsă cu moartea era considerat păgîn. De pildă, în Vechiul Testament, unde se scrie despre „spînzurarea pe lemn”, de obicei se săvîrșea asupra trupurilor deja moarte, cazurile de răstignire pe cruce fiind o excepție, ca o înrîurire a unor popoare păgîne înconjurătoare.
(urmare din pag. 13)
Cum explică, însă, istoricii și unii capi ai bisericii denaturarea unei practici cu rădăcini adînci în Talmud, și alegerea supliciului morții pe cruce, în cazul Lui Isus? Pînă în acel an, 33, era imposibil ca un iudeu să vrea pedepsirea altui iudeu prin acest dezgustător și barbar procedeu – așa gîndeau toți. Acum însă, propaganda zarafilor și a fariseilor, speriați de spectrul răsturnării legilor societății rău famate, pe care le presupunea practica acelui ce, însoțit de ucenici și de alți adepți, cel numit Mesia, propăvăduiau cuvîntul Domnului, a indus în masa neinstruită a populației un înalt grad de ură și de răzbunare, ajungîndu-se la un numitor comun al arhireilor și plebei – urcarea lui Isus pe cruce și moartea Lui în acest mod.
Pînă la acest moment fatal pentru Isus, El avea să fie supus la alte încercări fizice și psihice, printre care purtarea Crucii, de la Praetoriumul (locul judecării lui Isus) pînă la Golgota, locul răstignirii. Cunoscut ca Drumul Crucii, traseul are un număr de 9 plus 5 opriri, fiecare dintre acestea avînd o semnificație aparte. Supranumit și Via Dolorosa, Drumul Crucii reprezintă ultimul traseu parcurs de Isus pe străzile
nu sînt sesizate ca atare. Cînd s-au ridicat cele trei cruci, cu cea din centru (a lui Isus) mai înaltă decît a celor doi „tovarăși” în moarte, căpeteniile iudeilor au văzut negru înaintea ochilor: în otrăvita lor nebunie de a-l vedea pe Mesia mort pe cruce, se îmbătau deja cu o asemenea victorie, dar, văzîndu-L între doi tîlhari și pe o cruce mai înaltă, au considerat o jignire publică pentru ei înșiși. Cînd au văzut deasupra capului Lui Isus o scîndurică albă, unsă cu ghips, cu o inscripție cu litere negre, în 3 limbi (limba oficială


Ierusalimului, înainte de răstignire. Conform Bibliei, fiecare oprire are un semn distinctiv, rămas pînă în prezent în fiecare dintre cele 14 opriri.
Pentru rememorarea acelui eveniment crucial pentru omenire, propun să „reedităm” acest parcurs, cu ochii minții și cu bătăile inimii ancorate la suferința îndurată de Mîntuitor.
1. Prima oprire a Sfintei Cruci – la Praetoriumul, unde procurorul roman Pilat din Pont îl condamnă pe Isus la moarte;
2. A doua oprire. Isus ridică crucea în spinare. Pilat îl prezintă pe Isus mulțimii: „Ecce Homo!” (Iată Omul!);
3. A treia oprire. Isus cade pentru prima oară sub greutatea crucii;
4. A patra oprire. Isus este oprit de mama Sa. Astăzi, în acel loc e o Biserică armenească. Urmele sandalelor Sfintei Maria au rămas imprimate în criptă;
5. A cincea oprire. Simon din Cirena îl ajută pe Isus la susținerea crucii. Mîna lui Isus a rămas imprimată pe zidul pe care s-a sprijinit;
6. A șasea oprire. Veronica îi șterge chipul Lui Isus, care rămîne imprimat pe batista acesteia;
7. A șaptea oprire. Isus cade pentru a doua oară sub greutatea crucii;
8. A opta oprire. Isus le consolează pe femeile din Ierusalim. Acest popas este marcat de o cruce cu inscripția „NIKA”, ceea ce se traduce „VICTORIE”;
9. A noua oprire. Isus cade pentru a treia oară;
10. A zecea oprire. Isus este dezbrăcat de haine; Ultimele 4 opriri sînt considerate astfel: 11 –(locul răstignirii lui Isus); 12 – (marchează moartea pe cruce); 13 – (Isus este dat jos de pe cruce); 14 – (locul înmormîntării).
După sosirea la locul torturii, crucea lui Isus a fost pusă pe pămînt între cei doi tîlhari, iar la ridicarea pe vericală aceasta s-a înălțat deasupra celor doi, ceea ce avea să creeze nemulțumire în rîndul arhireilor. Chinuit de piroanele bătute în palme și în picioare, Isus a suferit, dar, ca un om iubitor de oameni a gîndit pozitiv despre torționarii Săi, adresîndu-se cu milostenie Tatălui Ceresc: „Părinte, iartă lor, căci nu știu ce fac”. În suferința lui izbăvitoare pentru noi, Isus s-a chinuit în durere, pe cruce, bătut în cuie, de la amiază pînă la apusul soarelui, pînă ce și-a dat duhul.
În această fază a purgatorului prin care a trecut Isus Christos – ca o ultimă pildă dată celor ce l-au pedepsit cu o moarte atît de tragică – Isus (fără vrerea Lui) s-a „răzbunat” pe acești arhirei și farisei. În ce fel? Citiți și analizați cum Dumnezeu leagă și dezleagă întîmplări și cazuri deosebite, dînd pedepse chiar acolo unde acestea

s-a petrecut „furtul” trupului Învățătorului din mormînt?
– latina, greaca circulatorie și aramaica indigenă), pe care scria clar: „Isus Nazariteanul, regele iudeilor”, au luat foc, pur și simplu, și au dat fuga la Pilat să-l implore să ia acea plăcuță care le aducea o nedreaptă jignire, Pilat i-a pus la punct: „Ce am scris, am scris!”, imediat punînd o pază solidă pentru ca inscripția să rămînă la locul ei.
Pilat era bucuros că prin acest gest al său i-a putut umili pe cei din cauza cărora, la urletele și amenințările lor, adoptase de dimineață hotărîrea fatală, potrivnică dorinței și conștiinței acestuia. Apropo de Pilat, cel rămas în Istorie cu stigmatul de ucigaș al Mîntuitorului, cred că merită consemnat încă un act de-al acestuia, raportat la poziția (totuși, oscilantă) față de drama pe care ar fi putut-o opri, dar și de remușcările lui ulterioare. Pe un manuscris foarte vechi, găsit în Abisinia (Etiopia de azi), s-a putut citi un fel de spovedanie a lui Pilat la mormîntul lui Isus Christos, scrisă în limba etiopică și, probabil, fiind de origine coptă (limbă derivată din vechea limbă egipteană). Iată ce spunea Pilat, ca într-o spovedanie: „Eu cred că Tu ai înviat, și Te-ai arătat mie, și cred de asemenea, că Tu, Domnul, nu mă vei judeca, căci eu am lucrat, osîndindu-Te pe Tine, de frica iudeilor. Cred în cuvintele Tale și în faptele pe care le-ai făcut, cînd te aflai între oameni. Tu ai înviat mulți morți”. Ce cuvinte duioase, dar ce bine era dacă nu dădea chiar Pilat prilejul să aibă motiv să le rostească!
Vinerea Mare s-a scurs dominată de crucificarea de pe Golgota. A doua zi, sîmbătă, zi care coincidea cu Paștele, astfel că locul supliciului trebuia curățat, cei trei trebuind să fie înmormîntați. De îngroparea trupului Lui Isus (cu aprobarea lui Pilat) s-a ocupat Iosif Aremateianu, membru al sinedriului, ucenic de taină al Lui Christos, ajutat de un anume Nicodim
Timpul fiind scurt, pregătirea, la fel, mormîntul săpat în stîncă și pregătit pentru Iosif a primit trupul lui Isus învelit într-un giulgiu alb. La înmormîntare mai asistaseră Maria Magdalena și Maria lui Iosif care, după acest act, au plecat acasă cu gîndul să vină a doua zi cu miresme pregătite pentru corpul învățătorului. Speriați să nu-i fure ucenicii trupul spre a se „adeveri” proorocirea cu urcarea la Cer a lui Isus, căpeteniile iudeilor au pus pază militară la mormînt, iar piatra care acoperea intrarea au sigilat-o cu peceți, ferecînd, astfel, trupul neînsuflețit, în incinta inexpugnabilă a mormîntului. În a doua noapte, cînd totul părea normal, străjile aflînduse la post, și nici un ucenic nedînd tîrcoale, cu scopul de a fura cadavrul, de-odată pămîntul se cutremură, spărgînd liniștea din jur, și din cer au coborît doi îngeri îmbrăcați în alb total. Unul dintre ei se apropie și atinse cu mîna piatra de la intrarea în mormînt. Imediat pecetele au sărit de la locul lor și piatra s-a dat la o parte deschizînd mormîntul. Îngroziți de ceea ce văzuseră și trăiseră, străjerii au fugit în Ierusalim, încercînd să-i alarmeze pe conducători. Groaza, panica, incertitudinea și degringolada au pus stăpînire pe chipul și pe atitudinea celor care l-au omorît pe Isus. Bineînțeles, înfricoșați de oprobiul mulțimii dacă aceasta află despre minunea din grotă, mai-marii Iudeii au împrăștiat zvonul precum că ucenicii lui Isus i-au luat trupul pentru a regiza așa-zisa înviere. Numai că, în încercarea lor de a nega realitatea, au omis un lucru esențial, raportat la factorul surpriză: unde erau străjerii înarmați, atunci cînd
Deși Isus le mărturisise ucenicilor săi despre acest moment al Învierii, evenimentul pare a-i fi luat pe neașteptate, atît de brusc și de incitant au trăit adeverirea spuselor iubitului lor Învățător. Așa se face că, astfel cum mărturisesc evangheliștii, ucenicele lui Christos (femeile mironosițe), după ce au petrecut noaptea în plînsete și regrete, dimineața au plecat spre mormînt pentru a unge trupul cu uleiuri purtătoare de mirosuri îmbălsămătoare. În fața mormîntului priviră, speriate, piatra de la intrare prăvălită. Pînă să se dumirească, aproape ca din pămînt, se iviră în fața lor aceleași entități care eliberaseră mormîntul în timpul nopții, și unul dintre vestitorii de bucurie li se adresă: „Nu vă temeți! Pe Isus Nazariteanul cel răstignit căutați? De ce căutați pe Cel viu printre cei morți? Nu este aici, ci s-a sculat. Veniți și vedeți locul unde a fost pus”. Doborîte de emoție și neștiind ce să facă în acel moment unic, femeile mironosițe rămăseseră împietrite. Au fost trezite la realitate de vestitorul ceresc, zicînd: „Mergeți și le spuneți ucenicilor Lui”.
În această ultimă parte a Epopeii Mîntuitorului pe pămînt, desfășurarea evenimentelor are în centrul ei mai multe apariții ale lui Isus în fața ucenicilor săi, începînd cu apariția în fața Mariei Magdalena, chiar la mormînt. Cu lacrimi de emoție și cu bucuria nețărmurită, aceasta se aruncă la picioarele Lui: „Domnul meu învățătorul”, dar Isus răspunse: „Nu te atinge de Mine, că încă nu m-am suit la Tatăl Meu, ci mergi la Frații Mei, și le spune: Mă voi sui la Tatăl Meu și Tatăl vostru, și la Dumnezeul Meu și Dumnezeul vostru”.
După cîteva apariții spectaculoase și întîlniri încărcate de credință, dar și de unele nedumeriri, simțind că se apropie ceasul despărțirii pămîntene, Învățătorul îi scoase pe ucenici din oraș în direcția Vitaniei, pe muntele Eleonului. De pe vîrful înălțimii Isus îmbrățișă cu privirea întinderea orașului: la apus – sclipea albastrul Mării Mediterane; la sud-est, ca într-o căldare, stă nemișcată Marea Moartă; spre răsărit – era Vitania, cu amintirea lui Lazăr înviat din morți; la nord – se ridicau munții Galileei, unde șerpuia apa Iordanului, apă în care Isus a primit Botezul de la premergătorul Său, Ioan Botezătorul... Gînduri și amintiri rămase în urmă, pierdute în scurta viață pămînteană a Învățătorului, care, acum, pregătea actul final al existenței Lui printre noi, întocmai așa precum e scris în Scriptură. Tot cuprinși de nedumerire și de mirare, ucenicii îl sîcîiau cu întrebări puerile, de felul: „Doamne, oare nu în acest timp ai să restabilești Tu împărăția lui Israel?”. Parcă puțin nedumerit de această întrebare, Isus le răspunde în stilul său parabolic, dar franc: „Nu-i treaba voastră a ști anii și termenele pe care Tatăl le-a pus prin stăpînirea Sa. Dar veți primi putere, cînd se va pogorî peste voi Duhul Sfînt. Și-Mi veți fi martori în Ierusalim și în toată Iudeea și Samaria, și chiar pînă la marginea pămîntului”. Zicînd acestea, Isus își încrucișă mîinile, îi binecuvîntă, timp în care începe să se înalțe la Cer, învăluit imediat într-un nor, dispărînd din raza privirilor ucenicilor rămași stană de piatră. Doar un glas de lîngă ei îi smulse din reverie, glasul îngerului: „Ce stați voi și priviți la cer? Isus, Care s-a înălțat de la voi la cer, va veni tot așa cum L-ați văzut mergînd la cer”. Trecuseră 40 de zile de la Praznicul Învierii Domnului, în cea de-a 6-a săptămînă după Paște, cînd, pe Muntele Măslinilor s-a împlinit proorocirea Sfintei Scripturi. După aproape 2.000 de ani, învierea Mîntuitorului și înălțarea Lui la Cer au rămas două repere importante ale credinței noastre Ortodoxe – două repere morale în această mare de răutăți și de păcate prin care trece omenirea. Măcar acum, în Săptămîna Mare, cînd cuvintele Prohodului plutesc peste flacăra pură a lumînărilor din bisericile noastre, să fim mai buni și mai înțelepți, mai darnici și mai înțelegători cu semenii noștri, așteptînd noaptea de 15 spre 16 aprilie, cînd, cu bucurie și cu smerenie, să rostim, ca într-un cor nevăzut: CHRISTOS A ÎNVIAT! ADEVĂRAT A ÎNVIAT!
GEO CIOLCANDin insurgenţi, rebelii se transformă în bandiţi. Iar spaniolii îi cumpără, unul cîte unul. Focul se stinge încet-încet. Frederic Remington trimite un telex ziarului său, New York Journal: „Totul este calm. Nici o tulburare. Doresc să mă întorc“. Primeşte următoarea telegramă de la patronul său: „Vă rog să rămîneţi. Trimiteţi ilustraţiile (fotografia făcea primii paşi, aşa încît corespondenţii de presă îşi însoţeau depeşele de ilustraţii şi gravuri – n.red.). Eu voi furniza războiul“.
Semnatarul, William Randolph Hearst, avea săşi întemeieze imperiul financiar pe acest război. L-a ajutat Joseph Pulitzer, de la World. Numele lui este astăzi cel al celui mai rîvnit premiu de jurnalistică.
Vreme de doi ani, cei doi patroni de ziare au publicat ştiri fabricate despre situaţia din Caraibe. Spaniolii violau călugăriţe. Se petreceau orori de nedescris. Opinia publică americană era indignată. Tirajele sporeau. Nenorocirea din Cuba – ca orice nenorocire – se vindea foarte bine.
La 15 februarie 1898 cuirasatul american Maine explodează în rada portului Havana; mor 260 de marinari. Nici astăzi nu s-a stabilit cu exactitate cauza incidentului. New York Journal şi World ştiu însă cine este de vină. Spaniolii. Isteriei pe care o declanşează i se opune un singur om, preşedintele McKinley. Theodore Roosevelt îl ridiculizează: „Are tot atîta curaj cît un ecler cu ciocolată“. Se apropie alegerile şi a te opune invaziei echivalează cu a rata alegerea sau realegerea în Congres. La 19 aprilie, aleşii naţiei votează războiul. Viitorul preşedinte Theodore Roosevelt participă şi el. În acest război se anunţă reconcilierea între americanii nordişti şi cei sudişti. Celor din urmă li se acordă, pentru prima oară, comanda unor unităţi militare. Pornind contra cubanezilor, fostul general sudist Joe Wheeler îşi trage spada şi urlă: „Asupra yankeilor!“. Războiul din Cuba a fost primul conflict în care au fost prezenţi sute de reporteri.
Tratatul de la Paris, semnat în acelaşi an, pune capăt stăpînirii spaniole şi consacră dominaţia americană. Marele vecin își îndeplinea un vis mai vechi. În 1848 şi 1856 făcuse deja Spaniei oferta de a cumpăra insula. În 1958, cu un an înainte ca Fidel Castro să pună capăt „epocii americane”, marea finanţă de pe Wall Street controla 90% dintre minele, 90% dintre plantaţiile, 80% dintre serviciile publice şi 50% dintre căile ferate ale insulei. Beneficiul realizat de Standard Oil în Cuba depăşeşte nivelul ajutorului acordat de SUA Americii Latine.
Dar perioada americană din istoria insulei nu a însemnat doar atît. La începutul secolului, Sarah Bernhardt şi Caruso apar pe scena de la Teatro Terry. John Dos Pasos şi Ernest Hemingway poposesc adesea în Cuba. George Gershwin îşi află aici inspiraţia pentru Uvertura cubană. Actorii vin des în Cuba. Errol Flyn îi apreciază bordelurile de calitate, iar Gary Cooper, Ava Gardner şi Frank Sinatra proiectează aura lor asupra insulei. Cuba devine sinonimă cu cazinou, tripou, petrecere, rom, desfrîu, paradisul escrocilor şi refugiul geniilor obosite.

Anul-cheie pentru a înţelege cum a fost posibilă, acum 40 ani, răsturnarea regimului patronat de Statele Unite ale Americii este 1938. Atunci, Fulgencio Batista, comandantul şef al armatei cubane, l-a primit pe Meyer Lansky. Acestuia i s-a spus „preşedinte – director general”. Era fondator al „Corporaţiei Crimei”, împreună cu Lucky Liciano, Frank Costello şi Bugsy Siegel. Batista îi cere lui Lansky să relanseze întreprinderile „aflate sub control militar”: două cazinouri şi hipodromul de la Oriental Park. Lansky a reuşit în scurt timp. Batista a ţinut minte şi, în 1952, după ce revenise la putere, l-a numit ministrul turismului. Atunci cînd gangsterul Lucky Luciano a fost expulzat din Statele Unite, de Crăciunul anului 1946, şi-a găsit refugiu în Cuba. În cazinoul Nacional, unde cîntă Frank Sinatra, Lansky şi Luciano hotărăsc asasinarea lui Bugsy, care, rămas la Las Vegas, le toacă banii. Administraţia americană decide că s-a mers prea departe şi cere Havanei să îl expulzeze pe Lucky Luciano, altfel va suspenda ajutorul pe care i-l acordă. Lucky este urcat în primul vapor.
În martie 1952, militarii decid că preşedintele Cubei, Carlos Prio, trebuie înlăturat. Lovitura se desfăşoară fără vărsare de sînge, în dimineaţa zilei de 10 martie. Preşedintele, familia şi asociaţii săi obţin azil la Ambasada mexicană. Cel ales să devină preşedinte este generalul Batista. Astfel, el îşi ajută norocul, căci în perspectiva alegerilor programate pentru iunie 1952 se situa abia pe locul trei. Atunci cînd devenise prima oară preşedinte, în 1940, Batista instituise controlul civil asupra forţelor armate. Speranţele ofiţerilor tineri, care l-au propulsat către putere, că va repeta acţiunea de atunci, au fost înşelate. În 1952, Batista nu se mai bucura de un sprijin popular similar cu cel din 1940. Pentru a păstra puterea, avea nevoie de sprijinul forţelor armate, în special al acelor ofiţeri care ardeau de nerăbdare să culeagă roadele după 12 ani de regim civil.

Printre cei care au protestat contra loviturii de stat din 10 martie 1952 s-a aflat şi un tînăr avocat, Fidel Castro. El a înaintat un protest Curţii de Apel din Havana, cerînd ca Batista să fie trimis în puşcărie, împreună cu acoliţii lui, pentru violarea Constituţiei. Evident, fără vreun ecou. În scurtă vreme, Castro a început să propovăduiască revolta armată. În 1953, cu ocazia centenarului naşterii lui Jose Marti, 165 de tineri au răspuns apelului. Pregătirile începuseră cu cîteva luni înainte, în mare secret. Cei mai mulţi dintre participanţi au aflat detaliile planului cu două zile înainte de declanşarea acţiunii. La ivirea zorilor zilei de 26 iulie 1953, ei au atacat cazarma Moncada. Planul prevedea ca, după cucerirea ei, să împartă arme populaţiei şi să extindă flacăra revoltei. A fost un eşec total. Cei care n-au fost împuşcaţi, au ajuns în închisoare. Dar represiunea sîngeroasă s-a întors împotriva autorilor ei. Figura lui Fidel Castro a căpătat aură de legendă. La proces s-a apărat cu curaj şi a înfăţişat un adevărat program de reformă naţională. A încheiat cu cuvintele: „Condamnaţi-mă, nu are importanţă. Istoria mă va achita!“.
În 1954, Batista a anunţat alegeri generale. Curînd, a devenit evident că procesul electoral era o farsă. Batista a candidat singur. Victoria i-a asigurat o pretenţie de legitimitate pentru puterea sa. A convocat Congresul şi a autorizat cele mai multe partide politice să îşi reia activitatea. În mai 1955, guvernul a decretat o amnistie generală şi a eliberat toţi prizonierii politici. Fidel Castro a reluat imediat activitatea politică, încercînd să găsească metodele pentru o opoziţie paşnică. Dar peste numai două luni a plecat în exil, afirmînd că nu există o altă cale decît insurecţia armată. În august, Mişcarea 26 iulie a înfăţişat cubanezilor un manifest, în care se spunea: „Făcînd declaraţia noastră de credinţă într-o lume mai bună pentru poporul cubanez, noi credem, asemenea lui Marti, că un om sincer nu urmăreşte propriul său avantaj, ci datoria sa şi că singurul om adevărat este cel al cărui vis de azi va fi legea de mîine”. Fidel Castro era figura centrală a Mişcării 26 iulie.
În Mexic, Castro l-a cunoscut pe Che Guevara. Tînărul medic argentinian fusese obligat, la rîndul său să își părăsească țara, din cauza ideilor sale politice. Prima întîlnire dintre cei doi a durat 10 ore. Guevara îşi părăseşte soţia şi copilul şi se alătură lui Castro, pe pluta „Granma“ (Bunicuţa) ce avea să îi ducă în Cuba. Între timp, acasă, Batista încredinţase monopolul maşinilor de poker mecanic cumnatului său. Meyer Lanski controla marile cazinouri. Se părea că nimic nu-i mai stătea în cale, iar veniturile sporeau în fiecare zi. În decembrie 1956, Batista şi Lansky pun piatra de temelie a unui nou cazinou, Riviera, care trebuia să devină bijuteria lanţului de cazinouri cubaneze.
În aceeaşi lună, la 2 decembrie, Fidel, Che Guevara şi partizanii lor debarcă lîngă Santiago de Cuba. Supravieţuiesc primei confruntări cu forţele guvernamentale. Marşul lor spre Havana a progresat în acelaşi ritm cu construcţia cazinoului Riviera.
Mișcarea 26 iulie și-a organizat în zona urbană grupuri de acțiune. În martie 1957, sub conducerea lui Jose Antonio Echevarria, studenţii au atacat palatul prezidenţial, cu intenţia de a-l asasina pe Batista. Au fost la un pas de succes. S-au înmulţit centrele de rezistență în țară.
În Munţii Sierra Maestra, Fidel Castro s-a întîlnit cu Rîul Chibas, fratele fondatorului partidului ortodox, şi cu Felipe Pajos, fost guvernator al Băncii Naţionale. Au dat un comunicat comun prin care cereau: guvern civil provizoriu, restaurarea libertăţilor civile, reforme economice şi sociale, abţinerea altor ţări de a se amesteca în Cuba.
În septembrie se produce o revoltă la baza navală de la Cienfuegos. Anul 1958 aduce noi probleme pentru generalul Batista. Guvernul SUA a impus un embargo asupra livrărilor de armament către ţara lui. Ca orice dictator care trebuie să dispară, Batista devenea tot mai intratabil, cu cît cercul se strîngea în jurul său. A avut şi momente cînd şi-a închipuit că mai putea încă stăpîni situaţia. Greva generală din aprilie a eşuat din cauza măsurilor luate de guvern. Dar în iulie, forţele de opoziţie au semnat un nou acord. Insurecţia armată şi greva generală erau recunoscute drept principalele metode de luptă pentru răsturnarea dictaturii. Raul, fratele lui Fidel Castro, a reuşit să creeze un al doilea front de guerilă în provincia Oriente.
La 10 decembrie 1957, cazinoul Riviera era inaugurat cu un show prezentat de actriţa, cîntăreaţa şi dansatoarea americană Ginger Rogers. A avut un succes nebun, deşi Lansky era de părere că „ştie să dea din fund, dar nu este în stare să scoată o notă“. Peste un an şi 21 de zile, la 31 decembrie 1958, generalul Batista îşi lua zborul către Santo-Domingo. Ducea cu el şi cufărul cu valută. În filmul Naşul, seria a doua, regizorul Coppola reconstituie confuzia de la acel revelion. La 4 ianuarie 1959 intră în Havana Che Guevara. La 8 ianuarie soseşte şi Fidel Castro. Începea o nouă epocă istorică pentru Cuba. Sfîrșit Dor I n m ATEI
Sîntem în Săptămîna Mare și un astfel de articol poate părea nepotrivit, dar veți vedea că nu e chiar așa. Lucifer nu este un personaj popular printre oameni. Este chiar detestat, blamat. Menționarea lui în cultură este regăsită prin cărțile sau filmele de groază, unde el posedă trupurile oamenilor și, în general, face tot felul de lucruri rele. În ultimii 60 de ani, filmele cu monștri sau diavoli au fost puține și urmărite de către un număr restrîns de spectatori, îndeosebi de amatori ai genului. Nu îmi amintesc de oameni care să fi constituit fancluburi sau care să-l popularizeze prin spectacolele de discotecă sau concerte, așa cum se întîmplă acum.
E cert că, în ultimii ani, dracii devin tot mai populari în producțiile de la Hollywood, sub forma unor personaje simpatice, uneori empatice, care fac tot ce pot pentru a-i ajuta pe oameni, așa cum face eroul filmului „Hellboy”. Nu m-au pasionat niciodată aceste producții, de aceea nici nu pot să vă dau prea multe exemple în afara celor deja celebre, cum este, spre exemplu, serialul „Lucifer” de pe Netflix, unde, din ce mi-au spus cei care l-au văzut, dracul e un tip de treabă. Observ că se insistă mult pe ideea transformării dracului în ceva bun, pe împrietenirea lui cu oamenii. Un ultim exemplu în acest sens este un film recent, intitulat „Nefarious”, despre un psihiatru care trebuie să stabilească dacă un bărbat condamnat la moarte, ce pretinde că este posedat de diavol, este apt mental pentru a fi executat.
Revista americană Newsweek scrie despre acest fenomen al satanismului, următoarele: „În noiembrie 2021, «Pew Research» a raportat că 62% dintre adulții americani cred în Iad, față de 58% în 2014, iar cultura pop pare să profite din plin de curiozitatea care înconjoară iadul și locuitorii săi. Diavolul este în centrul atenției în filme, emisiuni TV, podcast-uri și chiar în cărțile pentru copii. Există cluburi satan After School, în timp ce grupurile sataniste au propriile lor diviziuni politice. Există «The Exorcist Files», în care părintele Carlos Martins recreează exorcisme, iar podcast-ul se află în fruntea listei celor mai populare la categoria «spiritualitate». (ce ironic, nu? Lucrul cu diavolul atrage oamenii mai mult decît o slujbă religioasă) Numai pe Netflix există zeci de titluri care tratează demonii infernali, printre care «Warrior Nun», «Devil in Ohio», «The Bastard Son & the Devil Himself» și «Lucifer», în care conducătorul Iadului conduce un piano bar în California.
Din anul 1973, cînd filmul «Exorcistul» era un fenomen cultural pe cale de a deveni primul film de groază care a cîștigat o nominalizare la Oscar, satan nu a mai fost un subiect atît de popular. Există chiar și o Carte a demonilor pentru copii; exemplu de pasaj: «Invocarea demonilor nu a fost niciodată atît de distractivă!» (cum să fie distractiv să invoci demonii?). Deși nu există date de sondare a opiniei publice care să sugereze o creștere a satanismului, Martins, gazda podcast-ului «The Exorcist Files», observă că mai mulți americani deschid ușa pentru ca satana să intre în viața lor. Oamenii tînjesc după spiritualitate, spune Martins, dar un sondaj Gallup din 2021 a remarcat că, pentru prima dată în istoria SUA, mai puțin de jumătate dintre americani erau membri ai unei biserici, sinagogi sau moschei. Pentru a umple golul, mulți îmbrățișează «o respingere a obiceiurilor sociale primite și a normelor de comportament așteptate, în favoarea îmbrățișării plăcerii în primul rînd, urmărind sentimente și experiențe intense», a declarat Martins pentru «Newsweek»”.
Menționez faptul că în textul original numele lui satan era scris cu literă mare, în vreme ce numele lui Dumnezeu apare în 9 cazuri din 10, scris cu literă mică, de unde deduc că oamenilor li se induce ideea că dracii sînt mai importanți decît Creatorul celor văzute și nevăzute. Ca să corectez acest lucru, în acest articol veți găsi numele diavolului scris cu literă mică, în mod intenționat.
Prostesc mi se pare și motivul pentru care oamenii ce tînjesc după spiritualitate resping apropierea de Dumnezeu, îndreptîndu-se spre diavol fiindcă acesta le
Vasile Bănescu (BOR): „Progresismul ideologic poate conduce inclusiv la crimă” promite „plăcere, sentimente și experiențe intense”. Ce nu știu ei este faptul că după atingerea plăcerilor intense (spre exemplu, cele produse de vicii) vin amărăciunea, durerea și pustiirea sufletului. Plăcerea oferită de draci nu are cum să fie una completă și aducătoare de liniște, astfel încît oamenii repetă activitatea aducătoare de plăcere la nesfîrșit pînă cad în depresie și ajung în iadul acela în care, iată, cred 62% dintre adulții americani.
Chuck Konzelman, care a co-scris și a regizat „Nefarious” împreună cu Cary Solomon, a declarat pentru Newsweek următoarele: „Curiozitatea cu privire la demoni este periculoasă, iar amestecul în ocultism este o nebunie. Astfel, filmul servește ca un avertisment cu privire la ceea ce se poate întîmpla atunci cînd cineva îl invită pe satan în viața lui, fie prin fapte rele sau prin îmbrățișarea unei simple table Ouija. Cînd iei unul, spui «da» unei posesiuni spirituale voluntare. Intenția ta este aproape sigur temporară, dar demonii vor dori să te păstreze pentru ei”. Să înțeleg că cetățenii americani sînt atît de neduși la biserică încît nu știu ce li se poate întîmpla dacă îl invită pe drac în viața lor?
Mai departe. „Dincolo de filme, emisiuni TV, cărți și o grămadă de jocuri video care prezintă diavolul, există Templul satanic, care se laudă că este singura organizație religioasă recunoscută ca biserică de către IRS și Sistemul Tribunalului Federal. Convenția sa anuală, numită satanCon, este programată în perioada 28-30 aprilie la Boston și a fost vîndută cu cel puțin șase săptămîni înainte. Exemplele de prezentări includ «Păcatele cărnii: satanismul și plăcerea de sine» și «Hellbillies: satanismul vizibil în America rurală».
Grupul acordă «Bursele Avocatului diavolului» în valoare de 666 USD (în mod tradițional, 666 este marca diavolului). Unul dintre destinatarii din acest an a fost un copil de școală elementară, care a scris cel mai bun eseu pe tema «Ce urăști cel mai mult la școală?». Templul satanic, fondat în 2012, strînge și bani pentru avorturi și a introdus «The satanic Abortion Ritual» pentru a revendica libertatea religioasă în statele care restrîng procedura acum, cînd Roe v. Wade a fost anulat. Are sediul în Salem, Massachusetts și se mîndrește cu 54 de congregații la nivel național. Poate cel mai controversat: îi ajută pe copii să deschidă After School satan Clubs. Într-un district din Pennsylvania, părinții au organizat o ședință a consiliului școlar pentru a se plînge de un club propus satan After School, iar consiliul a votat împotriva ideii 8-1, a informat «ABC News» anul trecut.
Biserica lui satana, pe de altă parte, precede Templul Satanic cu 47 de ani și predică faptul că sataniștii sînt «propriii lor zei». Una dintre cele nouă declarații satanice spune că «satana reprezintă toate așa-numitele păcate, deoarece toate duc la satisfacție fizică, mentală sau emoțională!».
Nici Templul satanic, nici Biserica lui satan nu promovează închinarea unui om la un diavol existent, deoarece asta ar echivala cu recunoașterea că există zeități și ambele grupuri susțin contrariul. «Un satan adevărat este o prostie creștină», adăugînd că termenul tradus din ebraică înseamnă «adversar, unul care stă în opoziție. Așa sîntem noi», a explicat Harris. De fapt, în 1975, cînd un membru de rang înalt al Bisericii satanei, pe nume Michael Angelo Aquino, a susținut că un diavol i-a dezvăluit adevărata sa identitate, numindu-se «set», a fost exclus din organizație, așa că a lansat Templul lui set. Templul lui set nu a răspuns solicitării de comentarii a «Newsweek», deși site-ul său îl descrie pe set drept «cea mai veche formă cunoscută a prințului întunericului», vorbind despre «Calea stîngii» de a fi propriul tău zeu, mai degrabă decît rugîndu-te unuia «imaginar». Site-ul promovează magia neagră, dar avertizează că cineva nu poate învăța meșteșugul decît dacă respinge pe deplin să fie «guvernat de emoții animale, cum ar fi rușinea, frica sau dorința de acceptare socială»”.
Nu v-am dat aceste lungi citate drăcești acum, în Săptămîna Mare, ca să vă smintesc, ci ca să vedeți că tot ceea ce spune Biserica despre draci e adevărat Acesta este motivul pentru care am îngroșat anumite
Purtătorul de cuvînt al Patriarhiei, Vasile Bănescu, a comentat într-o postare pe Facebook cazul profesoarei atacate cu cuţitul de elev, la Colegiul ,,Ion Creangă” din Capitală, afirmînd că progresismul ideologic care ,,mîngîie pe creştet lenea, prostia, incultura, indisciplina, depravarea precoce, permisivitatea totală şi care promovează intens dizolvarea autorităţii de orice tip, progresism atît de larg şi adînc prizat de (i)responsabilii din fruntea «Învăţămîntului» recent, poate conduce inclusiv la crimă”.
„O profesoară de la un liceu din București a fost atacată cu un cuțit de un elev căruia nu i-a venit să creadă că aceasta are tupeul să dea clasei un test neanunțat, neprofețit de nimeni. Cînd totuși s-a dezmeticit din neîncrederea inițial paralizantă, elevul a luat simultan cuțitul și promptă atitudine. Lucrurile ajunseseră mult prea departe și deveniseră intolerabile pentru cineva cu atîtea drepturi și nici o responsabilitate.
Progresismul ideologic care nu are nici o legătură cu progresul real în vreun domeniu, progresismul anticreștin care aruncă în aer valorile fondatoare ale paradigmei educației fertile intelectual și moral, progresism care mîngîie pe creștet lenea, prostia, incultura, indisciplina, depravarea precoce, permisivitatea totală și care promovează intens dizolvarea autorității de orice tip, progresism atît de larg și adînc prizat de (i)responsabilii din fruntea «Învățămîntului» recent, poate conduce inclusiv la crimă. Nu și la pedeapsă.
Ulterior crima sau tentativa ei eșuată vor fi totdeauna scuzate de nuanțele nesfîrșite ale unui context mereu favorabil agresorului.
Imperativul amoral al progresismului? Să fim toleranți, să fim incluzivi! Cu tot și cu toate, oricît de toxic s-ar dovedi acest lucru pentru organismul societății, pentru fiecare în parte. Nu contează. Planetei să-i fie bine!”, a scris Bănescu pe Facebook.
DCNE w S.RO
cuvinte sau propoziții, cum este, spre exemplu, aceasta: „Biserica lui satana predică faptul că sataniștii sînt proprii lor zei”. Adică exact ceea ce ne spune doctrina progresistă și neo-marxistă: că oamenii sînt proprii lor stăpîni și, din acest motiv, pot face ce vor. Am vrut apoi să vedeți că acești adoratori ai lui satan nu recunosc nici ei existența diavolului, fiindcă tocmai asta vrea cel necurat: să nu crezi că există, ca să-și poată face mendrele mai bine, lucru de care ne avertizează dintotdeauna și preoții.
Rău este că, prin filme și cărți, spectacole sau articole de ziar, prin amăgirea oamenilor cu plăceri și emoții intense, dracii îi duc la pierzanie pe cei mai mulți dintre noi. Poate tocmai de aceea se inoculează tinerelor generații lenea, egoismul, căutarea plăcerii cu orice preț, îndepărtarea de Dumnezeu și de Biserica Lui, ce sînt prezentate ca fiind ceva învechit, inutil și mai ales fals.
Acum, în Săptămîna Mare, dar și după aceea, avem ocazia să-i ajutăm pe cei îndepărtați de Dumnezeu să-L găsească și să se întoarcă la El. Domnul nu vrea moartea păcătosului, ci îndreptarea lui. Să stăm bine pe picioarele noastre, să avem mintea limpede și să ne ferim de tot ceea ce ne-ar putea îndrepta pe drumul larg și strălucitor care duce spre iad. Putem face asta în multe feluri, dar cel mai ușor prin rugăciune neîncetată, așa cum ne sfătuia și Apostolul Pavel. Una din rugăciunile cele mai simple și mai eficiente este cea numită „Rugăciunea Inimii”, ce poate fi spusă permanent și oriunde ne-am afla: „Isuse Christoase, Fiul lui Dumnezeu, miluiește-mă pe mine păcătosul”. Vă doresc un Paște Fericit, liniștit, cu pace. Să ne amintim că Isus Christos s-a întrupat, a suferit, a murit, dar mai ales a Înviat pentru noi. Christos a înviat! NICU MARIUS MARIN, antreprenor Hor ECA
Stimați domni, De cîte ori vă văd în geamul televizorului vorbind despre războiul fratricid din Ucraina, am sentimentul că asist la colocviul unor peștișori de acvariu care, cu aplomb și seninătate, descriu lupta cașaloților din adîncul oceanelor. Aidoma copiilor noștri care pe vremuri își luau porția de desene animate bulgărești, am devenit și noi dependenți de „leka noci“-ul dumneavoastră.
Servindu-ne seară de seară cîte o linguriță de slavă ucraineană, ne-ați băgat într-o dulce adormire că armata rusă ar fi pe butuci, condusă de un damblagiu cu un picior în groapă căruia, din trei în trei săptămîni, îi prevesteați parastasul. Și uite așa, sastisiți de coliva iluzorie a altora, ne-am trezit după un an de zile pritocind una de-a noastră, făcută din grîu ucrainean.
Eu înțeleg că sînteți generali NATO, carevasăzică de partea binelui, dar normal ar fi fost să nu uitați că sînteți în primul rînd generali români, adică de partea binelui românesc, și să reacționați cînd cei pe care nu i-am lăsat să moară nu ne lasă să trăim. Fiindcă nu v-am auzit vorbind nici despre drama fermierilor români striviți de revărsarea necontrolată a puhoaielor de grîu ucrainean, mînărit în porturile românești, nici despre deversarea apelor Deltei în canalul Bîstroe, adîncit ilegal și care, conform principiului vaselor comunicante al lui Blaise Pascal, va provoca o mare
tragedie în vară cînd scad de obicei apele Dunării. Și dacă încă ne jucăm de-a măsuratul canalelor ucrainene, ce-ar fi, domnilor generali, să cerem aprobare de la Dumnezeu să măsurăm adîncimile sufletești ale președintelui Klaus Iohannis, să vedem dacă nu cumva i s-a colmatat canalul de comunicare cu poporul român?
Eu v-am înțeles cînd v-ați exprimat compasiunea asupra avionului american fără pilot pe care a făcut pipi de frică un Suhoi rusesc, dar mă așteptam să plîngeți și de mila avioanelor ruginite cumpărate la mîna a doua de Klaus Iohannis cu cîteva miliarde de dolari pe care le vor plăti nepoții și strănepoții noștri. Și n-aș fi vrut să rămîneți indiferenți la stropirea cu kerosen falsificat a flotilei militare de către colegii dumneavoastră de la manutanță căci e cam jenant să stați de veghe la catafalcul anchetei care, din cîte bag seama, a murit chiar din clipa nașterii.
Domniile-voastre, care țineți loc de societate civilă într-o Românie condusă, vai, de un general, ar trebui să nu mai dați la pește cu mămăligă în Marea Neagră, ci să-i trageți de mînecă și să-i treziți la realitate pe politicienii noștri care nu pricep că al treilea război mondial va purta pseudonimul Apocalipsei.
Dansul pe marginea prăpastiei al președintelui Biden care insistă să aducă pacea cu ajutorul războiului n-a făcut altceva decît să arunce în brațele Chinei o Rusie rănită. Or, mistrețului rănit îi dispare frica de moarte
Manifestul arhiepiscopului Percă: „Europa de Vest a întors demult spatele creştinismului”
Arhiepiscopul-mitropolit romano-catolic de Bucureşti, Aurel Percă, a făcut duminică un apel la apărarea „valorilor religioase şi naţionale”, afirmînd că Europa de Vest „a întors demult spatele creştinismului”, iar liderii Uniunii Europene „au adoptat o ideologie de umanism ateu şi materialist, pe care o impun popoarelor”.
„De 16 ani România face parte din Uniunea Europeană. La 1 ianuarie 2007, cu toţii ne-am bucurat că facem parte din Uniunea Europeană. Am sperat că Europa secularizată va prelua spiritul creştin din ţările postcomuniste, în special ţările catolice, mai întîi, şi apoi din ţările ortodoxe, România, Bulgaria. Cînd Biserica din ţările din estul Europei a stîrnit temeri legate de secularismul şi ateismul din ţările occidentale, euro-entuziaştii ne-au spus că se deschidea o mare oportunitate pentru aceste ţări, inclusiv pentru România, de a introduce valorile creştine în Uniunea Europeană. După cîţiva ani, a devenit evident că echipele noastre guvernamentale cedau în faţa influenţei liderilor Uniunii Europene, care promovau un sistem de valori fără Dumnezeu”, a spus ÎPS Percă în predica de Paşti, rostită la Catedrala Sfîntul Iosif, citat de Agerpres
Conducătorii Uniunii Europene cred că Dumnezeu nu mai este necesar pentru ca ei să creeze un singur stat pe continentul nostru, consideră înaltul ierarh romano-catolic. „Europa de Vest a întors demult
spatele creştinismului. În şcolile olandeze sau franceze, de exemplu, este prezentată de mult timp o viziune falsă asupra istoriei. Acolo se învaţă că civilizaţia a apărut în Europa doar ca urmare a Revoluţiei Franceze – la sfîrşitul Secolului al XVIII-lea – şi că ceea ce a fost înainte a fost doar întuneric şi înapoiere. Şi să ne gîndim şi cei care, poate, sînteţi în sistemul de învăţămînt, cum încearcă acum cărţile de istorie să prezinte creştinismul sau apariţia creştinismului. Totuşi acest lucru este complet fals; la urma urmei, ştim foarte bine că toată ştiinţa s-a născut şi s-a dezvoltat în universităţile catolice medievale. Biserica a învăţat Europa să citească şi să scrie. A devenit promotorul nu numai al ştiinţei şi al culturii, ci şi al ospitalităţii şi al grijii faţă de cei bolnavi, săraci şi persoane fără adăpost”, a arătat arhiepiscopul.
și, în loc să fugă și să supraviețuiască, se întoarce împotriva vînătorului să-i ronțăie pușca.
Eu sînt un mare admirator al miracolului chinezesc din Secolul XXI, dar e de ajuns să vezi fotografia de grup a liderilor chinezi, toți în uniforme militare, bătrîni și tineri, gata să schimbe fața lumii cu orice preț, și te cutremuri.
Oare zîmbetul satisfăcut al lui Kim Jong-un, care și-a scos fetița în Orășelul Copiilor ca să-i arate jucăriile sale cu focoase nucleare, nu vă dă fiori pe șira spinării?! Oare cucoanele acelea bete de fericire de la Bruxelles, care au îmboldit-o pe domnișoara Maia Sandu să zgîndere dulăii pravoslavnici printre stinghiile gardului, nu v-au amintit de efectele cîntecului războinic de odinioară, fredonat cu inconștiență de ostașii români morți la Cotul Donului:
„Sus, pe malul Prutului, paște calul rusului, calul paște și nechează, rusul plînge și oftează. Stai, rusule, nu ofta, că Moldova nu-i a ta, că din pielea lui Stalin facem cizme la Berlin, din pielea lui Molotov facem tocuri la pantof“?
Urmarea acelui cîntecel a fost că, vreme de cincizeci de ani, și-au făcut ei cizme din pielea noastră. Sincer să fiu, domnilor generali, eu aș prefera să ne plimbăm desculți prin Grădina Maicii Domnului decît să-l mai cîntăm încă o dată.
MIRCEA DINESCU (Catavencii.ro)
cîteva: mitul egalităţii căsătoriei tradiţionale. Nu mai este bărbat, nu mai este femeie, mitul credinţei în omnipotenţa ştiinţei. Prin ştiinţă rezolvăm toate. Se spune că ştiinţa ne va salva pe noi şi lumea din jurul nostru. Şi vedem, ştiinţa a dus la încălzirea climei, la atîtea lucruri care se întîmplă ca urmare a acestor «progrese» ale ştiinţei. Pentru că lumea spune: de astăzi nu mai este nevoie de Dumnezeu. Omul este capabil să se salveze singur”, a spus înaltul ierarh.

El a atras atenţia asupra „fenomenului îngrijorător” al „pierderii identităţii naţionale”, susţinînd că acest lucru este „impus de sus”. „Un alt fenomen îngrijorător, care poate fi observat în Europa de Vest, este faptul că ţările occidentale îşi pierd identitatea naţională. Acest proces are loc nu pentru că oamenii înşişi doresc acest lucru, ci pentru că le este impus de sus. Constituţia Europeană, nu constituţia ţării proprii. (…) Parlamentele naţionale pot vota şi pot decide asupra unor chestiuni complet secundare. Deciziile cu adevărat importante sînt luate de organisme restrînse, sînt luate la Bruxelles, cum se spune. Sf. Ioan Paul al II-lea i-a întrebat pe nişte studenţi olandezi în anii 1980 cum se face că pînă în anii 1950 Olanda era ţara care trimitea cei mai mulţi misionari, iar acum este o ţară în care credinţa este aproape absentă? Cu ochiul liber se poate vedea că liderii Uniunii Europene au adoptat o ideologie de umanism ateu şi materialist, pe care o impun tot mai mult popoarelor”, a susţinut ÎPS Percă. Arhiepiscopul a explicat că „această nouă ideologie este un fel de pseudo-religie bazată pe mituri”. „Care sînt aceste mituri? Pentru a numi
Un alt mit, a arătat ÎPS Percă, este „predicarea negării sufletului uman şi a negării conştiinţei, promovînd astfel o falsă imagine a omului”. „Iar acest lucru are consecinţe fatale în toate domeniile culturii şi ale vieţii socio-politice şi economice. Doar observaţi cît de perversă este această introducere în şcoli, unde se scoate religia, unde se învaţă tot felul de teorii gender şi tot felul de lucruri, vedem cum drogurile proliferează în şcoli, crimele care încep să apară între elevi… Se scoate religia, îl scoatem pe Dumnezeu şi iată efectele. În acest sens, se vehiculează teza că vinovăţia este o nevroză, o boală psihică de care trebuie să te vindeci. Apoi, mitul lipsei de păcat a omului este, aşadar, o ficţiune. Relativismul: poţi să faci totul, pentru că este permis. S-a raportat în Occident că mulţi psihiatri şi psihologi, care au fost credincioşi în tinereţe, şi-au pierdut credinţa ca urmare a propagării acestor mituri”, a spus Percă. Arhiepiscopul-mitropolit romano-catolic de Bucureşti a chemat la apărarea „valorile noastre religioase şi naţionale”, a „credinţei şi prezenţei lui Cristos în viaţa publică”. „Nu vreau să fac o analiză nici politică, nici socială. Am voit să spun aceste lucruri într-un context în care, iată, creştinismul parcă devine ceva secundar, tangenţial şi, mai ales, lipseşte motorul care să pună în mişcare conştiinţele noastre. Dragi fraţi şi surori, sîntem conştienţi de faptul că aceste tendinţe pătrund în ţara noastră. Asistăm la o intensificare a luptei împotriva Bisericii. Trebuie să ne apărăm valorile noastre religioase şi naţionale. Trebuie să ne apărăm pentru că sîntem ameninţaţi. Din fericire, există multe semne pozitive în societatea noastră şi acest lucru ne ridică speranţa că vom putea să apărăm credinţa şi îl vom putea apăra pe Christos, care să fie prezent mai departe în societate. Lucrul esenţial este să nu ne fie frică să fim martorii lui Cristos cel Înviat!”, a mai spus ÎPS Aurel Percă.
CoTIDIAnUL.ro
Un primar dezamăgit (2)
În 1944, Gestapo a început o vînătoare de personalități marcante din Republica Weimar. La sfîrşitul războiului a mai fost un val de represiuni. Adenauer a fost arestat și sub suspiciunea de activități antistatale și a fost amenințat că va fi trimis la Buchenwald, dar a evitat o astfel de soartă. Biografii mărturisesc că un fost aliat din Partidul de Centru, la acea vreme maiorul Wehrmacht Fritz Schliebusch, l-a ajutat în acest sens. Dar poliția a reușit să-l găsească pe fugar. Adenauer și salvatorul său au fost trimiși într-o tabără din Köln, unde Schliebusch a murit de tifos. Dar Adenauer a fost din nou norocos: nu a stat mult timp după gratii, în parte datorită eforturilor fiului său Max, locotenent de la Wehrmacht. În plus, armata se grăbea să se retragă din Köln. Odată cu sosirea aliaților, Adenauer a fost numit mai întîi consilier al administrației ocupației, iar apoi reinstalat în funcție. Astfel a început un nou capitol în viața lui.

mult mai multe voturi, iar patru ani mai tîrziu au obținut majoritatea absolută. Și existau motive pentru un astfel de sprijin popular. Primul cancelar a jucat un rol important în reconstruirea economiei germane după război; în ciuda idealismului creștin al CDU și a criticilor socialiștilor pentru materialismul lor marxist, cancelarul a căutat să facă cît mai mult posibil pentru bunăstarea materială a Germaniei. Planul Marshall l-a ajutat în acest sens, program care a presupus alocarea de bani nu numai aliaților din coaliția anti-Hitler care au suferit de pe urma războiului, ci și Germaniei distruse.
– să accentueze aspectele negative, să descurajeze cu pretenții neașteptate, chiar să devină intruziv. Cu toate acestea, biografii subliniază că, oricît de dur a fost cancelarul în controversă, a criticat pe toată lumea doar în privat și a evitat să bîrfească. Viața politică a Germaniei postbelice ar fi putut fi mult mai tulbure – este suficient să spunem că, în timpul vieții sale, au fost publicate aproximativ 22 de mii de caricaturi ale „bătrînului Konrad”. Nici opinia publică, nici intrigile oponenților politici nu l-au abătut pe cancelar de la parcursul său. În discursurile publice, raționalitatea argumentelor sale a fost completată de simplitatea formulării. Un astfel de discurs, perfect inteligibil, a atras încrederea alegătorilor.

Democrați, creștini!
Britanicii și americanii care au fost în contact cu Konrad Adenauer au remarcat faptul că el nu era în mod clar un susținător al ocupării pămînturilor sale natale și că merita să fie tratat cu atenție. Chiar nu-i plăceau străinii și nu era dornic să lucreze sub controlul lor. Cu toate acestea, a văzut Köln zăcînd în ruine și a înțeles că era puțin probabil ca cineva să poată reface orașul mai bine decît el. La scurt timp, Adenauer a fost din nou înlăturat din post și catalogat drept un aliat nu foarte de încredere al învingătorilor. Dar nici această rușine, nici vîrsta care se apropia de 70 de ani nu l-au împiedicat să-și continue activitatea.
După cum subliniază istoricul Aleksey Filitov, dimpotrivă, demisia sa i-a adus avantaje politice, altfel în ochii germanilor ar fi arătat ca un protejat al ocupanților. Chiar și atunci, cu mult înainte ca germanilor să li se permită să formeze din nou organizații politice, Adenauer a început munca de revigorare a Partidului de Centru. Sub masca organizațiilor religioase, în țară au început să apară celule ale viitoarei Uniuni Creștin Democrate (CDU). De dragul unirii organizațiilor disparate într-un partid și datorită mobilizării politice a cetățenilor, Adenauer a călătorit personal prin provincia Rinului rostind discursuri înflăcărate.
CDU și principalul său adversar, Partidul Social Democrat din Germania (SPD), au fost uniți de antipatia față de formele totalitare de guvernare. Dar au fost, totodată, dezbinați de puternicele dezacorduri asupra unor chestiuni foarte importante: creștindemocrații erau idealiști și susținătorii unei economii de piață, în timp ce socialiștii visau la socializarea industriei și la planul de stat. Deși administrația de ocupație britanică a fost de partea acestora din urmă, CDU a înregistrat cele mai bune rezultate la primele alegeri pentru Landtag (parlamentul local).
Cînd forțele aliate au creat un nou stat, RFG, pe locul zonelor de ocupație, succesul CDU s-a repetat la alegerile pentru primul său parlament. Oponenții politici au spus că este timpul ca liderul creștin, în vîrstă de 73 de ani, să se retragă. Este puțin probabil că rivalii săi și-ar fi imaginat că Adenauer va lucra încă 14 ani înainte de a se pensiona.
În 1949, după victoria Partidului Creștin la alegerile parlamentare, Adenauer a devenit primul cancelar al RFG și adevăratul tată al noului stat german. Deja la următoarele alegeri, creștin-democrații au primit
Trebuie spus că toate unitățile de producție ale celui de-al Treilea Reich au înregistrat pagube ireparabile: multe fabrici s-au oprit nu din cauza economiei, ci din cauza prăbușirii sistemului de conducere și a relațiilor industriale. Cu toate acestea, aceste capacități industriale trebuiau utilizate în mod corespunzător. Pentru aceasta, Adenauer avea mulți ani de experiență managerială. Reforme financiare bine gîndite și o politică fiscală care a ținut cont nu numai de interesele giganților industriali, ci și ale micilor întreprinderi și ale clasei de mijloc, fapte caare au contribuit la gestionarea corectă a ajutorului extern și a resurselor interne. Iar rezultatele nu au întîrziat să apară – economia s-a revigorat treptat. Planul Marshall a făcut posibilă restabilirea rapidă a infrastructurii și demararea lucrărilor marilor fabrici, iar datorită împrumuturilor accesibile și a unui sistem fiscal flexibil, în Germania au apărut tot mai multe industrii mici și întreprinderi de familie care au contribuit la bunăstarea populației. Printre altele, noul stat nu a trebuit să cheltuiască bani pe armată – în primii ani după înfrîngerea din război, Aliații nu au permis Germaniei să aibă propriile forțe armate.
După cum explică președintele Societății Bismarck din Moscova, Mihail Golovanov, Adenauer a reușit să stabilească vectorii dezvoltării țării, care sînt implementați în mod constant pînă în prezent. Nu a fost ușor, dar încrezător și clar, el a stabilit principiile ordinii germane: o economie de piață cu orientare socială. Un astfel de sistem punea, fără echivoc, asupra cetățenilor apți de muncă responsabilitatea pentru cei care încetaseră să lucreze. Adenauer, care a fost numit „Bătrînul” nu numai de adversarii politici, ci și de susținători, avea grijă de pensionarii germani și, chiar cu propria înfățișare, le reamintea aliaților și adversarilor că, mai devreme sau mai tîrziu, toată lumea va îmbătrîni. El nu a folosit, în mod fundamental, termenii „capitalism” și „socialism”: în opinia sa, o astfel de opoziție este o caracteristică a trecutului, iar societatea modernă este reconstruită spre un nou scop – o creștere constantă a nivelului de trai al tuturor segmentelor populația.
În ciuda dragostei sale pentru democrație, Adenauer a rămas un om al vechii școli imperiale, ceea ce însemna că nu era loc pentru sentimentalism în activitatea sa. Se știe că era foarte ferm în convingeri și că, într-o dispută parlamentară, era gata să-și distrugă retoric adversarul

Conducerea fermă și imperturbabilă a lui Adenauer a permis CDU să urmeze o politică consecventă timp de mulți ani. Konrad Adenauer a devenit părintele nu numai al Constituției Republicii Federale Germania, care este în vigoare pînă în prezent, ci și al structurii noii republici germane.
În anii de după război, el era îngrijorat de probleme mai stringente: după procesele de la Nürnberg, Germania trebuia să facă față cumva moștenirii naziste. Nikolai Epple, în cartea sa „An Inconvenient Past”, subliniază că la acea vreme germanii, în cea mai mare parte, nu erau pregătiți să-și asume vina colectivă pentru crimele naziștilor și responsabilitatea aparatului de stat. Considerentele pragmatice au jucat un rol major: Adenauer a semnat de două ori un ordin de amnistie pentru membrii NSDAP și, deși se vorbea deja despre vinovăția întregului popor german, în toți anii conducerii sale, foștii naziști au constituit un procent remarcabil din angajaţii organelor de stat. Discuția despre vinovăția colectivă nu a început cu adevărat sub Adenauer – pocăința germană s-a manifestat îndeosebi spre sfîrșitul anilor 1960, dar era ferm convins că statul trebuie să-și asume responsabilitatea pentru cele întîmplate.

În ciuda faptului că mulți germani nu au susținut plata despăgubirilor către Israel, cancelarul a „împins” decizia privind o despăgubire mare – de peste trei miliarde de mărci – pentru statul evreu. În același timp, cu aprobarea sa, a început o anchetă mai amănunțită a crimelor de război, o proiecție masivă de filme despre regimul nazist și curățarea teritoriului de lagărele de concentrare, producții de care erau atrași tineri din toată Germania.
În 1955, Adenauer a reușit să rezolve o altă problemă importantă pentru germani – miile de prizonieri de război care pînă atunci se aflau în lagărele de prizonieri de război din URSS. Istoricul Alexei Filitov își amintește un fapt puțin cunoscut: cancelarul german și președintele Consiliului de Miniștri al URSS Nikolai Bulganin se cunoșteau deja la momentul întîlnirii de la Moscova. La începutul anilor 1930, Bulganin, pe atunci șeful Consiliului Local al Moscovei, a venit la Köln pentru a face schimb de experiență cu primarul orașului. Adenauer și-a amintit de el ca fiind un „om politic talentat” și un „tip drăguț” în general. Nu este clar dacă această amiciție a jucat un rol în acele negocieri de la Moscova, dar prizonierii au fost returnați în Germania. (va urma) N.K.
Conform statisticilor medicale, 95% din durerile de spate au o cauză principală neelucidată. Una din trei persoane suferă de dureri de spate, dar în practica zilnică întîlnim chiar și copii ce acuză dureri de coloană. Este necesar să precizez că deosebim durerile de spate acute (sub șase săptămîni), subacute (șase - douăsprezece săptămîni) și cele cronicizate (sub douăsprezece săptămîni). După infecțiile aparatului respirator, acestea sînt cel mai des întîlnite. Un semnal de alarmă este numărul în creștere al durerilor de spate la copii, deoarece, în urmă cu cîțiva ani, ele afectau doar persoanele cu vîrste cuprinse între 50 și 70 de ani.
Cauzele durerilor de spate sînt multiple, fiind provocate, îndeosebi, de accidente și modificări degenerative. Ruperea discurilor, stenozele spinale, maladia Scheuermann sau Morbus Bechterw sau chiar tumorile pot, de asemenea, provoca mari dureri de spate. În 95% din cazuri, medicina energoinformațională depistează blocaje în zona cervicală, cu iradierea durerii spre umeri (adesea pînă la coate) chiar și cu pierderi de echilibru și dureri de cap. De multe ori, cauza acestora se găsește în diferite probleme interne precum: pleurita, ulcerul duodenal, durerile musculare,
Falsul „fiu rătăcitor“ (2)
Dar aici nimeni nu l-a crezut. „Dacă sînteţi întradevăr Sir Roger, atunci v-aţi schimbat dintr-un cal de curse într-un cal de căruţă!”, îl luă peste picior fierarul satului, evidenţiind că Sir Roger, cîntărind mai puţin de 57 kg, avea o faţă lungă, palidă şi păr drept, brunet. Orton, care avea păr ondulat şi o faţă mare, rotundă, cîntărea 153 kg.
Totuşi, acum, la prima lor întîlnire în întunericul camerei de hotel (îi spusese că este bolnav), bătrîna doamnă l-a acceptat fără comentarii, în ciuda gafelor „fiului“ ei şi refuzului lui Henri Chatillon, fostul tutore al lui Roger, de a-l crede. Încurajat de alocaţia anuală de 1000 de lire fixată de Henriette, Arthur a pornit o acţiune legală prin care pretindea moştenirea proprietăţilor Tichborne. În declaraţia scrisă sub jurămînt, spunea că fusese salvat de pe vasul Bella de o altă navă, australiană, cu numele Osprey.
Cazul său părea absurd. În afară de faptul că nu semăna deloc cu Roger şi cîntărea aproape de trei ori mai mult decît acesta, nu putea vorbi în limba franceză şi nici nu-şi amintea numele prietenilor din copilărie sau ale profesorilor de la Stonyhurst. Chiar şi aşa, citind tot ce găsea la îndemînă despre familia Tichborne și cu mult calm caracteristic unui escroc din naştere, i-a convins pe mulţi că este bărbatul care pretindea, între cei păcăliţi se aflau avocatul de familie, Robert Hopkin, şi vechiul prieten al lui Roger, Vincent Gosport – pînă cînd acesta l-a întrebat pe Orton ce conţinea scrisoarea pe care Roger i-o lăsase ca să o transmită Katherinei. Cînd Orton a răspuns că nu îşi duce aminte, Gosport a ajuns la concluzia că în faţa lui se află un impostor.
În 1871, la patru ani de zile după audierile preliminare, a început procesul în sine. Deşi cazul îşi pierduse din forţă în urma decesului brusc al doamnei Tichburne, Orton a apărut cu peste o sută de martori, inclusiv mulţi foşti ofiţeri din Garda Al Șaselea Dragon. Pe de altă parte, şaptesprezece membri ai familiei Tichborne şi prieteni ai acestora l-au acuzat de fraudă. Printre aceştia se afla şi Katherine Doughty, acum doamna Joseph Radcliffe, care păstrase o copie a scrisorii lui Roger. În ea, el îi promitea să construiască o capelă dacă vor ajunge vreodată să se căsătorească. Orton nu ştia nimic despre acest amănunt.
Înfăţişările la proces au durat peste 102 zile şi i-au costat pe membrii familiei Tichborne 90.000 de lire sterline. Blestemîndu-se pentru discursul său neşlefuit

embolie pulmonară, colici biliare, pancreas inflamat, pietre la rinichi, dureri menstruale și alte afecțiuni ginecologice. Fumătorii au un risc mai ridicat ca durerile de spate să se cronicizeze, deoarece nicotina îngustează vasele de sînge, acest fapt avînd repercusiuni asupra circulației sanguine. Oasele sînt irigate tot mai puțin și se subțiază. Disfuncțiile cranio-mandibulare sau plombele dentare prea înalte pot provoca, de asemenea, dureri de spate. Statisticile arată că majoritatea intervențiilor chirurgicale sînt ineficiente.
Medicina energo-informațională recomandă, în terapiile ce vizează durerile la nivelul coloanei vertebrale, în primul rînd deblocarea energetică a discurilor coloanei, refacerea comunicării energetice între discuri (mai ales între C1 și C7), o detoxifiere la nivel celular a întregului organism, reglarea nervului sciatic, întărirea metabolismului și a imunității coloanei.
Durerile de spate în zona lombară sînt adesea provocate și de alte afecțiuni gastrointestinale. Multe persoane s-au obișnuit cu diferite laxative care, în timp, duc și la apariția durerilor de spate, intestinul tasînd
(„Aş fi cîştigat doar dacă aş fi tăcut naibii din gură”, spunea el mai tîrziu), Orton a fost acuzat de mărturie falsă, primind 23 de capete de acuzare, procesul său ulterior avînd o durată de 188 de zile: cel mai lung proces penal din istoria juridică a Marii Britanii. Găsit vinovat, a fost trimis la închisoare pentru paisprezece ani. Eliberat după zece, a apărut total schimbat şi şi-a vîndut „confesiunea” revistei The People pentru 3000 de lire sterline, dar a murit în 1898 fără nici un ban, la vîrsta de şaizeci şi patru de ani.
Cum a reuşit să păcălească atît de multe persoane? În cazul doamnei Tichborne este de înţeles, dorinţa acesteia de a-şi regăsi fiul fiind mai puternică decît ceea ce era evident şi, fără îndoială, unii dintre „martorii” lui au fost mituiţi – dar alţii, se pare, se mulţumiseră să accepte că, în timp ce se afla în Australia pentru o perioadă de zece ani, suplul Sir Roger se umflase şi devenise bărbatul de aproape trei ori mai voluminos şi, în plus, nu-şi mai amintea absolut nimic din trecut. Unii oameni sînt cu adevărat în stare să creadă absolut orice.
Un farsor inventiv (1)
Părăsindu-şi căminul din Frostbury, Maryland, imediat ce s-a ivit ocazia, pentru a se alătura circurilor ambulante şi spectacolelor publice de medicină, Harry Reichenbach, un veritabil farsor, avea să înveţe, în curînd, toate trucurile meseriei. înainte de primul război mondial cîştiga bani în cadrul tîrgurilor, expunînd un castron cu apă care conţinea „singurul exemplar în viaţă de peşte brazilian invizibil”; iar cu ocazia sărbătorilor de Mardi Gras din New Orleans, prezenta gurilor-cască celebrele sale raţe dansatoare. Această prestaţie avea în rolurile principale trei raţe aşezate pe un cadru de sîrmă legat de o podea de tinichea şi ridicat pe o cutie de marfa uscată. Şmecheria consta în a convinge publicul nedumerit cît de greu este să dresezi raţele, să le înveţi arta terpsihoreană; să le determini să dobîndească simţul ritmului şi ureche muzicală –moment în care raţele, anterior nepăsătoare, se ridicau pe picioare şi începeau să danseze. De ce? Pentru că o asistentă aprinsese fitilul unei lămpi aflată sub podeaua de tinichea. Nefericitele răţuşte îşi ridicau un picior, apoi şi pe celălalt, într-o concordanţă perfectă, plină de viaţă, în timp ce un violonist cînta Turkey in the straw. „Raţele dansatoare au constituit minunea sărbătorii de Mardi Gras”, scria el mai tîrziu. „Ne-au adus peste o mie de dolari în săptămîna respectivă.” (va urma)
STUART GORDON
prea mult coloana. Durerile de spate în zona toracală au adesea legătură cu alte afecțiuni existente în aria pulmonară. De cele mai multe ori, reglînd energetic funcționalitatea plămînilor, durerile dispar. Durerile de spate existente în zona cervicală sînt adesea însoțite de alte afecțiuni care se extind pînă la umeri, pierderi de echilibru, stări de vomă, dureri de cap etc.
O terapie care completează biorezonanța este VacuMed Intermitent, prin care se obține un joc de presiune asupra vaselor sanguine, cu efecte vasodilatatorii. Elongațiile, în combinație cu o neurodistrofie pe nervii coloanei, fracturi, luxații, rupturi ligamentare sau musculare, recuperare după protezare de șolduri sau genunchi sînt afecțiuni ce pot fi ameliorate sau chiar vindecate cu ajutorul acestei terapii.
FLORICA MUNTEANU, specialist în medicina energo-informațională, membru al Societății naturiștilor din Germania, membră B.I.T. (Biorezonanz International Therapie), Psiholog

Diagnosticări și tratamente cu Biorezonanță Str. Brândușelor nr. 6B, sector 3, București
Telefon: 0731.871.968/021.322.40.04

www.dermavital-med.ro; e-mail:office@dermavital-med.ro
ORIzONTAL: 1) Vin în tranșe; 2) Tăiere în carne vie – Mijloc de circulație!; 3) Îl găsești după multe eforturi – Nici laie, nici bălaie; 4) Pregătiți pentru lăsarea secului; 5) Ascuțite... brici – Cuprinși de cîrcei; 6) Vine de la răsărit – Înmînat; 7) Bătuți la cap; 8) Trase pe dreapta – Om la răscruce; 9) Totul da capo! – Păcălită; 10) A băga la cap – Șut prin întoarcere!
VERTICAL: 1) Sînt bune de cinste; 2) A supune presiunilor – Lipsit de vigoare; 3) Se ocupă cu prelucrarea maselor plastice; 4) Aflate în mers! – Clasică contabilă la spațiul locativ; 5) Fuge la întîmplare (fem.) – Imobil... proprietate personală; 6) Puși la index – Ofertă la ziar!; 7) Om de cuvînt – Lăsat sub povara greutăților; 8) Smuls din rădăcină; 9) Port militar – Avantaj din start; 10) Utilare de nivel mediu! – Ridicat de la opincă (dim.).
GH. ENE
Dezlegarea careului ,,POzNE”
1) NECONTENIT; 2) AMANUNTITE; 3) TIPIC – ITAN; 4) US – RISC – RA; 5) RACI – IATAC; 6) ARACIT – ASI; 7) LIN – LASI –T; 8) E – APARENTA; 9) TALER – CAIT; 10) EmErITI – rE.
Răcoarea și liniștea bisericii avură un efect pozitiv asupra fetei, care-și făcu în mod reflex cruce și înaintă către altar. Băncile așezate de ambele părți ale căii ce ducea la acesta erau baroce, iar amvonul suspendat pe peretele de sud se sprijinea pe o coloană dorică. Arcada ce susținea spațiul în care se găsea altarul era drapată pe margine cu o pînză neagră ce-i dădea un aer trist și serios în același timp. În altar se găsea o lespede rotundă de piatră, susținută de o coloană hexagonală din același material, decorată cu capete de heruvimi, lucru neobișnuit pentru o biserică reformată.
Ajunsă aici, Iulia se întoarse pe călcîie și privi spre partea opusă, unde ar fi trebuit să se găsească orga. Într-adevăr, așa era. Nu era ceva spectaculos, de felul celei din Biserica Neagră sau din Catedrala Evanghelică de la Sibiu, dar era o orgă cu aproximativ 38 de tuburi pe partea vizibilă, ceea ce însemna că era asemănătoare cu cele din bisericile fortificate de la Prejmer sau Hărman. Ridică apoi ochii pe bolțile rotunde ale bisericii, care țineau, ca într-o adevărată plasă, întreaga navă, descărcîndu-i greutatea pe zidurile sprijinite pe exterior, nu de contraforți ca în cazul goticului, ci pe cele patru bucăți de clădire care împreună dădeau edificiului forma de cruce. Terminînd inventarierea lăcașului de cult, micul istoric din Iulia s-a declarat satisfăcut și a decis să-și continue drumul. A ieșit din biserică și s-a îndreptat spre bulevard. S-a oprit privind circulația mașinilor și a troleibuzelor marca Tudor Vladimirescu, pe scurt „TV”, gîndindu-se amuzată ce ecologiști erau comuniștii ăștia și cum se ocupau ei de mediu, utilizînd vehicule electrice. Îndreptîndu-și privirea spre zona pe unde venise, descoperi din nou statuia lui Stalin din fața clădirii Poștei Centrale și, fiindcă nu avusese ocazia să o studieze cum se cuvine, hotărî că mai are vreme să o facă.
După cîțiva pași, traversă strada și ajunse pe trotuarul ce mărginea parcul, iar pașii o duseră involuntar spre el. Păși cu sfială pe alee temîndu-se să nu deranjeze florile și copacii care creșteau aici. Locul de joacă pentru copii nu exista, nici mica balenătobogan din piatră lustruită de tururile pantalonilor multor generații de copii care se bucuraseră de ea. Descoperi, însă, mergînd spre clădirea Primăriei, statuile lui Cincinat Pavelescu și ale lui Șt. O. Iosif. Privind la ceasul brățară care-i atîrna de mîna stîngă, cadou de majorat primit de la părinții ei, observă că se făcuse aproape 5 după amiaza. Grăbi pasul spre statuia lui Stalin, fiindcă risca să rămînă peste noapte la „mătușa-n gară” și să se întîlnească cu Miliția. Pe drum îi veni o idee strălucită, așa că se abătu pe la Poștă. Se duse la un ghișeu și ceru o coală de hîrtie și un pix. Scrise cîteva rînduri pe foaia de hîrtie, cumpără un plic, o introduse în el, după care o rugă pe funcționară să-i pună o ștampilă a poștei ca să-l poată depune la cutie. Apoi luînd scrisoarea, o băgă în rucsac și ieși afară îndreptîndu-se spre statuia lui Stalin. Statuia era ridicată pe o bază de pămînt cam de 1 metru, pe care era turnată o placă de beton de formă pătrată, groasă cam de 60 de cm, deasupra căreia, la aproape 4 metri, se înălța soclul statuii, pentru a-l face vizibil tuturor pe Tovarășul Stalin, „cel care împreună cu poporul rus, libertate ne-o adus”, gîndi zîmbind fata. Zîmbetul i se lărgi pe față și fu aproape să izbucnească în rîs atunci cînd își aminti gluma conform căreia, avînd de ales între Sibiu și Brașov pentru a le schimba numele în Orașul Stalin, comuniștii români au ales Brașovul gîndindu-se că ar fi fost nepotrivit pentru un cetățean să ceară în Alimentară „Salam de Stalin”! Văzut de jos, conducătorul popoarelor era reprezentat în uniforma sa de general. Purta cizme pînă sub genunchi, trase peste pantalonii model militar. Vestonul era încheiat pînă la gît cu patru nasturi mari de alamă și era completat de mantaua groasă și lungă pînă aproape de călcîie. Ținuta era întregită de chipiul ofițeresc al Armatei Roșii din anii
ʼ40. Postura personajului era una cuvenită unei figuri istorice: privirea înainte spre idealul de aur al omenirii –comunismul, mîna dreaptă ridicată a salut binevoitor sau a binecuvîntare adresată mulțimilor care se uitau la el ca la un izbăvitor, în timp ce stînga era dusă elegant la spate, într-o atitudine relaxată de lord britanic, care știe că are un imperiu întreg la picioarele lui, așa că-și permite să fie binevoitor cu cei care i se supun de bunăvoie.
Cuprinsă de admirație, Iulia nici nu-și dădu seama că în spatele ei se afla de cîteva minute Andrei, recentul ei prieten, care o privea sorbind-o din priviri. După aproape un minut, tînărul se apropie de ea întrebînd-o:
– Nu-i așa că-i frumoasă, tovarășă Iulia?
Fata tresări și făcu un pas înainte întorcîndu-se pe jumătate să vadă cine-i vorbește și-l recunoscu imediat pe tînărul care o adusese cu mașina în oraș. Relaxînduse, îi zîmbi:
– Bună Andrei, nu te-am observat. Admiram statuia asta frumoasă, completă ea.
– Am văzut spuse băiatul, și m-am gîndit să te salut și să te întreb dacă ai reușit să te întîlnești cu prietena ta.
– Nu, din păcate nu am reușit – îi spuse cu tristețe în glas – și nici nu știu dacă o s-o mai văd curînd.
– De ce? V-ați certat?
– Nu, nu ne-am certat, dar... e o poveste lungă și nu am timp să ți-o spun, fiindcă mă grăbesc să mă întorc la mine acasă, la București. Trebuie să ajung urgent la Biblioteca Națională mîine dimineață, să mă documentez pentru o lucrare pe care prietena mea trebuie s-o termine înainte să plece la Moscova. Na, că ți-am zis – zîmbi Iulia, fericită că găsise un motiv să justifice față de Andrei lipsa îndelungată a prietenei ei.
– Pleacă la Moscova? Dar asta e minunat! – se entuziasmă băiatul. Păi atunci cred că te pot ajuta. Dar cred că vrei să spui Biblioteca Centrală de Stat, nu Națională, zîmbi băiatul. Am un prieten care lucrează chiar acolo și te-ar putea sprijini, însă dacă vrei să fii mîine dimineață la bibliotecă ar trebui să te grăbești, fiindcă e aproape ora 18 și ultimul tren spre capitală pleacă peste o oră.
– Aoleu! Cu ce ajung mai repede la gară?
– Cu mine, răspunse zîmbind băiatul. Am mașina aproape, hai să mergem.
Pobeda era parcată la bordură pe laterala primăriei, așa că ajunseră repede la ea, se urcară și porniră spre gară. Ieșiră în strada Nicolae Iorga, îndreptîndu-se spre Casa Armatei, unde virară la dreapta pe Strada Lungă, ocazie pentru Iulia să constate existența unui restaurant pe locul unde avea să fie sediul Partidului Național Liberal ai cărui membri erau prin pușcării, chiar în clipa în care ea încerca să ajungă la București. Cînd mașina se înscrise pe Strada de Mijloc, văzu într-o parte un canal deschis pe unde curgea „Spurcata”, cum i se spunea de către brașoveni pîrîului Graft, numit de Pecenegi „Bras”, adică „apă curată”, de unde se și trăgea numele orașului, sufixul „ov” fiind un diminutiv. De aici, o luară pe str. Operetei, iar cînd ajunseră în dreptul Bisericii Adormirea Maicii Domnului, Iulia îi ceru lui Andrei să oprească, fiindcă trebuia să-și ia la revedere de la clopotarul bisericii care era văr de-al doilea cu ea. Andrei opri mașina și-i spuse că nu are decît 15 minute la dispoziție, fiindcă altfel riscă să piardă trenul. Iulia îi mulțumi și se îndreptă către birourile preoților. Ciocăni la ușă și intră. Înăuntru găsi un tînăr la vreo 34 de ani, care ridică capul din hîrtiile pe care le studia.
– Cu ce vă pot ajuta?
– Sînteți preotul paroh? – îl întrebă fata.
– Da. Mă numesc... Popa, glumi el.
– Atunci mă puteți ajuta. – În ce fel?
– Trebuie să transmiteți un mesaj părinților mei.
– De ce nu-l transmiți dumneata? – se miră preotul, invitînd-o cu un gest să ia loc pe scaunul de lîngă biroul său.
– Fiindcă doar prin dumneavoastră ajunge cel mai repede la destinație, răspunse fata așezîndu-se. Am să
Coboară peste lume lumina nemuririi
În suflete curate și-n clopote ce bat
În numele iertării, în numele iubirii
Spre mîntuirea noastră: Christos a înviat!
În florile de munte și-n roua dimineții
În iarba ce renaște și-n gîndul cel curat
În palmele muncite ce țin esența vieții
Și spre nădejdea lumii: Christos a înviat!
Pentru ieșirea noastră din tainice ispite
Pentru icoana Maicii ce plînge neîncetat
Și pentru Sfinții lumii, din locuri neștiute
Ce ard în rugăciune: Christos a înviat!
Pentru poporul nostru căzut în rătăcire
Pentru părinții care în ceruri s-au mutat
Pentru trezirea noastră din crunta amăgire
Lumină și iubire: Christos a înviat!
E Învierea Sfîntă, să o cinstim cu toții
Și să uităm de rele, de griji și de nevoi
Christos Mîntuitorul învinge coasa morții
Și prin puterea Crucii vom învia și noi.
M ARIUS B UD ă R ă SCU
vă spun direct. Această scrisoare – spuse fata scoțînd plicul din buzunar – trebuie să ajungă la părinții mei pe data de 10 iulie 2022.
– Ați spus 2022? – se miră preotul.
– Da, am spus 2022.
– Cum să o transmit părinților dumneavoastră în anul 2022 cînd ei ar trebui să fie aici? Nu înțeleg.
– Știu că probabil mă veți crede nebună, dar eu am ajuns aici venind din anul 2022. Părinții mei au rămas acolo și prin această scrisoare îi anunț că sînt bine.
Preotul se uită la ea ca la un om care-și pierduse mințile, fără să spună nimic. Atunci Iulia scoase Cartea de Identitate și o puse pe birou. Preotul se uită la ea, citind cele scrise, o luă în mînă o îndoi ușor de cîteva ori, apoi o puse la loc zicînd:
– E cam greu să faci așa ceva în ziua de azi...
– Da, părinte, așa e, e foarte greu, iar ca să faci așa ceva e imposibil – mai spuse ea, așezînd pe masă smartphone-ul ei Xiaomi 11 T.
– Ce e asta? – se miră preotul
– Asta e un telefon mobil, aparat foto, cameră video și mașina de scris în același timp.
Apoi îi arătă cum funcționau toate acele minunate instrumente pe care le pomenise mai devreme si cînd termină spuse:
– Acum mă credeți că vin din viitor?
– Da, acum te cred, dar spune-mi, dacă vii din viitor, ce se întîmplă cu comunismul pînă atunci?
– Dispare, părinte. Va fi o revoluție populară în decembrie 1989 care-l va îndepărta!
– Slavă Domnului! – se închină preotul.
– Ah, și mai e ceva. Ca să mă credeți că e așa cum spun, vreau să știți că succesorul dumneavoastră va fi preotul Ioan. Lui să-i dați scrisoarea pentru părinții mei și dînsul să o dea preotului ce-i va urma și tot așa, timp de 60 de ani, pînă va ajunge la ei în ziua pe care am stabilit-o eu. Acum mă scuzați, trebuie să plec fiindcă am un tren de prins.
– Așa voi face, domnișoară. Scrisoarea dumitale va ajunge la destinație. Dumnezeu să te aibă în paza Lui – mai zise preotul, în timp ce Iulia ieșea ca fulgerul pe ușă.
Se aruncă în mașină și-i spuse lui Andrei:
– Gata, putem merge. Am întîrziat mult?
– Douăsprezece minute. Te-ai încadrat bine, spuse băiatul pornind mașina de pe loc. (va urma)
NICU MARIUS MARIN

„Am fost farul călăuzitor pe o mare în permanentă furtună“
Internet: www.tribunul.ro

Oare vom ajunge la „performanța” de a face lucrurile „prin noi înșine”, la a ne vedea cu sacii în căruță prin munca altora? Spun asta fiindcă am senzația că SUA iau în considerare inclusiv schimbarea granițelor Europei pentru a pune stavilă Rusiei. Recent am citit un articol în revista americană Foreign Policy, fondată de reputatul profesor Samuel P. Huntington, unul dintre indicatorii importanți ai politicii externe a Statelor Unite, articol al cărui titlu spune așa: „E timpul să refacem uniunea polono-lituaniană”. Cum? – mi-am zis. Adică să ne
întoarcem cu 700 de ani în urmă doar fiindcă Putin a făcut greșeala vieții lui invadînd Ucraina și să refacem ce a fost odată?
Parcă granițele erau inviolabile, parcă țările aveau drept la autodeterminare, și, dintr-o dată, orice se poate schimba fiindcă actualul hegemon ia asta în considerare? Se pare că da. Firește că nici un oficial american nu a vorbit încă despre așa ceva, însă faptul că acest articol a apărut în Foreign Policy, mă face să cred în posibilitatea aceasta. (continuare în pag. 23) n m

Asta am exclamat eu atunci cînd am citit în publicația Foreign Policy că președintele chinez Xi Jinping își pregătește țara de război. Ceea ce scriam în urmă cu cîteva numere – anume că îmi este mai frică de chinezi decît de ruși – începe să se adeverească, mai ales prin blocul de securitate economică și militară care se organizează în jurul Chinei sub numele de BRICS. Scriam în editorialul intitulat „Alternativa” că ceea ce pregătesc chinezii și rușii reprezintă o alternativă la sistemul economic și
politic occidental, iar cele petrecute în ultima vreme îmi dau dreptate. De asemenea, constat că previziunile maestrului Neagu Djuvara legate de căderea civilizației occidentale sub loviturile perifericilor chinezi, supuși fenomenului de aculturație (despre care am scris și eu în partea a doua a articolului „Cum încep și se sfîrșesc civilizațiile”) încep să se împlinească. Ce mă îngrijorează este faptul că în BRICS s-au strîns națiuni conduse de oameni care știu să facă lucrurile bine și pînă la capăt, planificat și ordonat, spre deosebire de superficialii capi ai civilizației occidentale, tipi încrezuți și corigenți la multe... „materii”. (continuare în pag. 23)

motto: ,,Să te închini Domnului, Dumnezeul tău, și numai Lui să-I slujești” (Luca 4:8).
Dacă ținem seama de Sentința de condamnare a lui Isus Christos, păstrată pe un pergament la Mînăstirea Simancas din Spania, vinovat de răstignirea Mîntuitorului nostru se face Imperiul Roman, condus de Tiberius Caesar. În acest sens, în textul Sentinței, stau scrise, printre altele, următoarele: ,,Eu, Pilatus Pontius, reprezentantul Imperiului Roman în acest palat Larchii, rezidența noastră ca Pretor, judec și condamn la pedeapsa cu moartea pe Jesus, numit Chrestus Nazarenus, din Țara Galilea, om de lege Mozaică, sedițios contra Marelui Împărat Tiberius Caesar și, în urma mărturisirilor mari și ponderoase ale poporului, DECID ca el să moară pe cruce, ca vinovat de a fi adunat oameni bogați și săraci, de a fi provocat tumulte în toată Galilea, dîndu-se în mod fals drept fiu al lui Dumnezeu (IEHOVAH) și în mod fals ca Rege al Ierusalimului (al lui ISRAEL), amenințînd cu ruina Ierusalimul și Imperiul Sacru” (...).
Nu se știe cît de veridică este această sentință, cumpărată pe bani grei de Împăratul spaniol Carol Quintul și depusă în grija călugărilor iezuiți, nu departe de Valladolid, dar ce mai contează, acum, după două milenii, aceste aspecte. Important este ce va urma după trecerea la cele veșnice a oricărui om și ce lasă acesta urmașilor săi ca valoare spirituală.
Asta este opinia mea și, în susținerea ei, vă relatez o experiență personală. În anul 2006, mama mea a murit de ocluzie intestinală la Spitalul Militar din București, deși fusese internată pentru cancer la plămîni. Atunci, comandantul spitalului, care era un general, mi-a pus în față un formular de cerere-tip, prin care aș fi putut solicita, prin completarea lui, deschiderea unei anchete, în urma căreia s-ar fi putut afla cine a fost vinovat de moartea mamei mele. Mi s-a explicat că numai așa se putea ajunge la un proces penal, în care aș fi putut cere pedepsirea vinovaților, daune ș.a.m.d. În cele din urmă, am luat decizia de a sta în banca mea și de a rămîne în veci cu un gol în suflet și o lacrimă pe obraz.

MARIUS MARIN
Revenind la Domnul Isus Christos, aflați că, în luna mai 1948, a doua zi după proclamarea Statului Israel, un grup de preoți greco-catolici și protestanți din Anglia, Germania și Olanda a depus la Curtea Supremă a Israelului o cerere de ,,rejudecare” a procesului lui Isus. Informat fiind asupra curioasei solicitări, șeful guvernul și comandantul suprem al armatei, David Ben Gurion, a decis: ,,Cererea să se cerceteze și să se soluționeze”.
Astfel, s-a născut un dosar care a ajuns la procurorul Haim Cohn, numit ulterior Procuror-șef al Israelului. Apoi, în 1952, a devenit ministru al Justiției, iar în 1960 a fost numit președinte al Înaltei Curți de Casație a statului Israel. De reținut și faptul că Haim Cohn s-a născut la Lübeck, în Germania, în anul 1911. A început să studieze Filozofia și Limbile semite la Universitatea din München, după care, în 1930, a emigrat în Palestina, unde și-a continuat studiile universitare la Jeshiva ,,Merkaz Harav” și la Universitatea Ebraică din Ierusalim. (continuare în pag. 22)
VALENTIN TURIGIOIU(urmare din pag. 21)
Oricum, din start, cererea preoților creștini din Europa avea în jurul ei o mulțime de nedumeriri. În primul rînd, nu se știa care a fost adevăratul interes al solicitanților, motiv pentru care judecătorul Haim Cohn ar fi putut închide cazul invocînd excepția lipsei de interes. În al doilea rînd, nu se știe de ce preoții din Olanda, Germania și Anglia nu au acționat în propriile țări. S-a întîmplat ca și cum noi, românii, am solicita Angliei și Franței să rejudece procesul lui Horia, Cloșca și Crișan. Iată de ce rejudecarea procesului lui Isus intrase clar și sub incidența excepției de necompetență teritorială. Mai mult, deși cererea respectivă avea și un accentuat grad de inadmisibilitate, nu se poate trece nici peste termenul de ,,prescripție”, regăsit în toate procedurile penale din lume. Și, la urma urmei, dacă prin sentința finală s-ar fi stabilit că faptele și vinovații acelor vremuri ar fi total altele decît cele cunoscute pînă acum, nu cumva ar fi trebuit schimbate și scrierile biblice? Oare nu se știe că ,,De va mai adăuga cineva ceva sau de va scoate cuvinte din această carte, Dumnezeu va trimite asupra lui pedepsele ce sînt scrise în această proorocie” (Apocalipsa 22:18,19)?
Acum, cred că veți înțelege de ce judecătorul Haim
Cohn, spirit metodic și eminent jurist, și-a dat seama de capcana care i-a fost întinsă, în baza sentinței ce urma să o dea urmărindu-se să se modifice Biblia și, mai apoi, aceasta să fie considerată erezie. De reținut că ,,Toată Scriptura este insuflată de Dumnezeu și de folos spre învățătură, spre mustrare, spre îndreptare, spre înțelepțirea cea întru dreptate. Astfel ca omul lui Dumnezeu să fie desăvîrșit, bine pregătit pentru orice lucru bun” (2 Timotei 3:16,17). Biblia Îl indică pe Dumnezeu ca autor al ei, prin faptul că a insuflat, în mintea și sufletul celor care au scris-o, toate adevărurile. Cele Zece Porunci au fost rostite de Însuși Dumnezeu și au fost scrise cu mîna Sa. Ele sînt de natură divină, nu umană.
Din păcate, în toată istoria omenirii s-au făcut simțite aceleași uri față de principiile Legii lui Dumnezeu, aceleași metode prin care eroarea este făcută să treacă drept adevăr, prin care Legea lui Dumnezeu este înlocuită de legi omenești și prin care oamenii sînt făcuți să se închine ființei create, în loc să se închine Creatorului.
Un exemplu edificator în acest sens îl constituie Decretul emis de al Doilea Conciliu de la Niceea, din anul 787 d.Chr., prin care s-a autorizat închinarea la icoane, dovedită a fi una dintre cele mai reușite coruperi ale creștinătății, care s-a infiltrat în biserică pe ascuns și aproape pe neobservate. Totul a început sub o aparență nevinovată, biserica afundîndu-se treptat în practicarea idolatriei, interzisă de cea de A Doua Poruncă divină. În fapt, icoanele și picturile au fost introduse la început în biserici nu pentru ca oamenii să li se închine, ci fie în locul cărților, pentru a întipări învățăturile în mintea celor care nu puteau să citească – precum benzile desenate din prezent –, fie pentru a trezi evlavie în mintea celorlalți. Cît de mult au răspuns ele acestui scop este discutabil, dar, chiar admițînd că, pentru un timp, aceasta a fost intenția, curînd realitatea s-a schimbat și s-a constatat că picturile și icoanele aduse în biserică, în loc să lumineze, au întunecat mințile celor ignoranți și, în loc să înalțe, au înjosit evlavia închinătorilor. Astfel, s-a deturnat închinarea credincioșilor de la Dumnezeu la lucruri create.
Nu e un secret pentru nimeni faptul că Satana știa bine că Sfintele Scripturi îi vor face pe oameni în stare să discearnă amăgirile lui și să reziste puterii lui, motiv pentru care a început să-i îndepărteze cît mai mult de scrierile biblice. Timp de sute de ani, răspîndirea Bibliei a fost interzisă. Așa s-a făcut că Papa a ajuns să fie aproape universal recunoscut ca locțiitor al lui Dumnezeu pe pămînt, înzestrat cu autoritate peste biserică și stat.
S-a mers pînă acolo încît la Conciliul din Toulouse, din anul 1229, s-a stabilit ca ,,deținerea de
către laici a cărților Vechiului și Noului Testament să fie interzisă”, urmînd ca ,,Prefecții districțiilor să facă percheziții la locuințele oamenilor pentru a le confisca cărțile sfinte”. Apoi, la Conciliul din Tarragona, din anul 1234, s-a hotărît ca ,,În termen de 8 zile, toată lumea să predea episcopului local cărțile sfinte pentru a fi arse”. De reținut că, în acele vremuri, Biblia era considerată o ,,plagă”, motiv pentru care a fost zdrențuită fără limite, au apărut noi evangheliști, care au distrus adevărul Evangheliei, făcînd noi evanghelii pentru scopurile lor. Mai mult, la Conciliul de la Konstanz, din anul 1415, s-a bătut în cuie, cum se mai zice, decizia ca Biserica Romano-Catolică să-și păstreze veșnic opoziția față de Biblie. Legat de acest aspect, să ne reamintim că, anul trecut, actualul Papă a declarat public că intenționează să modifice Biblia.
Și, pentru că Satana se va încumeta să ,,adreseze cuvinte de defăimare împotriva Celui Preaînalt și va asupri pe sfinții Celui Preaînalt și își va pune în gînd să schimbe sărbătorile și legea” (Daniel 7:25), era de așteptat ca și Porunca A Patra să fie falsificată. Mă refer la faptul că vechiul Sabat, ,,ziua pe care Dumnezeu a binecuvîntat-o și a sfințit-o” (Geneza 2:23), s-a vrut înlocuită cu sărbătoarea păzită de păgîni ca ,,venerabila Zi a Soarelui”. Pentru ca atenția poporului să poată fi îndreptată spre duminică, aceasta a fost declarată sărbătoarea în cinstea Învierii lui Christos. Deși se țineau servicii religioase duminica, ea era privită totuși ca o zi de recreere, Sabatul fiind încă respectat cu sfințenie.
Pentru a pregăti calea prin care să-și aducă la îndeplinire lucrarea pe care o avea în plan, Satana îi determinase pe iudei, înainte de venirea lui Christos, să împovăreze Sabatul cu cele mai stricte cerințe, făcînd din păzirea lui o povară. În timp ce creștinii, în general, continuau să păzească duminica drept sărbătoare a bucuriei, Satana i-a determinat să facă din Sabat o zi de post, de amărăciune și de tristețe, pentru a-și arăta ura față de iudaism. Vorba lui Corneliu Vadim Tudor: ,,În șase zile Dumnezeu a creat lumea, iar în a șaptea zi, omenirea L-a negat pe Dumnezeu”.
Cert este că în momentul în care legile și tradițiile omenești au devenit mai presus de cele divine, a ieșit la iveală corupția, care este întotdeauna rezultatul îndepărtării de Dumnezeu. Ce mai, întunericul părea să se mărească... Închinarea la chipuri cioplite devenise aproape generală. Se ardeau lumînări și se rosteau rugăciuni înaintea icoanelor, care astăzi au atîrnate de ele și cîte o cutie a milei. Mințile oamenilor erau stăpînite de superstiții, zodiace, sex, droguri, alcool, corupție ș.a.m.d.
Pînă și ceremonialul biblic al Cinei Domnului fusese înlocuit cu jertfa idolatră a liturghiei. Preoții papali pretindeau că, prin ritualul lor ridicol și lipsit de sens, transformă efectiv acea pîine simplă și acel vin în ,,trupul și sîngele lui Christos”. Ei pretindeau în mod deschis că au puterea de a-L crea pe Dumnezeu, Creatorul tuturor lucrurilor.
Starea lumii sub puterea papală era o împlinire teribilă și izbitoare a vorbelor spuse de profetul Osea: ,,Toți jură strîmb, mint, ucid, fură și sînt desfrînați; săvîrșesc fapte silnice, iar sîngele vărsat curge peste sînge. Nu mai este credință, nici iubire, nici cunoaștere de Dumnezeu și pentru asta omenirea va pieri” (Oseia 4:3,2,6).
Din păcate, după răstignirea lui Isus Christos și pînă în prezent, adică timp de două milenii, omenirea nu a înțeles nimic din sacrificiul Mîntuitorului nostru, care a fost trimis printre noi, oamenii, să ne ierte păcatele și să ne garanteze nemurirea. Nu s-a înțeles nimic nici după ce Adam și Eva au fost pedepsiți pentru neascultarea vorbelor divine, nici după Potop, după ploaia cu pucioasă din Sodoma și Gomora sau după distrugerea Turnului Babel, un fel de ONU, NATO sau UE din zilele noastre.
Avînd în vedere că toate aceste aspecte sînt reale, consemnate în Biblie, este de la sine înțeles de ce judecătorul Haim Cohn a mizat pe faptul că numai în Cartea Sfîntă putea găsi cele mai relevante probe pentru a afla cine L-a ucis pe Isus. Din start, distinsul magistrat a plecat la lucru conștient fiind de faptul că,
Dumnezeu a făcut numai trei oameni, în mod direct: Adam, Eva și Isus.
Extraordinarul paradox al lumi antice: la Nașterea lui Isus s-a făcut lumină în plină noapte, iar la Moartea lui s-a făcut întuneric în plină zi.
De 2.000 de ani, Isus este tatăl nostru adoptiv.
„Mărire Ție, Doamne!” – un imn tulburător al liturghiei ortodoxe. Dar are Dumnezeu nevoie să fie mai mare decît este?
Isus a murit pe Cruce și pentru miliardele de oameni care nu Îl recunosc nici acum.
Nu știu cum e la alte religii, dar noi, creștinii, Îl avem pe Isus în noi, ca pe un organ mai vital decît inima.
Principala menire a lui Isus pe pămînt a fost aceea de a fi un model comportamental –de bunătate, frumusețe și cinste – pentru specia umană, care, fără El, s-ar fi sălbăticit și, probabil, s-ar fi auto-distrus pînă acum.
Pentru mine, unul dintre marile mistere ale Bibliei este acesta: de ce oare Dumnezeu i-a îngăduit lui Abraham să-și cruțe fiul de la sacrificiu – dar tocmai Lui nu Și-a îngăduit asta, jertfindu-L pe Isus?
Atunci cînd citesc Noul Testament am senzația că Îl țin pe Isus la pieptul meu și că Îl legăn ca pe un copil.
Isus este, pentru Biblie, ceea ce este „Oda Bucuriei” pentru Simfonia a IX-a: o încununează și o salvează. După furtuna atîtor patimi, vine plutirea în lumină, în bunătate și pace. Fără Isus, Biblia ar fi fost ceea ce este Simfonia a IX-a fără „Oda Bucuriei”. Așadar, să cîntăm, împreună cu Schiller și menestrelul Beethoven: „Slavă Ție, stea curată!”.
Noi n-am fost alături de Isus în agonia Lui pe cruce. Și, cu toate astea, El e permanent alături de noi, în suferința noastră. Ce dovadă mai bună vreți despre idealismul și noblețea Lui?
Ar fi putut Isus să-i nimicească pe cei care L-au batjocorit și L-au răstignit? Eu cred că nu. De ce? Pentru că forța Lui este copleșitoare, întradevăr, dar este o forță a binelui, nu a răului și a morții.
Nu tinerii L-au ucis pe Isus, ci bătrînii…
pînă la sentință, va fi drum lung, ,,cheia” procesului aflîndu-se în răspunsul la următoarea întrebare: Cine a ordonat arestarea lui Isus? Deși cercetarea probelor, care nu erau contemporane cu Isus, a durat vreo 20 de ani, calea spre adevăr a devenit din ce în ce mai întortocheată. Cele patru Evanghelii fuseseră scrise la zeci de ani după judecarea lui Isus, plus că s-au găsit nenumărate contradicții între ele. Așa s-a făcut că judecătorul israelian, dîndu-și seama că devenise unealta unor interese ascunse, a închis cazul în coadă de pește, declarînd: ,,Rezultatele se vor arăta cu timpul, cînd se va admite faptul că vinovată de uciderea lui Isus este întreaga omenire”.
Da, așa este, de-a lungul mileniilor, omenirea și-a bătut joc de creația lui Dumnezeu într-un hal fără de hal. Chiar și în ceasul al 12-lea, cînd Dumnezeu a încercat pentru ultima oară să-Și salveze creația, oamenii L-au ucis pe Isus Christos la îndemnul ,,preoților cei mai de seamă” (Ioan 19;6).
Acum, aflată la poarta iadului, omenirea arde de nerăbdare să afle CINE L-A UCIS PE ISUS, acționînd precum incendiatorul care strigă după pompieri. Este o întrebare retorică, firește, pusă, așa, ca să se mai dreagă busuiocul, dar rețineți că ,,Ziua Domnului va veni aprigă, mînioasă și întărîtată la mînie ca să pustiască pămîntul și să stîrpească pe păcătoșii de pe el” (Isaia 13:9). Sau, altfel spus, ,,Cumplita zi ca hoțul o să vină/ Ne va pedepsi Domnul din amvon./ Alegeți: Întuneric sau Lumină?/ Apocalipsa nu dă telefon...” (Corneliu Vadim Tudor, ,,Apocalipsa nu dă telefon” – 2013).
(urmare din pag. 21)
Adaug la această teorie o serie de declarații făcute la postul tv Antena 3 CNN de James Olson, fost şef al contraspionajului din CIA, care a afirmat următoarele. „Cred că este momentul potrivit (pentru o unire între România și Republica Moldova – n.r.), fiindcă Moldova traversează o stare de pericol extrem. Este clar că fie prin Transnistria fie prin alte locuri, Rusia poate ataca Moldova. Ştim că serviciile de informaţii ruseşti au încercat să o răstoarne pe doamna preşedintă Sandu. Acest lucru e ceva grav, deci Moldova trece printr-un mare risc. Nu cred că o discuţie despre unire ar fi nepotrivită, cred că ar fi chiar o mişcare inteligentă din partea Moldovei şi a României”. Firește, așa ceva nu s-ar putea face decît după încheierea războiului, în cadrul negocierilor de pace dintre ruși și americani, însă e bine să fiți avertizați ca să nu vă mirați cînd veți auzi din nou această teorie.
Să vedem acum ce scriu concret despre acest subiect ziariștii de la revista americană de politică externă: „Commonwealth-ul polono-lituanian avea să devină una dintre cele mai mari țări din Europa și un laborator fascinant de guvernare politică, studiat în detaliu de părinții fondatori ai Statelor Unite, în special în Federalist Papers. După sfîrșitul dinastiei Jageloniene, s-a transformat într-o monarhie electorală, asemănătoare orașelor-stat din Italia, dar funcționînd la o scară mult mai mare. Legislația comunității și dietele locale au urmat principiul
(urmare din pag. 21)
Cunoscuta publicație americană Foreign Policy a analizat cîteva discursuri ale președintelui Xi Jinping și a concluzionat că acesta pregătește deja invazia Taiwan-ului sau, în orice caz, confruntarea militară. Hai să vedem ce anume le-a stîrnit îngrijorarea jurnaliștilor americani. Citez: „Liderul chinez Xi Jinping spune că se pregătește de război. La reuniunea anuală a parlamentului Chinei și a organului său consultativ politic superior din martie, Xi a țesut tema pregătirii pentru război prin intermediul a patru discursuri separate, spunîndu-le generalilor săi «să îndrăznească să lupte». Guvernul său a anunțat, de asemenea, o creștere cu 7,2% a bugetului de apărare al Chinei, care s-a dublat în ultimul deceniu, precum și planuri de a face țara mai puțin dependentă de importurile de cereale străine. Și în ultimele luni, Beijingul a dezvăluit noi legi privind pregătirea militară, noi adăposturi antiaeriene în orașele de peste strîmtoarea din Taiwan și noi birouri pentru «Mobilizarea Apărării Naționale» în toată țara. Este prea devreme să spunem cu certitudine ce înseamnă aceste evoluții. Conflictul nu este sigur și nici iminent. Dar s-a schimbat ceva la Beijing, un fapt pe care factorii de decizie și liderii de afaceri din întreaga lume nu își pot permite să îl ignore. Dacă Xi spune că se pregătește de război, ar fi o prostie să nu-l crezi pe cuvînt”.
Acesta este planul general, rezumatul articolului. Să vedem acum ce a spus liderul chinez în fiecare din cele patru discursuri. Citez din aceeași revistă americană. Astfel, în primul discurs, din data de 6 martie, Xi a avertizat că: „în perioada următoare, riscurile și provocările cu care ne confruntăm vor crește și vor deveni mai severe. Numai atunci cînd toți oamenii gîndesc într-un singur loc, muncesc din greu într-un loc, se ajută unul pe altul în aceeași barcă, se unesc ca unul, îndrăznesc să lupte și sînt buni la luptă, pot continua să cîștige victorii noi și mai mari. Pentru a ajuta PCC să obțină aceste victorii mai mari, el a promis că va îndruma corect întreprinderile private să investească în proiecte pe care statul le-a prioritizat. Xi a criticat, de asemenea, Statele Unite direct în discursul său, încălcînd practica de a nu numi Washington ca adversar decît în contexte istorice. El a descris Statele Unite și aliații săi drept principalele cauze ale
unanimității – spre deosebire de Consiliul European în multe probleme de astăzi. Atmosfera de toleranță religioasă și libertate a comunității, de care se bucură nobilimea sa, a oferit un contrapunct puternic pentru monarhiile absolutiste din Europa de Vest – ca să nu mai vorbim de istoria tragică care a urmat dispariția comunității în 1795. (povestea cu toleranța religioasă o puteți aprofunda în seria de articole «Rădăcinile unui război», ca să vedeți cum a fost de fapt – n.m.). Argumentul pentru o uniune politică explicită între cele două țări nu se bazează pe nostalgie, ci pe interese comune. Cu siguranță, datorită a patru secole de istorie comună în cadrul Commonwealth-ului polonolituanian, o mare parte din Ucraina de astăzi (și Belarus) împărtășește mult mai mult din trecutul său cu Polonia decît cu Rusia.
Cu toate acestea, să ne raportăm la prezent și să ne gîndim la viitorul apropiat. Ambele țări se confruntă cu o amenințare din partea Rusiei. Astăzi, Polonia este un membru a UE și NATO, în timp ce Ucraina este dornică să se alăture ambelor organizații. Chiar dacă războiul Ucrainei împotriva Rusiei se încheie cu o victorie decisivă a Ucrainei, alungînd forțele ruse din țară, Kievul se va confrunta cu o luptă de decenii pentru a adera la UE, ca să nu mai vorbim de obținerea de garanții de securitate credibile din partea Statelor Unite.
Țările prost guvernate, instabile din Balcanii de Vest, predispuse la interferența Rusiei și Chinei, oferă un avertisment despre unde ar putea duce «statutul
problemelor actuale ale Chinei. «Țările vestice conduse de Statele Unite au implementat izolarea din toate direcțiile, încercuirea noastră, ceea ce a adus provocări severe, fără precedent, pentru dezvoltarea țării noastre», a spus el”.
Xi a ținut un al doilea discurs în care a spus că marșul Chinei către modernizare este condiționat de ruperea dependenței tehnologice de economiile străine –adică Statele Unite și alte democrații industrializate. Xi a mai spus că dorește ca China să înceteze dependența de importurile de cereale și produse manufacturate.
În al treilea său discurs, adresat reprezentanților PLA și ai Poliției Armate Populare, Xi a declarat că „China trebuie să își concentreze eforturile de inovare pe consolidarea apărării naționale și să stabilească o rețea de forțe naționale de rezervă care ar putea fi folosită în timp de război. De asemenea, a cerut o campanie de «Educație pentru Apărare Națională» pentru a uni societatea în spatele PLA, invocînd ca inspirație Mișcarea Dublu Sprijin, o campanie din 1943 a comuniștilor de militarizare a societății în zona lor de bază din Yan’an”. În al patrulea său discurs (și primul său ca președinte pentru al treilea mandat), pe 13 martie, Xi a anunțat că „esența marii sale campanii de întinerire a fost unificarea patriei mame. Deși a făcut aluzie la legătura dintre absorbția Taiwanului și campania sa mult lăudată pentru a face China din nou grozavă, rareori a făcut acest lucru cu atîta claritate. Un lucru care este clar la un deceniu de conducere a lui Xi, este că e important să-l luăm în serios – lucru pe care, din păcate, mulți analiști americani nu îl fac”.
Observăm că președintele chinez dorește independența Chinei de produsele americane și occidentale, așa cum americanii doresc ca statele UE să nu mai fie dependente de resursele petroliere ruse. E ceea ce faci atunci cînd te pregătești de un război de lungă durată cu inamicul. Carevasăzică, cele două state organizate în două blocuri se pregătesc de confruntare și tare îmi e teamă că vor cîștiga perifericii chinezi; cînd îi numesc „periferici” nu o fac în sens peiorativ, ci fiindcă se află la marginea culturii occidentale.
Spun că va fi o confruntare între China și civilizația occidentală poate chiar una militară prin interpuși, dar e pregătită America să-i facă față? Conform generalului David Berger, comandantul Corpului Marin al SUA, intervievat de Newsweek, „Republica Populară Chineză este singurul concurent capabil să-și combine puterea economică, diplomatică și tehnologică pentru a contesta
de candidat» prelungit și indecizia europeană. O națiune ucraineană militarizată, și poate afectată de o încheiere nesatisfăcătoare a războiului cu Rusia, ar putea deveni cu ușurință o răspundere pentru Occident. Imaginați-vă, în schimb, că, la sfîrșitul războiului, Polonia și Ucraina formează un stat federal sau confederal comun, unind politicile lor externe și de apărare și aducînd Ucraina în UE și NATO aproape instantaneu. Uniunea Polono-Ucraineană ar deveni a doua țară ca mărime din UE și, probabil, cea mai mare putere militară a sa, oferind mai mult decît o contrapondere adecvată tandemului franco-german –ceva ce Uniunii Europene îi lipsește foarte mult după Brexit. (...) Aici intervine conducerea SUA. Avînd în vedere investiția deja făcută în succesul Ucrainei pe cîmpul de luptă, care depășește cu mult contribuțiile vest-europene, americanii au un interes puternic să transforme Ucraina într-o poveste de succes. Avînd în vedere nepăsarea vechii Europe, ilustrată de nenorocirile UE din Balcani, viitorul Ucrainei este prea important pentru a fi lăsat în mîinile Bruxellesului, Parisului și Berlinului. Dacă Varșovia și Kiev ar dori să intensifice și să rezolve problema Europei de Est odată pentru totdeauna, administrația SUA trebuie să aibă ajutorul Poloniei și Ucrainei”. Ați înțeles: SUA dorește să își subordoneze Europa prin orice mijloace, chiar retrasînd granițele după cum îi convine ei și coborînd Franța și Anglia la nivel de simpli servanți. Dacă va fi așa, sau nu, vom vedea. Cert este că scriitorul și fostul contraspion militar Pavel Coruț avea dreptate cînd spunea: „Trăim într-o vreme grozavă, din care o lume o să-nceapă”!
sistemul internațional stabil și deschis de care ne bucurăm”.
Atunci cînd un astfel de om aflat în exercițiul funcțiunii spune asta consider că situația e foarte nasoală pentru ei. Generalul se referă și la capacitatea armatei pe care o conduce de a-și îndeplini misiunile de luptă în condițiile în care „navele însărcinate cu transportul forțelor de sprijin la sol, cum ar fi Unitățile de expediție marină (MEU) și vehiculele acestora dincolo de mare pînă la uscat (rol crucial în contextul Pacificului, fiindcă debarcă trupele și tehnica militară de pe vapoare pe mal), au o stare de pregătire la cel mai scăzut nivel din ultimii ani, pînă la 35% din ceea ce era necesar pentru a pregăti trei grupuri amfibii. Acest lucru s-ar putea dovedi a fi un regres substanțial în cazul în care cele mai puternice două națiuni ale lumii s-ar război între ele, pe fondul tensiunilor în creștere din Pacific, unde China a acumulat o prezență militară semnificativă. Deja capabile să mobilizeze cea mai mare armată din lume, forțele navale chineze au început să reducă rapid decalajul cu cele ale SUA, chiar eclipsîndu-le în unele categorii cheie. Printre aceste categorii se numără o industrie de construcții navale care nu este egalată de nici o altă putere din lume și include o flotă amfibie în expansiune. Armata Populară de Eliberare a expus în mod regulat astfel de ambarcațiuni în exerciții care demonstrează capacitatea forțelor armate chineze de a proiecta puterea în insulele din apropiere, inclusiv în Taiwanul contestat politic. Numai în ultima lună, unitățile Armatei de Eliberare a Poporului, Comandamentul Teatrului de Est și Comandamentul Teatrului de Sud, au efectuat astfel de exerciții amfibii, cu participarea Forțelor Terestre PLA, Marinei, Forțelor Aeriene și Marinei. Forța de rachete PLA se antrenează frecvent în a distruge activele inamice pe mare, Pentagonul constatînd în raportul său anual din noiembrie anul trecut că China a efectuat mai multe lansări de rachete în 2021 decît orice altă țară aflată în afara zonelor de război reale”.
Cele spuse de generalul american mi se par corecte, mai ales că am mai citit astfel de analize. După cum observați, lucrurile se schimbă pe planetă și încă repede, dar trebuie să fim liniștiți, fiindcă de data asta sîntem în tabăra celor buni și corecți, care vor învinge.
P.S.: Vă amintiți cînd am fost ultima dată în tabăra învingătoare și cum am ajuns acolo?
Carnea va dispărea în curînd de pe rafturile din întreaga lume (II) – cu ce o vom înlocui și cine beneficiază de „înțărcarea” oamenilor de la carnea de vită și de porc? –
Millennials au inventat mîncarea artificială (2)
La sfîrșitul anului 2021, Patrick Brown a remarcat că plasarea „va avea loc la un moment dat, dar nu există o dată anume în viitor”. După unele estimări, cota sa pe piața cărnii artificiale din SUA în primăvara anului 2021 a fost de aproximativ 4% – de șase ori mai puțin decît Beyond Meat.
Produsele au fost populare nu numai printre vegetarieni, iar mulți cumpărători omnivori în fața inflației vizibile au început să opteze pentru carne reală mai puțin costisitoare. În SUA, produsele Beyond Meat, la jumătatea anului 2022, costau aproape de două ori mai mult decît carnea de vită obișnuită: pentru o liră de „non-carne” trebuia să plătești 8,35 dolari față de 4,90 dolari pentru carnea tocată obișnuită. În plus, industria s-a confruntat cu o problemă de percepție: sondajele au arătat că unii consumatori au început să creadă mai puțin că produsele pe bază de plante sînt mai bune pentru organismul lor și pentru mediu. Impossible Foods a susținut însă că, spre deosebire de restul pieței, ei au prosperat în această perioadă.
Și în jurul Beyond Meats, ai cărui burgeri au început să dispară din sortimentul McDonaldʼs american după perioada de probă, între timp, se pregătea un scandal. În noiembrie 2022, Bloomberg a scris că firma are probleme cu mucegaiul și bacteriile periculoase în producția sa.
Impossible Foods, spre deosebire de concurentul său, nu a intrat în scandaluri la scară largă și chiar a raportat o creștere record a vînzărilor în magazinele din SUA în 2022 (mai mult de 50% în termeni monetari).
Interesul cumpărătorilor în ansamblu a început să scadă, „euforia” a început să dispară. Pînă în 2023, sectorul a reușit să ocupe doar aproximativ 1% din piața cărnii. Trendul ar fi putut fi ajutat foarte mult de massmedia, care au fost la fel de dispuse să scrie despre dezamăgirea din sector. La mijlocul lunii ianuarie, Bloomberg a publicat un articol lung despre soarta industriei. Mulți consumatori de carne au început să se întrebe dacă au consumat burgeri din carne artificială pentru a reduce amprenta de carbon sau pentru scăderea tensiunii arteriale, de exemplu. Au existat, de asemenea, dovezi că americanii era mai puțin probabil

Mîncare cu carne imprimată 3D
Adresa redacţiei revistei „România Mare“ se află în casa presei libere, corp c, camera 126, Sector 1, Bucureşti. Tel./fax: 031/425.16.43 redactie@revistaromaniamare.ro
să considere carnea artificială drept o „dietă sănătoasă”. Dr. Michael Greger, autorul cărții „Don’t Die”, a declarat publicației că carnea artificială este o idee mai bună decît un burger de tip fast-food, dar asta nu îl face mai sănătos. „Nimeni nu ar trebui să își facă iluzii că vorbim despre mîncare sănătoasă”, a spus el.
Finalul articolului a fost o reamintire a faptului că în lume încep să apară companii care sînt gata să ofere o nouă alternativă la carnea tradițională – carne de vită în eprubetă și pui crescuți în bioreactoare datorită celulelor animalelor vii. Un sector care necesită investiții uriașe și abia începe să se dezvolte.
Pînă acum, vînzările cu amănuntul ale unor astfel de produse au fost aprobate într-o singură țară din lume –Singapore, dar, cu toate acestea, se pare că în curînd ne putem aștepta la un aviz al autorităților de reglementare din Statele Unite. În noiembrie, FDA a declarat că pieptul de pui crescut de UPSIDE Foods din California este potrivit pentru consumul uman. „Carnea este cultivată și procesată într-o încăpere pe care șefa companiei, Uma Valeti, o numește «casa fără abator». Reporterilor li s-a servit o mostră de pui de la UPSIDE în timpul vizitei. Avea gust de pui gătit obișnuit, deși puțin mai subțire și avea o nuanță și mai închisă”, se arată într-un articol recent publicat de Reuters. Scara producției, totuși, din cauza diferitelor dificultăți tehnice, rămîne foarte, foarte mică.
Capacitatea UPSIDE îi permite să producă nu mai mult de 200 de tone de produse pe an, ceea ce este neglijabil în comparație, de exemplu, cu 48 de milioane de tone de carne și pasăre produse în Statele Unite în 2021. Dezvoltarea necesită mulți bani. La nivel global, sectorul a atras deja aproximativ 2 miliarde de dolari în investiții, dar chiar și o singură companie poate avea nevoie de sute de milioane pentru echipamente. În plus, rămîne problema atragerii consumatorilor care vor trebui totuși să fie convinși să înceapă să mănînce carne cultivată în laborator. Un argument esențial poate fi că nu este necesar să ucizi animalele de dragul unui cotlet. Ca și în cazul cărnii vegetale, pot fi invocate și problemele de mediu: emisiile din laborator ar trebui să fie mult mai mici decît emisiile colosale din creșterea tradițională a animalelor. „Poate cel mai important lucru pe care l-am aflat este că oamenilor le place foarte mult carnea. Probabil că nu vor reduce prea mult consumul”, a spus Josh Tetrick, co-fondatorul GOOD Meat Labs, una dintre companiile producătoare de carne. Producătorii vor trebui să explice clar cum se face carnea lor și de ce
este sigură, spune Tetrik, a cărui companie a semnat deja contracte cu restaurantele din Singapore.
Pînă acum, însă, se pare că pot exista probleme în ceea ce privește aspectul. Carnea crescută în laborator începe să fie comparată cu tumorile canceroase, deoarece, în mod normal, celulele nu se împart la infinit. Pentru a rezolva problema, unele companii folosesc așa-numitele „celule nemuritoare” – acestea sînt obținute fie prin modificare genetică, fie prin realizarea de mutații în alt mod. Drept urmare, astfel de celule dobîndesc capacitatea de a se diviza la nesfîrșit, ceea ce face posibilă compararea lor cu celulele canceroase. „Dacă celula este nemuritoare, asta înseamnă că putem vorbi deja despre una dintre condițiile prealabile pentru dezvoltarea cancerului”, explică biologul Robert Weinberg, specialist în cercetarea oncologică.
Dar nu există nici o dovadă conform căreia consumul de carne artificială va provoca dezvoltarea cancerului în rîndul consumatorilor. Sistemul digestiv uman îi poate permite individului să mănînce sistematic „tumori maligne” de pui pur și simplu digerîndu-le. Cu toate acestea, „cancer” este un cuvînt înfricoșător, iar industria va trebui să muncească din greu pentru a convinge publicul să nu-și facă griji.
Într-un fel sau altul, dificultățile producătorilor de carne vegetală sau de laborator nu anulează în nici un caz urgența problemelor care au determinat dezvoltarea ambelor sectoare în ultimii ani. Creșterea tradițională a animalelor, așa cum insistă oamenii de știință, dăunează de fapt mediului și climei – din cauza emisiilor enorme de gaze cu efect de seră, a necesității de a tăia pădurile pentru pășuni și a utiliza în mod activ resursele de apă. În același timp, populația Planetei este în continuă creștere, ceea ce nu face decît să agraveze dificultățile în asigurarea securității alimentare. În același timp, oamenii de știință au început să aducă în discuție faptul că, poate, nu ar fi necesară nici o alternativă la carne – dacă ne referim la consumul de insecte. Acestea ar fi extrem de hrănitoare, iar producția este profitabilă și nu dăunează prea mult mediului. Folosirea gîndacilor, greierilor ca ingredient alimentar a fost discutată din ce în ce mai activ în ultimii ani și chiar și guvernul rus a sugerat deja consumul. Este posibil ca, în cele din urmă, locul cărnii de vită în mintea și stomacul omenirii să fie luat de insecte și nu de chiftele de soia sau de puii de laborator. O soluție trebuie găsită într-un fel sau altul –dacă nu vrem să ajungem într-o distopie asemănătoare cu „Soylent Green”. Sfîrșit N.K.
Abonamentele la Revista ,,România Mare” se pot face prin intermediul Poștei Române, astfel:
- la Oficiul poștal de care aparțineți (abonamentele se înnoiesc lunar);
- pe site-ul www.posta-romana.ro, secțiunea Abonamente presă.
Costul unui abonament variază, după cum urmează:
– 1 lună – 24 RON
– 3 luni – 72 RON
– 6 luni – 144 RON
– 12 luni – 288 RON
Codul de identificare în catalogul Poștei Române este 19.360.
Vă mulțumim!

Important: Potrivit art. 206 CP, responsabilitatea juridică pentru conţinutul articolului aparţine autorului. De asemenea, în cazul unor agenţii de presă şi personalităţi citate, responsabilitatea juridică le aparţine. Difuzată prin pRESS book conSulTIng SRl. E-mail: pressbookconsulting@yahoo.ro.
Abonamente prin: Sc MAnpRES dISTRIbuTIon SRl., tel. 021/312.48.01; fax 021/314.63.39 şi POŞTA ROMÂNĂ. codul ISSn 1220 – 7616.
